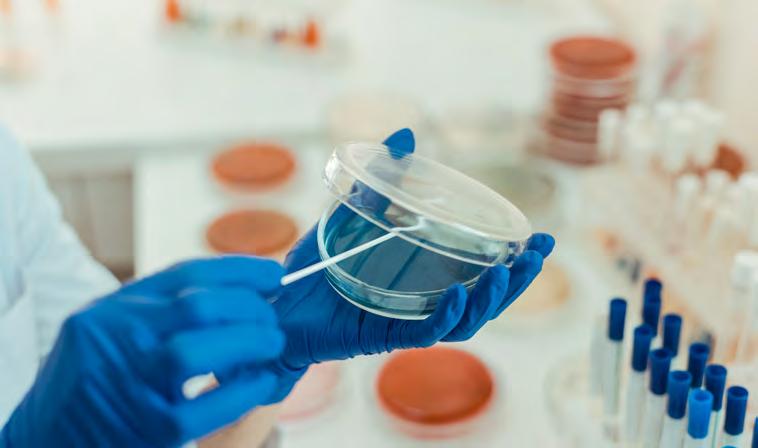

Trinity College Dublin Child Health Research Excellence Report 2023
Welcome to the Child Health Research Excellence Report 2023 - Trinity College Dublin
• Professor Eleanor Molloy, Professor of Paediatrics & Child Health, Paediatrics
Overview of Child Health Research in Ireland
Overview of Child Health Research in Trinity College Dublin
Child Health Research Vision & Principles
Key Child Health Research Strengths in Trinity College Dublin
From the laboratory to the bedside
Scale of Child Health Research at Trinity College Dublin 2023
Child Health Research Impact Highlights 2023
• Key Impacts in Generation of knowledge
• Key Impacts in Capacity Building
• Key Societal Impacts
Academic Paediatric Research Hubs of Excellence
Neonatal & Children’s Brain Consortium Ireland (NBCI)
HRB Neonatal Encephalopathy PhD Training Network (NEPTuNE)
The Children´s Research Laboratory
Trinity Research in Childhood Centre (TRiCC)
• Professor Imelda Coyne, TRiCC Director
• Professor Trevor Spratt, TRiCC Co-Director
• Professor Eleanor Molloy, TRiCC Co-Director
HRB Irish Network for Children’s Clinical Trials – In4kids
• Prof Geraldine Boylan, Professor of Neonatal Physiology at University College Cork, Lead of in4kids, Director of the INFANT research centre
• Prof Eleanor Molloy, Professor and Chair of Paediatrics, Trinity College Dublin, Co – Lead of in4kids, Consultant Neonatologist & Paediatrician
2
Introduction . Contents 5 6 8 9 10 11 12 13 17 18 19 20 21 22
Contents
Trinity College Institute of Neuroscience (TCIN)
• Professor Rhodri Cusack, Director of TCIN, Trinity Inst. of Neurosciences (TCIN)
Trinity Biomedical Sciences Institute (TBSI)
• Professor Kingston Mills, Academic Director, Trinity Biomedical Sciences Institute
Trinity Translational Medicine Institute (TTMI)
• Professor Aideen Long, Director, Trinity Translational Medicine Institute (TTMI)
Wellcome-HRB Clinical Research Facility
• Professor Martina Hennessy, Clinical Director, Wellcome Clinical Research Facility, St James Hospital
Child Health Research Strengths by Broad Theme
• Cancer
• Clinical Research
• Child & Family Population Health
• Immunology & Infection
• Neuroscience & Mental Health
• Doctoral Research
Paediatric Research for undergraduate students
• Prof. Eleanor Molloy and Dr Judith Meehan, Department of Paediatrics
3
Child Health Research Funding Sponsor Acknowledgement Introduction . Contents 23 24 25 27 29 41 55 91 117 151 162 163

We aim to advance novel and impactful research and implementation to improve children health with our international collaborators.”
Welcome to the Child Health Research Excellence Report 2023 - Trinity College Dublin
The report offers a comprehensive overview of our areas of research expertise in cancer, genomics, immunology, infectious disease, neurology, neonatology, dermatology, mental health, and child health policy. This report aims to showcase child health research in Trinity to foster further collaboration and awareness of important issues in child health both within the university but also to the international community of families and researchers. In Trinity College Dublin we aim to ensure interdisciplinary integration and promote research in all aspects of childhood and children’s biological, psychological, cognitive and socio-emotional development and well-being.
We aim to advance novel and impactful research and implementation to improve child health with our international collaborators. For example, the Trinity Research in Childhood Centre (TRiCC), founded in 2017 is a focus for children’s research across all schools and disciplines and has allowed the development of innovative interdisciplinary childhood research. Interventions in childhood have a huge impact not just in the early years but throughout life. Therefore we can harness the expertise in the university institutes and schools to advocate for children. We are privileged to work with children and their families to create innovative and transformative research.

5
May 2023
Introduction . Welcome to the Child Health Research Excellence Report 2023 - Trinity College Dublin . Professor Eleanor Molloy
“
Professor Eleanor Molloy, Professor of Paediatrics & Child Health, School of Medicine, Trinity College Dublin
Overview of Child Health Research in Ireland
In 2021, according to Eurostat, Ireland had the highest estimated proportion of children in the European Union (23.9%) compared to the EU-27 of 18.2%. Despite the fact that children account for almost 1 in 4 of the population, specialist paediatric healthcare is centralised in a small number of hospitals. Research funding for child health is also proportionally less than research funding directed towards adults. As a direct result of this under investment in child health research, there is a relative paucity of senior researchers and representation on funding bodies for child health.
“A Future for the World’s Children?” is the first comprehensive, independent report to reposition every aspect of child health through the lens of our rapidly changing climate and other existential threats. The 2020 document, commissioned by the WHO-UNICEF-Lancet Commission, concluded that resources for children’s health care and research do not reflect the size and needs of the paediatric population.
The building of the New Children’s Hospital however does reflect an increased emphasis on Child Health Research and optimism for the future, in the Irish context. The Growing Up In Ireland survey also offers a positive outlook for the future health and well-being of our youth. The survey, which started in 2006 and follows two cohorts of children aged 9 years, has found that Irish children have become healthier, friendlier and more resilient, despite the economic crash.
The importance of concentrating on childhood interventions to prevent adult disease is well-recognised. Offering interventions to mitigate the effects of Adverse Childhood Events (ACEs) and unhealthy diet and lifestyle are vital. Ending child poverty would massively alleviate the health issues and disparities.
Challenges facing child health research in Ireland include funding, availability of research nurses and protected academic time. Children have distinct physiological, developmental, and psychological characteristics and deserve and must have the same access to high quality, evidence-based health care as adults. In4kids is a national paediatric clinical research network funded by Health Research Board (HRB). In4Kids is developing the national capacity for high-quality, ethical paediatric clinical research. In addition, as the national hub for the pan-European project – Conect4Children (c4c), In4kids will consolidate our existing infrastructure and ensure we maintain our place at the international forefront of children’s clinical research.
There is enormous potential to build on our excellent academic reputation and grow our research outputs in child health research. Apart from having a large population of children, we benefit from a high proportion of University graduates with the capacity to sustain our long term capability as a world leader in scientific research. Enhancing our capacity to produce high impact child health research is the increasing involvement of the public and patients in the co-design of research. Public Patient Involvement (PPI), is now firmly embedded in paediatric research programmes, making Child health research more relevant to the needs of children and families.
6 Introduction . Overview of Child Health Research in Ireland
“
Ireland has one of the largest proportions of young people among the EU Member States.”

Overview of Child Health Research in Trinity College
Dublin
Collaboration, integration, and translation in research are the three principles that will support the development of our vision. The strategic actions we propose to make our vision a reality include supporting the (1) National Children’s Hospital, (2) establishing Child research as a research theme in Trinity College Dublin, and (3) expanding our public engagement.
Research is at the core of Trinity’s identity and informs our teaching. It also contributes to our national and international recognition. Researchers at our institution strongly believe in making significant contributions to knowledge that will have a deep impact upon humanity and the world.

The vision of Child Health Research in Trinity is to “advance excellence in Child Health Research for the promotion of better health and well-being outcomes for children and families across Ireland and internationally.”
Child Health Research seeks to contribute to “A Living Research Excellence Strategy” policy document articulated by the Dean of Research, by engaging all staff and students in dynamic conversations and by providing a strong framework to build the research for the future.
8
Introduction . Overview of Child Health Research in Trinity College Dublin
“
Trinity strives for research excellence and seeks to promotes better health and wellbeing outcomes for children and families.”
Child Health Research Vision and Principles
Vision
Excellence in Child Health Research for the promotion of better health and well-being outcomes for children and families across Ireland and internationally.
Core Principles
Research Collaboration Research Translation


• Within Trinity and across children’s hospitals and communities
• Harnessing international collaborative strengths


• Working with children and families to promote lifelong health
• Into practice, policy and further research to enhance health outcomes


• Building on existing scientific research to create new therapies, medical procedures, and diagnostics.

Research Integration
• Into hospitals and communities, and across the university
• Targeting health inequalities in our society
Strategic Pillars

9
Trinity Research in Childhood Centre
Promoting
Child Research as Research Theme within Trinity College Dublin
Expanding Public Engagement Establishing
Introduction . Child Health Research Visions and Principles
Supporting National Children’s Hospital
“
Building on existing scientific research to create new therapies, medical procedures, and diagnostics.”
Key Child Health Research Strengths in Trinity College Dublin
Our impact on child health research from birth to teenage years and young adults is globally recognised across six key broad areas:

• Cancer Research
• Clinical Research
• Immunology and Infection
• Neuroscience and Mental Health
• Child and Family Population
• Doctoral Research
Our research seeks to identify and develop potential therapies for specific conditions, but most importantly, to work towards supporting families and clinicians to improve children’s health and better outcomes for a sustained quality of life.
10 Introduction . Key Child Health Research Strengths in Trinity College Dublin
FIGURE 1: Trinity College Dublin Child Health Research Strengths
“
Our impact on child health research from birth to teenage years and young adults is globally recognised.”
From the laboratory to the bedside
Child Health Research at Trinity College combines the research expertise from molecular and cellular level, up to patients care, family support and Irish policy shaping. Collaboration between several groups brings the knowledge of animal and statistical models, advances in clinical diagnosis and access to patients’ clinical history and samples together to better understand the biological basis of health and disease. This data will later inform the design of clinical trials to test potential courses of therapy, involving active molecules, vaccines, or combined treatments.
A strong area of interest is the support to patients and their families. Through centers, networks and consortiums like Trinity Centre for CAYA Cancer Survivorship Research, NationaI Children’s Cancer Service (NCCS), The Wellcome-HRB Clinical Research Facility, in4kids, The National Centre for Paediatric Rheumatology (NCPR), Neonatal and Children’s Brain Consortium Ireland (NBCI), Growing up in Ireland and many others, the researchers in our institution truly live up to fulfilling our vision, to promote better health and well-being outcomes for children and families across Ireland.

11 Introduction . From the laboratory to the bedside
FIGURE 2: Paediatric Research Spanning bench to bedside
“
Promoting better health and wellbeing outcomes for children and families across Ireland.”
Scale of Child Health Research at Trinity College Dublin 2023
Child health research activities at Trinity College Dublin are characterised by a complex and dynamic web of collaborations with research institutes, research centres, national research consortia and networks, other Trinity schools, and hospital and health service partners.

We are a research-led school that values cutting-edge innovation, leverages local, national and international collaboration, and is focused on improving human health and healthcare. Over fifty percent of senior principal investigators are clinical academics based at

Children’s Health Ireland and other clinical partner sites combining their clinical commitments with their academic activities.
Child health research activity at Trinity College Dublin encompasses the research specialities of over 80 Principal Investigators who are embedded across 11 schools with the three academic faculties of Arts & Humanities, Health Science and Engineering, Maths and Science all represented in child health research outputs and impact.
12
Introduction . Scale of Child Health Research at Trinity College Dublin 2023
FIGURE 3: Complex Collaborative Academic & Clinical Research Network
Child Health Research Impact Highlights 2023


Research Capacity & Success
> 80 > 118
Principal Investigators
Over 80 Principal Investigators specializing in child health research across 11 schools in 3 faculties of Arts, Humanities and Social Sciences; Engineering, Mathematics and Science and Health Sciences.


> €21 m

Active research projects

Our Principal Investigators are engaged in 118 active research projects across the full spectrum of research from pre-clinical animal studies, Translational studies, clinical trials, implementation research and health services research.
> 134
Current Research Income Doctoral students supervised to
Our Principal Investigators currently preside over €21 million Child Health research income raised through competitive funding calls across a diverse range of exchequer and non-exchequer funding sources.
> 63
Active
Doctoral Projects
Doctoral students under active supervision in 2023 and undertaking doctoral research projects directly related to child health in the broad themes of Cancer, Neuroscience, Mental Health, Immunology and Infection and Child and Family Health.
completion
Doctoral students supervised to completion with Doctoral Theses directly related to child health in the broad themes of Cancer, Neuroscience, Mental Health, Immunology and Infection and Child and Family Health.
> 15
Undergraduate Excellence
10-15 of our undergraduate students completing the Paediatrics research module publish annually in peer reviewed journals and present at national and international scientific meetings.
13
Introduction . Child Health Research Impact Highlights 2023
Research Quality
~ 3,000
Peer Reviewed Publications

Our 80 + Principal Investigators have co-authored ~ 3,000 Peer Reviewed Publications, advancing the generation of scientific knowledge in child and adolescent health research.
45.8 %
% Publications in the top 10% journals
A significantly large proportion of child health research during 2017-2022 is published in influential or high impact journals, that have a reputation for publishing ground breaking research that can withstand a higher level of scrutiny.
2.21
Field weighted citation index (FWCI)





The excellence and impact of our child health research is reflected with outputs during 2017-2022 cited more than double the citations that would normally be expected, based on the world average for similar publications.

63.7 %
% International Collaboration
Child health research is underpinned by extensive international collaboration with almost two thirds of research publications 2017-2022 featuring one or more International co-authors.
~ 675
% Corporate Collaboration
6.0 % Child health research at Trinity reflects strong Academic-Corporate Collaboration to better address grand research challenges and facilitate commercialization of research outputs.
International Policy Impact

763
Global Influence
Child health research publications affiliated to Trinity College Dublin have garnered over 763 citations on International child and adolescent healthcare policy documents and clinical guidelines across 35 countries.
Patent Citations
Child health research publications authored by Trinity College Dublin have been cited on 675 patents to date – a strong indicator that our academic research excellence is leading to innovation and invention.
139
Academic Reputation
Our Child health research output has been cited by 139 entities including The UK National Health Service Trust, PubMed Central ,The National Institute for Health and Care Excellence (NICE), the World Health Organization, UNICEF, World Bank, UNESCO, The Organisation for Economic Co-operation and Development (OECD), and United Nations.
14 Introduction . Child Health Research Impact Highlights 2023
Growing up in Ireland Study
As co-lead on the longitudinal “Growing up in Ireland Study”, our research has provided a wealth of survey data and research findings to inform national policy under the three broad domains of health, education and socio-emotional well-being.
Healthcare Innovations
'First 5 Early Years'

Trinity College Dublin played a pivotal consultant role in “First 5” - the Irish Government’s ten-year strategy to help make sure all children have positive early experiences and get a great start in life, published in 2017.

Virtual Reality Apps
Personalised VR Dance Tutor with Progress Monitoring for Survivors of Childhood Cancer
Innovative solutions
TCD Sense - The Trinity Sensory Processing Project - supports students who experience barriers to managing and adapting the sensory environments of college.
Online resources
Queer(Y)ing Initial Teacher Education is a free online resource for ITE providers and schools to support LGBTIQ+ young people through the development of inclusive school culture and the promotion of inclusive practices.

Web based supports
Web based service with transition information for young people with long-term illnesses moving to adult care services.


Digital educational tools
InterAcT, Accomplish & Thrive supports for children with intellectual and developmental disabilities.
Game software

The weDRAW project is developing and validating prototypes for 3 games: one to learn arithmetic, one to learn geometry and the third one to learn together (social).

15 Introduction . Child Health Research Impact Highlights 2023
National Policy Impact

Academic Paediatric Research Hubs of Excellence
Child Health Research is enriched by its deep links with scientific hubs of interdisciplinary research excellence including Trinity Translational Medicine Institute, the Trinity Biomedical Sciences Institute, and the Trinity College Institute of Neurosciences, as well as large research and training programmes, such as
Neonatal & Children’s Brain Consortium Ireland (NBCI), The Children´s Research Laboratory, the HRB Irish Network for Children’s Clinical Trials – In4kids, and the Wellcome-HRB Clinical Research Facility at St James’s Hospital.

17
Introduction . Academic Paediatric Research Hubs of Excellence
FIGURE 4: Child Health Research Hubs of ExcellenceTrinity college Dublin
Neonatal & Children’s Brain Consortium Ireland (NBCI)
Ireland is at the forefront of research in neonatal brain and neonatal brain injury and has the collaborative potential to be an international leader in this area. To maximise this collaborative capacity and in an effort to encompass all research in neonatal brain injury, the Neonatal and Children’s Brain Consortium Ireland (NBCI) was established in 2018.
The consortium is led by Professor Eleanor Molloy, Professor of Paediatrics & Child Health, Paediatrics, School of Medicine, Trinity College Dublin and Professor Geraldine Boylan, Professor of Neurophysiology & Director of INFANT Centre, University College Cork. It brings together internationally recognised researchers from a variety of disciplines which includes expertise in neonatology, paediatrics, neurodevelopment, neuromonitoring, family-centred care, clinical trials and methodology, pharmacology, epidemiology, biostatistics, translational research, and neuroimaging.
The consortium’s long-term research objectives have been defined as follows:
• To develop multidisciplinary neonatal and children’s brain research
• To provide strategic advice and input to the development and implementation of guidelines for treatment
• To ensure and support family involvement (PPI) in neonatal and children’s brain research

Family involvement is a key component and emphasis in all the consortium’s research programmes and projects. This is demonstrated in the 2018 award of an HRB Collaborative Doctoral Award in Patient-
Focused Research for HRB Neonatal Encephalopathy PhD Training Network (HRB NEPTuNE) and in the emphasis on PPI in Professor Molloy’s Children’s Research Laboratory projects.
Consortium partners are based in Ireland’s major universities, hospitals and research centres. They include Professor Declan Devane, Professor of Midwifery, University of Galway, Director of Evidence Synthesis Ireland, Scientific Director of Cochrane Ireland and Scientific Director of the HRB-Trials Methodology Research Network, Professor Arun Bokde, School of Medicine, Trinity College Dublin, Dr Elizabeth Nixon, School of Psychology, Trinity College Dublin, and Mandy Daly, Director of Irish Neonatal Health Alliance, Professor Francis Northington, Department of Paediatrics, John Hopkins Hospital, and Dr John Murphy, National Maternity Hospital, Dublin.
Please see the section on HRB Neonatal Encephalopathy PhD Training Network to read about the NBCI’s recent HRB Collaborative Doctoral Award programme. Further details about this programme’s projects can be found in the Broad Theme sections of Neuroscience and Mental Health and Infection, Inflammation and Immunology.
18
Introduction
. Neonatal & Children’s Brain Consortium Ireland (NBCI) . Professor Eleanor Molloy . Professor Geraldine Boylan
Ireland is at the forefront of research in neonatal brain and neonatal brain injury.”
“
HRB Neonatal Encephalopathy PhD Training Network (NEPTuNE)
The HRB Neonatal Encephalopathy PhD Training Network (HRB NEPTuNE) is a collaborative structured PhD research programme led by Professor Eleanor Molloy (TCD) and co-lead Professor Geraldine Boylan (UCC). It is funded by the Health Research Board’s Collaborative Doctoral Award initiative. The Training Network is an active research programme that falls within the remit of the Neonatal and Children’s Brain Consortium Ireland (NBCI).
HRB NEPTuNE will deliver a multidisciplinary training programme for research into and clinical care of Neonatal Brain injury. Seven PhD scholars with backgrounds in the disciplines of paediatrics, neurodevelopment, neuromonitoring, and neuroimaging will participate in projects related to Neonatal Encephalopathy (NE). The projects will aim to harmonise clinical management of NE, optimise Neuromonitoring and Neuroimaging in NE, further develop Neurodevelopmental followup and evaluate interventions to improve outcomes in babies with NE. The training programme will advance scholar’s knowledge of Neonatal Encephalopathy through original research while also providing support for professional development.
Our seven scholars are based at the programme’s NBCI partner sites Trinity College Dublin, the INFANT Research Centre, UCC, the University of Galway.
While each of the seven projects has its own set of scientific deliverables, our PhD scholars will also feed into an overall programme deliverable which is to develop Family-Centred Care and Multidisciplinary Research Strategies in Neonatal Brain Injury. The inclusion of PPI (Public Patient Involvement) expertise from collaborator Mandy Daly of the Irish Neonatal Health Alliance is a key focus of the programme and each project has a dedicated PPI resource to advise on all aspects of the research lifecycle.


The programme’s qualification will enhance, improve and directly engage the scholar in relevant research skills. It will also offer scholars disciplinary, generic and transferable skills, tailored to suit the experience of the scholar and to reflect the disciplinary requirements.
HRB NEPTuNE will run until May 2024.
Please see the following broad theme sections for detail on our seven projects: Neuroscience & Mental Health, Inflammation & Immunology.
19
All research in the HRB NEPTuNE programme will lead to improved outcomes for children with Neonatal Encephalopathy.”
Introduction . HRB Neonatal Encephalopathy PhD Training Network (NEPTuNE) . Professor Eleanor Molloy . Professor Geraldine Boylan
Professor Eleanor Molloy, Professor of Paediatrics & Child Health, Trinity College Dublin
“
Professor Geraldine Boylan, Professor of Neonatal Physiology, University College Cork
The Children´s Research Laboratory
The Children’s Research laboratory was established in 2016 by Prof. Eleanor Molloy and since then has contributed to a large body of research in neonatal inflammation and inflammatory conditions in children. It has also trained several Clinical PhDs of neonatology and paediatrics. The research in the group focuses in three main cohorts of study:

• Neonate encephalopathy: Neonatal brain injury is an important cause of neonatal death, and it has been implicated in adult neuropsychiatric conditions. Inflammation is an important factor in brain injury and multi-organ dysfunction of new-borns. A better understanding of inflammation at neonatal stage and in childhood would help to decrease the negative effects of inflammation in these infants and improve outcomes for them and their families.
• Preterm infants are at risk of multiorgan failure, neurodevelopmental affectations, and death, due to multiple dysregulated systems in their bodies, including their inflammatory responses. They commonly have a poor response to sepsis and necrotising colitis, associated to neurodevelopmental delays and long-term outcomes. Understanding the mechanism of persistent inflammation and the effect on their development would facilitate finding targets for immunomodulatory therapies and biomarkers to predict outcomes.
• Down Syndrome Research Group: The Down Syndrome Research Group - brings together expertise from a variety of disciplines and organisations including paediatrics, neurodevelopment, Down Syndrome Ireland, and PPI.
The primary aim of the group is to progress research that will provide improved outcomes for children who have been diagnosed with Down Syndrome.
The group has also worked on traumatic brain injury (TBI), specifically post-concussion syndrome (PCS), elucidating its association to persistent inflammation, and on a project looking to understand multisystem inflammatory condition in children and adolescents (MIS-C) associated to previous infection with SARSCoV-2 virus.
The Children’s Research laboratory is physically located in Trinity Centre for Health Sciences, St. James Hospital, and its associated multiple hospitals, including Tallaght University Hospital, Coombe Women's Hospital and National Children’s Research Centre, Our Lady’s Children’s Hospital Crumlin.
The Children’s Research laboratory aims to contribute to research that will help in the development and implementation of guidelines to inform health care workers and families on the best course of care for the babies and children.
20
Introduction . The Children´s Research Laboratory . Professor Eleanor Molloy
Professor Eleanor Molloy, Professor of Paediatrics & Child Health, Trinity College Dublin
“
The Children’s Research laboratory is physically located in Trinity Centre for Health Sciences, St. James Hospital, and its associated multiple hospitals.”
Trinity Research in Childhood Centre (TRiCC)


The Trinity Research in Childhood Centre (TRiCC), is an interdisciplinary initiative to integrate and promote research in Trinity College Dublin in all aspects of childhood and children’s biological, psychological, cognitive and socio-emotional development and well-being. The centre comprises over 100 researchers in Childhood across all faculties and disciplines in Trinity College Dublin.
Founded in 2017, the aim of TRiCC is to support and advance ground breaking research in children and childhood across Trinity and globally. TRiCC researchers are engaged in world leading transformative projects in all aspects of children's lives. These are carried out in diverse settings ranging from the laboratory to the child's home. Individual scholarly work examining historical and contemporary aspects of children's lives sits alongside multidisciplinary studies designed to inform interventions to improve the health and welfare of children. Our work is marked by this collegiate approaches which blur traditional subject boundaries in our pursuit of answers to all embracing research questions.
Speaking about her pride in TRiCC researchers across TCD, Professor Imelda Coyne TRiCC Director, said “TRiCC provides a dynamic hub for researchers and students to come together, share ideas, collaborate, build alliances, and foster creativity and innovation.

As this brochure shows, the coming together of different disciplinary lenses serves to strengthen and contribute to high quality research on childhood across the university and allow for much richer nuanced understanding of issues affecting children in our world today”.
Professor Trevor Spratt, TRiCC Co-Director commented: “This is an exciting time in children’s research in Trinity College Dublin with new models of child development highlighting the interconnectedness of biological, psychological and social processes. We are beginning to understand better ‘why we are as we are’ together with the foundational influences of childhood experience for our whole life trajectory. At Trinity we are interested in better understanding these processes so as to inform more effective interventions to make the lives of children, and consequently the future adult population, better. It’s a privilege to be involved in this enterprise – working with expert colleagues across College – to create innovative and transformative research”.
Professor Eleanor Molloy, TRiCC Co-Director, commented: “I am delighted to have the opportunity to work together across the entire university campus. TRiCC connects researchers and students from diverse areas in order to improve the lives of children. Interventions in childhood have a huge impact not just in the early years but through out life. Therefore we can harness the expertise in Trinity College Dublin university institutes and schools and faculties to advocate for our children”.
21
Introduction . Trinity Research in Childhood
Centre (TRiCC) . Professor Imelda Coyne . Professor Trevor Spratt . Professor Eleanor Molloy
Professor Imelda Coyne, TRiCC Director
Professor Eleanor Molloy, TRICC Co- Director
The Trinity Research in Childhood Centre (TRiCC), is an interdisciplinary initiative to integrate and promote research in Trinity College Dublin.”
“
Professor Trevor Spratt, TRiCC Co-Director
HRB Irish Network for Children’s Clinical Trials – In4kids

The HRB Irish Network for Children’s Clinical Trials (In4kids) received funding in November 2021 for five years from the Health Research Board and fulfils a gap in the existing CTN landscape to focus solely on children. The network is led jointly by Professors Geraldine Boylan, Professor of Neonatal Physiology, Department of Paediatrics & Child Health, University College Cork and Professor Eleanor Molloy Professor and Chair of Paediatrics, Trinity College Dublin, with the support of leading Irish Paediatric Principal Investigators.
The pool of eligible children for trials is often small and clinical trials in children are more challenging than those in adults. Collaboration is crucial; therefore, In4Kids builds on existing collaborations and more than 20 years’ experience of clinical trials in the paediatric population.
The network supports researchers throughout Ireland to deliver high-quality clinical trials to benefit children’s health.
As the national hub for the pan-European project –Conect4Children (c4c), In4kids will consolidate Ireland’s existing infrastructure and ensure we maintain our place at the international forefront of children’s clinical research.
In4kids is available to support all paediatric clinical studies that take place in Ireland. Support varies depending on the needs of a study and /or site
Support includes:
• Feasibilities
• Training & Education
• Ethics and Regulatory preparation include document templates
• eCRF design and support
• Access to an Expert Group of leading neonatologists and paediatricians in Ireland

• Access to the conect4children project
• PPI Support
• Members only platform
• Quality & Monitoring Support
• Budget Advice
• Site Engagement and Recruitment support
• PPI support
Below is a snapshot of some of studies currently supported by the In4kids Project
TREOCAPA is a multicenter trial assessing the effectiveness of paracetamol on the closure of the patent ductus arteriosus in extremely premature babies (23-26 weeks’ gestation), as well as the increase in survival rate without severe morbidity in these babies (for babies born between 23-28 weeks). The study is Sponsored and coordinated by INSERM, a public research organization in Paris, France. This study is ongoing in the INFANT Centre, Cork University Hospital.
PROTECT is a large multicenter trial coordinated by the NHMRC Clinical Trials Centre in the University of Sydney. PROTECT seeks to evaluate if Pentoxifylline can improve long-term outcomes in preterm infants with late-onset sepsis or necrotizing enterocolitis? Recruitment to the PROTECT clinical will begin in the Coombe and Rotunda hospitals in the coming weeks.
EARLY DETECTION OF CEREBRAL PALSY IN IRELAND is a multicentred non-regulated interventional study in Ireland. This project will aim to improve the Early Detection of Cerebral Palsy in Ireland. This will be achieved by implementing an evidence-based approach to follow-up of High-risk infants. This approach has been previously demonstrated to reduce the age at which CP is diagnosed across a large neonatal network in North America. This stud will take place in Maternity Hospitals in Cork, Dublin and Limerick
22
Introduction . HRB Irish Network for Children’s Clinical
–
In4kids is working to ensure Ireland produces excellent clinical research to benefit all children by improving the quality and quantity of Children’s Clinical Trials.”
Trials
In4kids .
Professor Eleanor Molloy . Professor Geraldine Boylan
Professor Eleanor Molloy, Professor of Paediatrics & Child Health, Paediatrics
“
Professor Geraldine Boylan, Professor of Neonatal Physiology
Trinity College Institute of Neuroscience (TCIN)
Events in the brain that occur during development, from in utero through childhood and adolescence, shape thoughts, emotions, and behaviour in adulthood. Therefore, to better understand mental health difficulties and to improve treatments for mental health conditions, it is important to study the developing brain. The Trinity College Institute of Neuroscience binds together several research programmes connecting fundamental, clinical and translational studies of children’s brain health.

Intensive collaborative research focuses on the genetics, biology and mechanisms of childhood psychosis, autism, ADHD, depression and substance abuse. This includes work with developing human patient cohorts as well as translational efforts using animal and cellular models, and are led by a number of clinician scientists, including Louise Gallagher, Mary Cannon, Jane McGrath, Veronica O’Keane and Declan McLoughlin as well as cognitive neuroscientists and neurophysiologists, including Clare Kelly, Claire Gillan, Arun Bokde and Robert Whelan .
In TCIN, these programmes intersect with bottom up approaches driven by non-clinical PIs. For example, Rhodri Cusack’s group leads a major initiative using brain imaging and artificial intelligence to characterise the emergence of cognition, with strong clinical collaborations. Arun Bokde and Robert Whelan are principal investigators on a longitudinal neuroimaging study of development (IMAGEN) that is following a cohort of over 2,000 individuals from early adolescence.
Jane McGrath and Robert Whelan are establishing a longitudinal cohort of children (beginning at age 10) with a diagnosis of ADHD. The groups of Andrew Harkin, Shane O'Mara and Marina Lynch are analysing biochemical, cognitive and behavioural mechanisms and markers altered in depression, stress, and autism in collaboration with clinical PIs Veronica O’Keane & Declan McLoughlin and neuroimmunology PIs Kingston Mills & Colm Cunningham).
At an even more basic level, groups are analysing processes of direct relevance to children’s health. Mani Ramaswami’s group is analysing the mechanisms that form inhibitory masks for familiar stimuli and consolidated memories may be relevant to phenomena such as stimulus hypersensitivity, novelty aversion and intrusive memory sometime seem in autism and other psychiatric disorders. Tomas Ryan’s group manipulates memory engram cells during development, to separate and analyse memory storage and recall processes in mice, which has direct relevance to our understanding of the phenomenon of infantile amnesia.
More generally, TCIN houses broad expertise and interest in understanding, measuring and manipulating neural processes ranging from sensory perception and motor coordination, to arousal, attention and decision making (Fiona Newell, Redmond O’Connell, Paul Dockree, Sven Vanneste, Richard Reilly, Ed Lalor), with a particularly strong focus on childhood vision and blindness (Sarah Doyle, Jane Farrar)
23
Introduction . Trinity College Institute of Neuroscience (TCIN)
. Professor Rhodri Cusack
Professor Rhodri Cusack, Director of TCIN, Trinity Institute of Neurosciences (TCIN)
“
The Trinity College Institute of Neuroscience binds together several research programmes connecting fundamental, clinical and translational studies of children’s brain health.”
Trinity Biomedical Sciences Institute (TBSI)

The Trinity Biomedical Sciences Institute (TBSI) is the largest research Institute in TCD and recognized internationally as a leading institute for Biomedical research. TBSI is an environment where innovative and interdisciplinary approaches are leading to scientific discoveries of biomedical importance, ultimately giving rise to better care for patients, including pediatric patients.
TBSI has 29,000 m2 of research space and is home to over 70 research groups, more than 300 researchers and more than 1000 undergraduate students. Researchers in TBSI are supported by several key core facilities for biomedical research, including specific pathogen-free and transgenic animal units, flow cytometry suite, confocal microscopy suite, NMR facility and level-2 and level-3 containment suites. It houses a significant number of international recognized leaders in biomedical research, especially in the area of
immunology.
By all metrics of research success, including grant awards and publications (quality and citations), a significant number of PIs in TBSI are internationally competitive. TBSI researchers have generated grant income of over €200m in the last 10 years.
TBSI consolidates pre-clinical biomedical sciences research across five schools, Biochemistry and Immunology, Medicine, Chemistry, Pharmacy & Pharmaceutical Sciences and BioEngineering. TCD has developed significant international strength in a number of research themes, including Immunology, Inflammation and Infection and is committed to strategically developing this and other areas of research strength.

24
Introduction . Trinity Biomedical Sciences Institute (TBSI) . Professor
Kingston Mills
Professor Kingston Mills, Academic Director, Trinity Biomedical Sciences Institute
“
TBSI has 29,000 m2 of research space and is home to over 70 research groups, more than 300 researchers and more than 1000 undergraduate students.”
Trinity Translational Medicine Institute (TTMI)

TTMI is located the grounds of St James’s Hospital, the largest acute general hospital in Ireland and site of the new National Children’s Hospital. The research focus of the institute is in translational medicine with an emphasis on patient-orientated research and facilitating collaboration between clinicians, scientists and the biomed/biopharma industry. TTMI’s remit extends across St James’s, Tallaght University Hospital, Our Lady’s Hospital for Sick Children (Children’s Health Ireland) and the Coombe Women and Children’s Hospitals, creating the Trinity Translational Development Pathway, based on international best practice.
The location of TTMI within the acute hospital setting, enhances the study of a broad spectrum of disease states underpinned by collaborations with fundamental, translational, and clinical research practitioners and Biobank/patient accessibility.
The close proximity of the Wellcome Trust – HRB Clinical Research Facility enables the expedient translation of clinical research breakthroughs into opportunities for regulated clinical trials.
The substantive co-operative Institute currently houses approximately 50 principal investigators (PI’s) and 160 research scientists working under research themes that include Infection and Immunity, Cancer, Genomics of Disease and Nanomedicine. Child Health is an area of research prioritisations within the Institute and is embedded in all research themes. PIs are funded by multiple funding bodies and charities including Science Foundation Ireland, Health Research Board, Irish Research Council, Enterprise Ireland, European Union, Irish Cancer Society, Breakthrough Cancer Research, Royal City of Dublin Hospital Trust. The research is supported by a range of key enabling technologies that include advanced microscopy (incorporating High Content Analysis), Flow cytometry, Single cell sequencing and Next Generation Sequencing.

25
Introduction . Trinity Translational Medicine
Institute
(TTMI) . Professor Aideen Long
Professor Aideen Long, Director, Trinity Translational Medicine Institute (TTMI)
“
50 principal investigators (PI’s) and 160 research scientists working under research themes that include Infection and Immunity, Cancer, Genomics of Disease and Nanomedicine.”

Wellcome-HRB Clinical Research Facility
Professor Martina Hennessy, Clinical Director, Wellcome Clinical Research Facility, St James Hospital

The Wellcome-HRB Clinical Research Facility is a state-of-the-art clinical space located at the centre of St James hospital (SJH-CRF), dedicated to research involving patients since 2013. It is a partnership between TCD, St. James’s Hospital the HRB and the Wellcome Trust with a highly experienced multidisciplinary staff. Since opening, the SJH-CRF has increased clinical trial activity and complexity. To date, the facility has performed over 250 studies and 85 regulated clinical trials and 5 medical-device trials with 1,396 recruits and over 8,000 recruits in total, resulting in 20,000 patient research visits.
The CRF has developed capacity to perform early-phase and complex interventions.
This has led to as high intensity and advanced therapy trials culminating in delivery of vector-mediated gene transfer in adult Haemophilia and infant Spinal Muscular Atrophy patients and CAR-T therapy to patients with myeloma.
The CRF exists on a campus that contains 5 research institutes, 24 out of 27 National specialties and which will soon be shared with the new National Children’s Hospital. It also has partnerships with Tallaght Hospital (TUH), the Coombe (Women’s) and St Patrick's (Psychiatry) delivering studies in all. These later-phase trials and complex clinical interventions positively impact patient access to novel treatments and engagement with research.

27

Cancer Research Strengths
Trinity College Principal Child Health Research Investigators in Paediatric Cancer
Strategic Priorities for Child, Adolescent and Young Adult Oncology
• Professor Owen Smith, Professor of Child, Adolescent and Young Adult (CAYA) Oncology [2022] and Professor of Haematology [2002], Trinity College Dublin and Consultant Paediatric Haematologist at Children’s Health Ireland at Crumlin
Childhood cancer and cancer survivorship
• Professor Michael Capra, Paediatric Oncologist at Children’s Health Ireland
• ChiLTERN (Childhood Liver Tumour European Research Network)
• Irish Childhood Cancer Survivorship project
• smartCARE
Immunotherapy and Immunology of Paediatric Cancer Patients
• Professor Clair M. Gardiner, School of Biochemistry and Immunology, Trinity Biomedical Sciences Institute and Trinity St. James’s Cancer Institute (TSJCI)
• Heightened metabolic responses in NK cells from patients with neuroblastoma suggest increased potential for immunotherapy
• Optimisation of NK cells for paediatric Glioblastoma
Mental Health and Well Being
• Professor Agnes Higgins, Professor in Mental Health
• School of Nursing and Midwifery and Trinity Centre for Practice and Health Care Innovation
• An evaluation of the role of a Cancer Support Specialist within oncology services in CHI at Crumlin - Phase II Katie Nugent Project
Cancer Rehabilitation & Survivorship
• Professor Juliette Hussey, Discipline of Physiotherapy, School of Medicine
• Quality of survivorship amongst childhood central nervous system (CNS) tumour survivors
• An intervention using a Personalised VR Dance Tutor with Progress Monitoring for Survivors of Childhood Cancer
Cancer Trials Ireland
• Professor Aengus O’Marcaigh, Consultant Paediatric Haematologist, Children’s Health Ireland, Crumlin, Clinical Associate Professor of Paediatrics and Clinical Medicine, Trinity College
Paediatric solid tumour genetics
• Professor Maureen O’Sullivan, Consultant Paediatric Pathologist, Clinical Professor, Discipline of Histopathology, Trinity College; Children’s Health Ireland at Crumlin, Dublin
• An Exploration of Novel Therapeutic Targets in Malignant Rhabdoid Tumour
• Pathogenesis of Clear Cell Sarcoma of Kidney – establishing the relative roles of BCOR and 14-3-3e-NUTM2.
• Getting a Handle on Non-Canonical Polycomb Repressor Complex 1 (nc-PRC1) Dysfunction in Oncogenesis.
29 Cancer Research Strengths
. Contents
30 31 33 34 35 36 37 38
Trinity College Principal Child Health Research Investigators in Paediatric Cancer
Name of Researcher
Professor Michael Capra, Paediatric Oncologist at Children’s Health Ireland, Crumlin
Professor Clair M. Gardiner, School of Biochemistry and Immunology, Trinity Biomedical Sciences Institute, TCD and Trinity St. James’s Cancer Institute (TSJCI)
Professor Agnes Higgins, Professor in Mental Health, School of Nursing and Midwifery and Trinity Centre for Practice and Health Care Innovation
Professor Juliette Hussey, Discipline of Physiotherapy, School of Medicine
Professor Aengus O Marcaigh, Consultant Paediatric Haematologist, Children’s Health Ireland, Crumlin
Professor Maureen O’Sullivan, Consultant Paediatric Pathologist
Professor Owen Smith, Professor of Child, Adolescent and Young Adult (CAYA) Oncology
Topic (s) of Study
Hepatoblastoma, osteosarcoma, renal tumours, and cancer survivorship
Immunotherapy and Immunology of Paediatric Cancer Patients
Cancer support services for families
Cancer Rehabilitation & Survivorship
Cancer Trials Ireland
Paediatric solid tumour cancer genetics
Child and adolescent randomised peer-reviewed haemato-oncology clinical trials

30 Cancer . Trinity College Principal Child Health Research Investigators in Paediatric Cancer
Strategic Priorities for Child, Adolescent and Young Adult Oncology
Professor Owen Smith, Professor of Child, Adolescent and Young Adult (CAYA) Oncology [2022] and Professor of Haematology [2002], Trinity College Dublin and Consultant Paediatric Haematologist at Children’s Health Ireland at Crumlin
Adolescent and young adult (AYA) patients with cancer are a diverse group as defined not simply by their age and distinct biology of their cancer, but in terms of the challenges they face with regards to adequate access to age-appropriate oncological care, representation on clinical trials, short- and long-term health and psychosocial issues, that include, fertility considerations, transition to survivorship care, psychosocial support, adherence to treatment difficulties and other dilemmas and problems exclusive to this group of patients.
Background to CAYA in Ireland
The recently published, Framework for the Care and Support of Adolescent and Young Adults (AYA) in Ireland [2021-2026] report succinctly outlines strategies to coordinate state-of-the- art integrated AYA care to be delivered locally when possible but centralised when necessary, by providing separate facilities and specialist care teams for these patients. It then goes on to say that once this has been achieved the challenge will then be to secure the future through education, research/ innovation and future service developments.
The ultimate aim of the framework is to improve the standards and quality of cancer care provided to AYAs and at the same time define outcome measures of high-quality care for AYA patients across the proposed AYA cancer network as outlined in the Cancer Strategy [2016-2026]. This network construct which consists of the Adolescent Young Adult Cancer Services Partnership (AYACSP – Children’s Health Ireland and St. James’s Hospital) and its two network partners at Cork and Galway has now been approved by the National Cancer Control Programme.
My proposed 5 year research priorities outlined below are fully in keeping with the Cancer Strategy [2017-2026] but perhaps more importantly will help to fast track the implementation of key areas within framework document.
Creation of a Trinity Centre for CAYA Cancer Survivorship Research
Survival of CAYA cancer has considerably improved with advances in cancer-directed therapies. New approaches hold promise for decreasing treatment-related toxicities,
improving the likelihood of survival, and enhancing long-term quality of life for survivors. Nevertheless this population is at very high risk of late occurring health problems, including significant morbidity and early mortality. Current models of cancer care, with a focus on the acute, active phase of treatment fail to address the many unmet needs of CAYA survivors of cancer. The creation of a Centre for CAYA Cancer Survivorship Research, comprised of an interdisciplinary collaborative working group of healthcare professionals from Trinity College Dublin (MSc Cancer Survivorship course), Children’s Health Ireland, St. James’s Hospital, trainees, community health professionals and patient advocates will address the unique barriers to high quality care for this group, when developed.
The research would focus on population health, health services and systems, wellbeing, quality of life, and medical outcomes among CAYA cancer survivors under the age of 40. The main aim of the Centre will be to train the next generation of researchers in CAYA cancer survivorship and four research streams are proposed, namely; (i) Biomedical Outcomes (ii) Psychosocial & Behavioural Outcomes , (iii) Health Service Outcomes and (iv) Epidemiology & Population Science Outcomes –
AYA Cancer Clinical Trials & Research
It is well documented that enrolment into clinical trials is fundamental to improve clinical outcomes for cancer patients. Some of the newest, most innovative cancer treatments are only available through clinical trials. In general patients participating in trials are typically followed more closely by their care providers than other patients. For AYA with cancer, a multifaceted strategy is needed to modify traditional approaches to clinical trial regulation and improve drug development. Since no legal or regulatory barriers exclude adolescents from
31 Cancer . Strategic Priorities for Child, Adolescent and
Adult
Young
Oncology . Professor Owen Smith
participating in adult phase I and II clinical trials, AYA accrual in such trials must be increased. In line with the proposal made by the ACCELERATE Fostering Age Inclusive Research (FAIR) trial, the AYA Cancer Clinical Trials & Research Programme within the AYACSP and its network partners will support some of their suggested solutions.
The AYACSP service in collaboration with its network partners at Cork and Galway will need to be able to use both a developmental and a family-centred lens, along with a patient-centred lens to support AYA in providing informed consent for participation in biological research and trials. Research designed to include the critical development taking place during the AYA years is needed to understand the psychological and social challenges of AYA-onset cancer. In addition, AYA research should benefit uniquely from including the perspectives of AYA themselves, namely the Young Persons Advisory Group (age 12-29 years) recently set up at the National Children’s Cancer Service, CHI at Crumlin as well as nurses and psychosocial researchers as partners within their research teams, whatever the research focuses upon.
Implementation of genomic testing in AYA cancer
As recently as a decade ago, the genetic aberrations that cause cancer, oncogenic drivers, remained elusive especially in children and adolescents. Genomic sequencing projects that were underway focused on adult cancers. At the same time, major advances were being made in sequencing technologies that resulted in lower costs and faster results
Ireland has significantly lagged behind in introducing genomics into the clinic. Therefore, this study aims to implement genomic diagnostics in AYA cancer care across the Adolescent Young Adult Cancer Service Network (AYACSN) comprising St. James’s Hospital, Galway and Cork University Hospitals. The study will attempt to show that whole genome sequencing (WGS) and gene expression / fusion analysis (RNAseq) for AYA cancer patients can be integrated as an effective first-tier diagnostic in the Irish frontline healthcare
system, that is scalable in terms of capacity, and future proof. Ultimately it is the goal to transition to a “one-size-fits-all” diagnostic approach.
Down syndrome leukaemia
Ireland has one of the highest rate of Down syndrome (DS) in the European Union (EU). Compared to the non-DS population, individuals with DS are 500 times more likely to be diagnosed with acute myeloid leukemia (ML- DS) and 20 times more likely to be diagnosed with acute lymphoblastic leukemia (DS-ALL). The risk for DS-leukemia is greatest during early childhood (ages 1–4), a critical neurodevelopmental period. Treatment for DS-leukemia (DS-ALL in particular) involves central nervous system (CNS)- directed chemotherapy.

Treatment for DS-ALL is 2.5 – 3 years in duration with extended periods of immunocompromise resulting in missed opportunities for social interaction, early intervention and education services that support developmental gains throughout childhood. It has been well- established that survivors of childhood ALL without DS have a higher risk of neurocognitive deficits. Given the pre-existing cognitive vulnerability in DS, the cumulative impact of CNS- directed treatment and missed community participation may add to neurocognitive deficits. Compared to survivors of leukemia without DS, survivors of DS-leukemia may be at increased risk for treatment late effects and poorer quality of life.
A better understanding of DS-leukemia genomics may have implications for surveillance and diagnosis – all children, adolescents and young adults with DS will be offered genomic testing (somatic and germline). Evidence-based approaches to supportive care, improved assessment and management of side effects and toxicities in DS leukemia will be developed. Longitudinal studies of neurodevelopmental, health, and quality of life outcomes in cancer survivors beginning during therapy, in order to inform supportive care and interventions to ameliorate problems will also be developed members of the Trinity Centre for CAYA Cancer Survivorship Research.
32 Cancer . Strategic Priorities for Child, Adolescent
and Young Adult Oncology . Professor Owen Smith
This lack of data is arguably the greatest limiting factor to the development of a world-class national service in Ireland for survivors of childhood cancer.”
Childhood cancer and cancer survivorship
Professor Michael Capra, Paediatric Oncologist at Children’s Health Ireland, Crumlin, Discipline of Paediatrics, Trinity College Dublin
Professor Capra is an active international collaborative clinical researcher in the field of Paediatric Oncology. Within the arena of survivorship, Professor Capra has recently set up and commenced the Irish Childhood Cancer Survivorship Project to produce i) a population-based database of childhood cancer survivors and ii) a needs assessment of survivors and their parents/caregivers together of that of the health-care professionals involved in the delivery of such a service. Commenting on the project he said: “Despite the clear clinical needs, there has traditionally been no population-based data on the numbers of childhood cancer survivors in Ireland, nor are there figures for cancer- or treatment-related effects. This lack of data is arguably the greatest limiting factor to the development of a world-class national service in Ireland for survivors of childhood cancer.”
Irish Childhood Cancer Survivorship project

Despite the clear clinical needs, there has traditionally been no population-based data on the numbers of childhood cancer survivors in Ireland, nor are there figures for cancer- or treatment-related effects. This lack of data is arguably the greatest limiting factor to the development of a world-class national service in Ireland for survivors of childhood cancer. This database will allow for effective transitioning from paediatric to adult care by use of a survivorship passport. It will facilitate data analysis, together in outlining a needs assessment of survivors and health-care professionals, to assist the construction of a robust national survivorship service for childhood cancer survivors. Crucially it will provide future research opportunities to improve current treatments, minimise late side-effects, and provide opportunities for accurate screening and surveillance.
smartCARE
This is an EU4H funded grant project, which aims to develop a Cancer Survivor Smart Card to improve the quality of life and health status of cancer survivors, in the form of a mobile application that embraces the core attributes of patient-centred care. The project will run an extensive user’s needs assessment to achieve the fullest understanding of the range of survivors, caregiver and healthcare professionals’ needs associated to the development of a cancer survivor smart card. The application will comprise three main elements: treatment summary, resources functions and follow-up care plans and self-management tools.
33 Cancer .
Childhood cancer: hepatoblastoma, osteosarcoma, renal tumours, and cancer survivorship . Professor Michael Capra
“
Immunotherapy and Immunology of Paediatric Cancer Patients
Professor Clair M. Gardiner, School of Biochemistry and Immunology, Trinity Biomedical Sciences Institute and Trinity St. James’s Cancer Institute (TSJCI)
Immunotherapies have revolutionised cancer treatments. However, they have been developed almost exclusively for adults and ignore fundamental biological differences in paediatric cancers and paediatric Immunology that influence efficacy. We investigate the impact that cancer has on Natural Killer (NK) function and metabolism with a view to restoring immune function for autologous therapy and for optimising allogeneic cell therapies including CAR-NK cells. This is an exciting area with huge potential for improved outcomes for both haematological and solid tumours.
Heightened metabolic responses in NK cells from patients with neuroblastoma suggest increased potential for immunotherapy
Neuroblastoma is the most common extracranial tumour in children and despite the introduction of anti-GD2 immunotherapy in 2010, the 5 year EFS (~56%) remains poor for children with high risk neuroblastoma. Collaborating with Dr. Cormac Owens (CHI at Crumlin), Clair’s team has recently published research findings highlighting the potential for improved immunotherapy for neuroblastoma patients. Anti-GD2 immunotherapy utilises NK cells as part of its mechanism of action and despite evidence of some functional exhaustion, key aspects of cytotoxicity, CD16 expression and metabolic fitness were maintained. Defining the importance of NK cell glycolysis for ADCC of anti-GD2 coated tumour cells highlighted a novel mechanism by which NK cell therapies (autologous or allogeneic) can be optimised.

Optimisation of NK cells for paediatric Glioblastoma
This new work (with Dr. Sarah Curry, CHI at Crumlin) is designed to identify specific targets in paediatric brain tumours that can be targeted for NK cell based therapy in patients. In particular, paediatric high grade gliomas (HGG) have a 20% survival at 5 years and diffuse mid-line gliomas has a median survival of 9-11 months. Evidence is emerging to demonstrate that NK cells can cross the BBB and kill glioblastoma cells.
Understanding how NK cells are targeted and dysregulated by these cancers will provide key information to develop new and improved therapies that focus on getting NK cells to the tumour and optimising them to survive and kill tumour cells when they get there.
34 Cancer . Immunotherapy and Immunology of Paediatric Cancer Patients . Professor Clair M. Gardiner
“
The goal of my research in this area is to understand how the immune systems of children can be harnessed optimally to specifically treat paediatric cancers.”
Mental Health and Well Being
Professor Agnes Higgins, Professor in Mental Health School of Nursing and Midwifery and Trinity Centre for Practice and Health Care Innovation
Professor Higgins leads a programme of research in the area of mental health. As a leader of multidisciplinary and multi-institutional research bids with internationally recognised partners and in line with a key priority of government and national/international mental health policy, her research programme is focused on building a body of work that promotes mental health recovery, drives mental health service reform and improves mental health practice. She has led many research teams to successful completion of diverse projects, including research with young people and the LGBTQI+ community.
An evaluation of the role of a Cancer Support Specialist within oncology services in CHI at Crumlin - Phase II Katie Nugent Project
This project - in collaboration with M Murphy (Trinity), Dr C Hillard (CHI Crumlin) and Prof M Brenner (UCD) - is the second phase of a study focussed on enhancing the support offered to children and their families within an oncology service.
“This research aims to evaluate the introduction and impact of the role of cancer support services within inpatient and day care oncology services in CHI Crumlin. The information gained will provide a broad and detailed understanding of parents’ needs and the degree to which they are being met. This approach will enable the service to develop so that it can meet parents’ needs more effectively. A new service framework can then be developed, implemented and reviewed.”

35 Cancer . Mental Health and Well Being
Professor Agnes Higgins
“
This research aims to evaluate the introduction and impact of the role of cancer support services within inpatient and day care oncology services in CHI Crumlin.”
Cancer Rehabilitation & Survivorship
Professor Juliette Hussey, Discipline of Physiotherapy, School of Medicine
Advances in both diagnostics and therapeutic interventions for patients with cancer mean an increasing number of people are living with and beyond cancer. Research in cancer rehabilitation is a recent but expanding field. My research is multidisciplinary, focused both on outcomes and underlying mechanisms. Many patients complete initial treatment (surgery, chemotherapy, radiation) with significantly reduced physical performance (poor exercise tolerance, muscle weakness and lower levels of muscles mass with increased body fat). These impairments have been the focus of our intervention studies along with examining the means of reducing cardiovascular risk factors and secondary disease by improving body composition and aerobic capacity.
Quality of survivorship amongst childhood central nervous system (CNS) tumour survivors
With advancements in surgical techniques, imaging and adjuvant therapies, survival rates for children with central nervous system (CNS) tumours have improved and priorities have now shifted to focus on late-effects and quality of survivorship amongst childhood CNS tumour survivors.
We examined levels of cardiorespiratory fitness, physical activity and health-related quality of life (HRQoL) amongst survivors of childhood CNS tumours and found these survivors present with poor levels of physical activity along with impaired cardiorespiratory fitness and HRQoL. Higher levels of cardiorespiratory fitness are associated with higher levels of HRQoL.
An intervention using a Personalised VR Dance Tutor with Progress Monitoring for Survivors of Childhood Cancer
SFI Centre for Research Training in Digitally-Enhanced Reality (d-real) ‘d-real’ is the Science Foundation Ireland (SFI) Centre for Research Training in Digitally-Enhanced Reality. A PhD project within the centre will study ‘An intervention using a Personalised VR Dance Tutor with Progress Monitoring for Survivors of Childhood Cancer’.
The project is being supervised by Professor Juliette Hussey with Dr Shirley Coyle Dublin City University ( Assistant Professor in School of Electronic Engineering) in conjunction with Children’s Health Ireland (CHI).
Multimodal digital media across video, text, image and speech and Virtual/Augmented Reality ( VR/AR) is rapidly changing our worlds of work and leisure. Incorporating digital media into our physical world provides new opportunities, including the application of games to increase exercise engagement and increase the level of physical activity in children/adolescents who have survived cancer. Exergames, Wii Fit and dance simulations can lead to moderate levels of energy expenditure. Creating engaging games that may have different levels/progression and elements of competition may engage cancer survivors who are not engaged in regular activity. It could also facilitate the option to create a social community of users. More information on the d-real centre
36 Cancer . Cancer Rehabilitation & Survivorship . Professor Juliette Hussey
“
Children with central nervous system (CNS) tumours have improved and priorities have now shifted to focus on late-effects and quality of survivorship.”
The Paediatric Group within Cancer Trials Ireland was founded by Dr Aengus O’Marcaigh. These trials represent the biggest clinical trial group in Ireland and includes 23 separate paediatric clinical trials.”

Cancer Trials Ireland
Professor Aengus O’Marcaigh, Consultant Paediatric Haematologist, Children’s Health Ireland, Crumlin, Clinical Associate Professor of Paediatrics and Clinical Medicine, Trinity College
Active Research
The Paediatric Group within Cancer Trials Ireland represents the biggest clinical trial group in Ireland and includes 23 separate paediatric clinical trials. They are involved in the design of trials with the Children’s Cancer and Leukaemia Group for the treatment of childhood acute myeloid leukaemia, and with a broad European Consortium for the treatment of Myeloid Leukaemia, specifically in children with Trisomy 21.
Published many clinical case reports and contributed to national Irish and United Kingdom guidelines on the treatment of myeloid leukaemia of Trisomy 21.
The group leads multiple international phase III collaborative group clinical trials for the treatment of childhood leukaemia, both myeloid and lymphoblastic. Their research includes phase I-II trials on the use of Inotuzumab for the treatment of relapsed or refractory paediatric lymphoblastic leukaemia, and evaluating the contribution of complimentary therapy to the well-being of children undergoing chemotherapy.
37 Cancer . Cancer Trials Ireland . Professor Aengus O’Marcaigh
“
The Paediatric Group within Cancer Trials Ireland was founded by Dr Aengus O’Marcaigh. These trials represent the biggest clinical trial group in Ireland and includes 23 separate paediatric clinical trials.
Paediatric solid tumour genetics
Professor Maureen O’Sullivan, Consultant Paediatric Pathologist, Clinical Professor, Discipline of Histopathology, Trinity College; Children’s Health Ireland at Crumlin, Dublin
Professor O’Sullivan’s clinical and research interests are in paediatric solid tumours and she undertakes research on the genetics, epigenetics and biology of these tumours. With a particular focus on sarcomas and paediatric renal tumours, her group has characterised several novel chromosomal translocations and studied the biological impact these have on cell biology. “This research has benefits in terms of diagnosis, prognosis, biological understanding and novel therapeutic development for these rare cancers, which are all too often neglected despite their aggressive nature.”
An Exploration of Novel Therapeutic Targets in Malignant Rhabdoid Tumour
Malignant rhabdoid tumour (MRT) is a highly aggressive type of cancer and occurs primarily in young children, particularly in the first year of life. Despite being such an aggressive cancer, it is characterised by a single change in the genetic blueprint (DNA) whereby a particular gene’s function is lost. Dogma is that generally five or six changes need to occur before a full-blown human cancer develops. How this single change leads to cancer, and especially such an aggressive cancer, is not fully understood. This project was designed to take a new approach to understanding what goes wrong in the cell when this gene’s function is lost, leading to MRT developing.
It is known that the change in the DNA in MRT involves a particular gene which has a big role in the organisation of the DNA itself, and thereby acts like a 'master switch' in the cell, having a major impact on which of the 20,000 genes in the cell are “on” and which are “off”. The aim of the project was to study the organisation of the DNA in the cell, to explore what is driving the cancer. This was achieved using a model system of MRT developed by the O’Sullivan lab, whereby it was possible to selectively replace the gene that is lost in order to study how this impacts the organisation of the DNA. By comparing MRT lacking this key gene with the model that has the missing gene replaced, the team was able to see where there might be vulnerabilities in the tumour that could be exploited for the development of new drugs. At the same time, the team examined what cell type MRT arises from, which was unknown, but has a real clinical importance as the treatment strategies for cancer must take into account the type of tissue or cell involved to improve outcomes.
The research found a primitive type of cell that may be the cell of origin for MRT. These cells are like stem cells and can specialise into other cell types like fat cells or connective tissue cells. The O’Sullivan team showed
that these primitive cells had problems with DNA regulation, which led to them not maturing properly, and instead becoming cancerous.
Pathogenesis of Clear Cell Sarcoma of Kidney – establishing the relative roles of BCOR and 14-3-3e-NUTM2.
Clear Cell Sarcoma of Kidney (CCSK), the second commonest childhood renal malignancy occurs in the first decade of life. We previously characterized chromosomal translocation t(10;17)(q22;p13), the only recurrent genetic aberration identified in CCSK over decades, to show the in-frame fusion 14-3-3e-NUTM2. Simultaneously this fusion was described in high-grade endometrial stromal sarcoma (HGESS), lending credence to its oncogenic role. More recently, infantile undifferentiated round cell sarcomas (URCSI) has shown this aberration too, as has primitive myxoid mesenchymal tumour of infancy (PMMTI).
We were able to show that the oncogenesis in the context of 14-3-3e-NUTM2 expression hinges on dysregulation of the MAPK-AKT pathway. This we established in our cell line model system, with which we were able to selectively induce expression of the fusion gene. We’re now focussing on an alternative, mutually exclusive but far more frequent, oncogenic driver of the same group of tumours mentioned above, now known also as the BCOR tumour family, as the oncogenic driver here is an internal tandem duplication within the final exon of the BCOR gene (BCOR-ITD). This final exon encodes the PUFD domain of BCOR. BCOR is a component of the multi-protein non-canonical Polycomb Repressor Complex 1 (nc-PRC1; also PRC1.1), which has been reported as being involved in transcriptional silencing. Indeed, the PUFD domain of BCOR, which is specifically the region affected by the ITD, interacts with the RAWUL domain of PCGF1, another PRC1.1 subunit, which together with RING1B then mono-ubiquitinates histone 2A lysine 119 (H2AK119Ub1) resulting in transcriptional silencing.
38 Cancer . Paediatric solid tumour genetics . Professor Maureen O’Sullivan
“
This work will result in improved therapies for a highly aggressive childhood cancer.”
An epigenetic basis to human cancer has been emerging in recent years with evidence that 20% human cancers have mutations in chromatin regulators. Thus what this investigation reveals will be immediately relevant far more broadly in human cancers beyond just CCSK and other BCOR family tumours.
In this study, we are focussed on HOW exactly the internal tandem duplication within BCOR leads to its oncogenic effect - what the impact of this ITD is on the protein’s ability to interact with other subunits for assembly of the complex to occur, and in turn what the effect is in terms of the PRC1.1 function in gene transcriptional silencing. To this end, we are using highly sophisticated genetic engineering to generate a cell line model that closely mimics BCOR-ITD tumours with a paired wild-type model to then investigate just how the ITD leads to oncogenesis. We previously sequenced a very large cohort of CCSKs to characterise a number of distinct groupings of ITD, including indeed a triplication event –the results of that work has informed the cell line constructs we have generated, thus mimicking the human cancer closely. Using these cell lines we are investigating any disruption to complex assembly through several techniques including IP-mass spectrometry, size-exclusion chromatography and western blotting as well as molecular dynamic simulations of the ITD. Together with our world-class team of collaborators, we expect to uncover a completely novel mechanism of oncogenesis.
The work for this particular grant-funded project has now finished, but the impact of the team’s work continues and research teams from Toronto and Dublin are collaborating on MRT research which will continue to drive progress forward for this rare and aggressive cancer.
https://www.cclg.org.uk/our-research-projects/ db68ab3b-8f9c-467f-8c54-b1ced28bcf6e
Getting a Handle on Non-Canonical Polycomb Repressor Complex 1 (nc-PRC1) Dysfunction in Oncogenesis.
In this project, the oncogenic effect specifically is being investigated to establish the functional effect of the BCOR-ITD at chromatin level. Again, using our model cell lines as described for the prior project, but also with human tumour tissue samples and normal kidney tissue controls, the impact of the BCOR-ITD on histone modification and thus predicted effect on gene transcription is being investigated. In parallel, there is profiling of the actual gene transcription through RNA sequencing of wild-type and the various BCORITD-bearing cell lines to establish what similarities and differences in gene expression result directly from just the expression of the BCOR-ITD. The findings here will be correlated with the chromatin “profiling” of the corresponding cell lines also incorporating polycomb and histone modification chromatin immunoprecipitations (ChIPs). Furthermore, our cell line model allowing inducible expression of the 14-3-3e-NUTM2 fusion will also be subjected to transcriptomic profiling to interrogate for the commonalities between this oncogenic fusion and the BCOR-ITD, both of which independently lead the development of the same tumours ultimately.
Finally, given the striking level of DNA methylation identified within CCSK, which in fact is the most highly methylated childhood tumour, the methylomes of our model cell lines are being compared and integrated with the epigenomic findings from the above work as indeed are tumour tissue samples.

39 Cancer . Paediatric solid tumour genetics .
O’Sullivan
Professor Maureen
“
The impact of the team’s work continues and research teams from Toronto and Dublin are collaborating on MRT research which will continue to drive progress forward for this rare and aggressive cancer.”

Clinical Research
Trinity College Principal Child Health Research Investigators in Clinical Research
Wellcome-HRB Clinical Research Facility
• Professor Martina Hennessy, Clinical Director, Wellcome Clinical Research Facility, St James Hospital
• DYNE: A Randomized, Double-Blind, Placebo-Controlled, Multiple Ascending Dose Study Assessing Safety, Tolerability, Pharmacodynamics, Efficacy, and Pharmacokinetics of DYNE-
• Neurological Outcome and NeuroIMAging, NEON.
• RECONNECT study of a cannabinoid patch to modify behavioural changes in fragile X
• CDKL5: Plasma microtubule proteins as potential biomarkers for CDKL5 Deficiency Disorder (CDD)
• FONTAN, an observational study looking at Cardiac Function in Fontan patients and assessing advance functional parameters prior to and after an exercise programme.
HRB Irish Network for Children’s Clinical Trials – In4kids
• TREOCAPA
• PROTECT
• EARLY DETECTION OF CEREBRAL PALSY IN IRELAND
Childhood cancer and cancer survivorship
• Professor Michael Capra, Paediatric Oncologist at Children’s Health Ireland, Crumlin, Discipline of Paediatrics, Trinity College Dublin; Children’s Health Ireland, Crumlin
• ChiLTERN (Childhood Liver Tumour European Research Network)
• Irish Childhood Cancer Survivorship project
Haemato-Oncology Clinical Trials
• Professor Owen Smith, Professor of Child, Adolescent and Young Adult (CAYA) Oncology [2022] and Professor of Haematology [2002], Trinity College Dublin and Consultant Paediatric Haematologist at Children’s Health Ireland at Crumlin.
• MyeChild 01
• Acute Lymphoblastic Leukaemia - ALLTogether 01
• Interfant ‘21
Spinal Muscular Atrophy and Duchenne Muscular Dystrophy
• Dr Declan O’Rourke, Senior Clinical Lecturer, Children’s Health Ireland at Temple Street
• Spinal Muscular Atrophy
• Duchenne Muscular Dystrophy
41 Clinical Research . Contents
43 44 45 46 47 48
Clinicals trials for Haemostasis & Thrombosis
• Dr Beatrice Nolan, National Paediatric Consultant Haematologist, Children’s Health Ireland (CHI) at Crumlin
• The European Paediatric Network for Haemophilia Management ( PedNet Registry)
• Long-term Safety and Efficacy Study of Fitusiran in Patients With Hemophilia A or B, with or without Inhibitory Antibodies to Factor VIII or IX
• A Research Study Investigating Mim8 in Adults and Adolescents With Haemophilia A With or Without Inhibitors
• An International Study to Evaluate the Real-world Effectiveness and Usage of Alprolix in Patients With Haemophilia B
• Safety, Efficacy and PK of BIVV001 in Pediatric Patients With Haemophilia A
• rFVIIIFc (Elocta®) ITI Chart Review in Patients With Haemophilia A
Allergy in children
• Dr Aideen Byrne, Consultant in Paediatric Allergy, Clinical Senior Lecturer
• Early introduction of food allergens
• Accidental food allergic reactions
Perinatal Outcomes of Childbirth
• Professor Deirdre J Murphy, Chair in Obstetrics, School of Medicine
• The FIRSST trial - Fetal Scalp Stimulation (dFSS) versus Fetal Blood Sampling (FBS) to assess fetal well-being in labour – a multi-centre randomised controlled trial.
NCT05306756
Improving recruitment to clinical trials involving neonates
• Professor Valerie Smith, Professor in Midwifery
• Training tRial recruiters: An educational INtervention for recruiters to neonatal trials (TRAIN)
42 Clinical Research . Contents
49 50 51 52
Trinity College Principal Child Health Research Investigators in Clinical Research
Name of Researcher
Dr Aideen Byrne, Consultant in Paediatric Allergy, Clinical Senior Lecturer
Professor Michael Capra, Paediatric Oncologist at Children’s Health Ireland, Crumlin, Discipline of Paediatrics, Trinity College Dublin; Children’s Health Ireland, Crumlin
Professor Martina Hennessy, Clinical Director, Wellcome Clinical Research Facility, St James Hospital
Professor Eleanor Molloy, Professor and Chair of Paediatrics, Trinity College Dublin & Professor Geraldine Boylan, Professor of Neonatal Physiology, Department of Paediatrics & Child Health, University College Cork
Professor Deirdre J Murphy, Chair in Obstetrics, School of Medicine
Dr Beatrice Nolan, National Paediatric Consultant Haematologist, Children’s Health Ireland (CHI) at Crumlin
Professor Aengus O Marcaigh, Consultant Paediatric Haematologist, Children’s Health Ireland, Crumlin
Dr Declan O’Rourke, Senior Clinical Lecturer, Children’s Health Ireland at Temple Street
Professor Owen Smith, Professor of Child, Adolescent and Young Adult (CAYA) Oncology
Professor Valerie Smith, Professor in Midwifery
Topic (s) of Study
Allergy in children
Childhood cancer: hepatoblastoma, osteosarcoma, renal tumours, and cancer survivorship
Director of The Wellcome-HRB Clinical Research Facility
Co-Directors of HRB Irish Network for Children’s Clinical Trials – In4kids
Perinatal Outcomes of Childbirth
Clinicals trials for Haemostasis & Thrombosis
Cancer Trials Ireland
Spinal Muscular Atrophy and Duchenne Muscular Dystrophy
Haemato-Oncology Clinical Trials
Improving recruitment to clinical trials involving neonates
43 Clinical Research . Trinity College Principal Child Health Research Investigators in Clinical Research
Wellcome-HRB Clinical Research Facility
Professor Martina Hennessy, Clinical Director, Wellcome Clinical Research Facility, St James Hospital
In 2021 CHI and CRF at SJH signed a high-level agreement to collaborate to improve access to advanced therapy trials in children. By synergising infrastructure across the SJH campus, the CRF hopes to encompass adolescent – young adult transitional research and advanced therapy trials for cancer and non-cancer disorders in children.
Traditionally, paediatric clinical research is conducted separately from its adult equivalent, with the AYA transition marking a change in tempo with respect to clinical trials. The effect is clearly seen in paediatric cancer care, where survival benefit correlates with enrolment in clinical trials. However, during the “adolescent gap” enrolment and access to innovative treatments drop dramatically along with survival benefit. In non-malignant conditions clinical stability and long-term functional gain is risked if a coherent research programme is disrupted during transition to the adult setting. This atomistic approach is contrary to momentum and outcomes for advanced therapy (AT) research.
Medical advances like CRISPR and TALEN abolish the boundaries between paediatric and adult research with striking effect. Outstanding successes have been gained in the fields of perinatology and in the long-term survival of patients with once fatal childhood conditions like spinal muscular atrophy (SMA), cystic fibrosis and congenital heart disease. Our own success in treating infants with SMA has demonstrated; (i) what can be achieved through collaboration between CHI and the SJH-CRF and (ii) the need for robust accessibility pathways to a safe and innovative AT service to be created at a national level for adults and children.
Advanced treatments are in development in 18 paediatric and adult neurological disorders, with 32 treatments being explored in clinical trials across a spectrum (neurology, oncology haematology). We anticipate trials, authorised products complex interventional and observational studies will be areas of significant growth across paediatrics over the next 5 years. Advanced therapies stretch the limits of compounding and clinical trial processes as well as the differentiation between clinical trials, compassionate use, and clinical services. New methodologies and care pathways are required to investigate, adapt and de-risk scenarios for each child and ensure processes
are transparent to families and clinicians. New outcome measures, registries and training are needed to assess and follow children that were never expected to live beyond early childhood or survive to enter adult care.
Some examples of current and planned paediatric research undertaken at the SJH-CRF
• To-date nine children ranging from 6 weeks to 2 years have received single treatment gene therapy for spinal muscular atrophy. Collaborator: Dr Declan O Rourke at CHI Temple Street.
• DYNE: A Randomized, Double-Blind, PlaceboControlled, Multiple Ascending Dose Study Assessing Safety, Tolerability, Pharmacodynamics, Efficacy, and Pharmacokinetics of DYNE-251 administered to participants with Duchenne Muscular Dystrophy Amenable to Exon 51 Skipping. Collaborator:Dr Declan O Rourke CHI Temple Street.
• Neurological Outcome and NeuroIMAging, NEON. This subset of a larger study is looking to compare the infants’ MRI to other measurements of the infants’ bloods, examination and development. Collaborator: Professor Eleanor Molloy, CHI Temple Street.
• RECONNECT study of a cannabinoid patch to modify behavioural changes in fragile X
Collaborator: Dr Aoife Mahony
• CDKL5: Plasma microtubule proteins as potential biomarkers for CDKL5 Deficiency Disorder (CDD).
Collaborator: Dr Max Bianchi, Trinity College Dublin
• FONTAN, an observational study looking at Cardiac Function in Fontan patients and assessing advance functional parameters prior to and after an exercise programme. Collaborator. Dr Adam James CHI Crumlin
44 Clinical Research . Wellcome-HRB Clinical Research Facility . Professor Martina Hennessy
HRB Irish Network for Children’s Clinical Trials – In4kids
Professor Eleanor Molloy, Professor and Chair of Paediatrics, Trinity College Dublin Professor Geraldine Boylan, Professor of Neonatal Physiology, University College Cork
The HRB Irish Network for Children’s Clinical Trials (In4kids) received funding in November 2021 for five years from the Health Research Board and fulfils a gap in the existing CTN landscape to focus solely on children. The network is led jointly by Professors Geraldine Boylan, Professor of Neonatal Physiology, Department of Paediatrics & Child Health, University College Cork and Professor Eleanor Molloy Professor and Chair of Paediatrics, Trinity College Dublin, with the support of leading Irish Paediatric Principal Investigators.
TREOCAPA
TREOCAPA is a multicentre trial assessing the effectiveness of paracetamol on the closure of the patent ductus arteriosus in extremely premature babies (23-26 weeks’ gestation), as well as the increase in survival rate without severe morbidity in these babies (for babies born between 23-28 weeks). The study is sponsored and coordinated by INSERM, a public r esearch organisation in Paris, France. This study is ongoing in the INFANT Centre, Cork University Hospital.
PROTECT
PROTECT is a large multicentre trial coordinated by the NHMRC Clinical Trials Centre in the University of Sydney. PROTECT seeks to evaluate if Pentoxifylline can improve long-term outcomes in preterm infants with late-onset sepsis or necrotizing enterocolitis.

Recruitment to the PROTECT clinical will begin in the Coombe and Rotunda hospitals in the coming weeks.
EARLY DETECTION OF CEREBRAL PALSY IN IRELAND
is a multicentred non-regulated interventional study in Ireland. This project will aim to improve the Early Detection of Cerebral Palsy in Ireland. This will be achieved by implementing an evidence-based approach to follow-up of high-risk infants. This approach has been previously demonstrated to reduce the age at which CP is diagnosed across a large neonatal network in North America. This study will take place in Maternity Hospitals in Cork, Dublin and Limerick.
45 Clinical Research . HRB Irish Network for Children’s Clinical Trials – In4kids .
Professor Eleanor Molloy . Professor Geraldine Boylan
“
In4kids is working to ensure Ireland produces excellent clinical research to benefit all children by improving the quality and quantity of Children’s Clinical Trials.”
Childhood cancer and cancer survivorship
Oncologist at Children’s Health Ireland, Crumlin, Discipline of Paediatrics, Trinity College Dublin
Professor Michael Capra, Paediatric
Professor Capra is an active international collaborative clinical researcher in the field of Paediatric Oncology. He has been and continues to be the national coordinator of multiple international trials including the phase III EURAMOS (European American Osteosarcoma), SIOP Ependymoma II, PHITT (Paediatric Hepatic International Tumour), the phase II OLIE (Osteosarcoma Lenvatinib Ifosfamide Etoposide) trial, RELIVE (International registry for relapsed/refractory hepatoblastoma and hepatocellular carcinoma in children), and the soon to be opened SIOP-UMBRELLA (Renal Tumours in Childhood) trial.
ChiLTERN (Childhood Liver Tumour European Research Network)
Irish National Coordinator of ChiLTERN: a European-funded project under the Horizon 2020 programme. It is the single largest clinical trial ever undertaken amongst the paediatric population. With over 25 beneficiaries in over 12 European countries, ChiLTERN aims to cure more children with liver cancer, expose fewer children to toxic chemotherapy and ensure their surgery is both effective and safe.
Liver cancer in the paediatric population is rare with an incidence approximately 1-1.5 per million population. The commonest tumour seen in the childhood population is hepatoblastoma (HB), usually seen in young children and infants. Much rarer (about 10% of paediatric liver cancers) is hepatocellular carcinoma (HCC), usually seen in the teenage population and sometimes associated with underlying cirrhotic liver diseases.
The ChiLTERN project builds on a unique opportunity to undertake a comprehensive research programme linked to an ambitious global partnership which will see the single largest clinical trial (the Paediatric Hepatic International Tumour Trial - PHITT) ever undertaken in this population of patients, with several randomised questions in six subgroups of patients.
Irish Childhood Cancer Survivorship project
Despite the clear clinical needs, there has traditionally been no population-based data on the numbers of childhood cancer survivors in Ireland, nor are there figures for cancer- or treatment-related effects. This lack of data is arguably the greatest limiting factor to the development of a world-class national service in Ireland for survivors of childhood cancer. This database will allow for effective transitioning from paediatric to adult care by use of a survivorship passport.
It will facilitate data analysis, together in outlining a needs assessment of survivors and health-care professionals, to assist the construction of a robust national survivorship service for childhood cancer survivors. Crucially it will provide future research opportunities to improve current treatments, minimise late side-effects, and provide opportunities for accurate screening and surveillance.
46 Clinical Research . Childhood cancer and cancer survivorship . Professor Michael Capra
“
Despite the clear clinical needs, there has traditionally been no population-based data on the numbers of childhood cancer survivors in Ireland.”
Haemato-Oncology Clinical Trials
Professor Owen Smith, Professor of Child, Adolescent and Young Adult (CAYA) Oncology [2022] and Professor of Haematology [2002], Trinity College Dublin and Consultant Paediatric
Haematologist at Children’s Health Ireland at Crumlin.
Professor Smith’s main area of research (clinical) has focused on evidence-based child and adolescent randomised peer-reviewed haemato-oncology clinical trials. Within the Medical Research Council Childhood Leukaemia Working Party back in the early 1990s, he focussed on some of the most important pressing issues of the day in relation to evidence-based randomised peer-reviewed child and adolescent leukaemia clinical trials. Professor Smith is currently co-Principal Investigator on three pan European / Global leukaemia clinical trials.
MyeChild 01
Acute Myeloid Leukaemia (AML) in children and adolescents is very rare and many patients relapse, which is when most patients will die. This study will test different chemotherapy treatments during the initial cycles of treatment for patients with newly diagnosed AML to see which chemotherapy treatment decreases the chance of relapse without increasing treatment side effects.
Participants’ blood and bone marrow samples will also be tested so that we can identify markers indicating the risk of relapse for each patient. Patients will be allocated to a disease risk group, which will guide the treatments they will receive throughout the trial.
Sponsor: University of Birmingham
Collaborators:
Assistance Publique - Hôpitaux de Paris, Cancer Research UK, National Cancer Institute, France Pfizer.
Acute Lymphoblastic LeukaemiaALLTogether 01
ALLTogether1 is a treatment study protocol of the ALLTogether Consortium for children and young adults (0-45 years of age) with newly diagnosed acute lymphoblastic leukaemia (ALL).
The main treatment for ALL is chemotherapy, depending on the patient enrolled, there are a number of drugs given in different combinations.
Chemotherapy usually works well for children and young adults with ALL. But we know from research that it is important to look at the risk of the leukaemia coming back after treatment (relapse) and plan
treatment based on this risk. This means giving less treatment to people with a low risk of their leukaemia coming back. And giving more treatment to people with a higher risk of the leukaemia coming back.
The trial uses several factors to find out patients risk groups which determines the treatment they receive, these include:
• Gene changes inside the leukaemia cells
• How quickly leukaemia went away with chemotherapy
Sponsor: Mats Heyman
Collaborators:
Nordic Society for Pediatric, Hematology and Oncology, The Swedish Childhood Cancer Foundation NordForsk.
Interfant ‘21
Interfant-21 International Collaborative Treatment Protocol for Infants Under One Year With KMT2A-rearranged Acute Lymphoblastic Leukemia or Mixed Phenotype Acute Leukemia. This study is a treatment protocol with blinatumomab for infants under 1 year old who are diagnosed with acute lymphoblastic leukemia with a specific unfavourable genetic alteration. The purpose of the study is to improve the outcome of this disease in infants.
Sponsor:
Princess Maxima Center for Pediatric Oncology
Collaborators:
Amgen Europe B.V University of Milano Bicocca
47 Clinical Research . Haemato-Oncology Clinical Trials . Professor Owen Smith
“
We know from research that it is important to look at the risk of the leukaemia coming back after treatment (relapse) and plan treatment based on this risk.”
Spinal Muscular Atrophy and Duchenne Muscular Dystrophy
Dr Declan O’Rourke, Senior Clinical Lecturer, Children’s Health Ireland at Temple Street
Dr Declan O’Rourke is part of the in4kids network, a National Children’s Research Network which promotes collaboration among the paediatric research community in Ireland and increases the country’s national capacity for high-quality, ethical clinical research. Dr O’Rourke leads the in4kids expansion of paediatric clinical trials in neurology. His area of expertise lies in advanced therapeutics in paediatric neuromuscular disorder and he is Principal Investigator in several industry lead multinational interventional studies for children with Spinal Muscular Atrophy (SMA) and Duchenne Muscular Dystrophy (DMD). Children’s Health Ireland at Temple Street is part of the DMD Hub, a network of trial sites with trained staff who are funded to carry out clinical trials for DMD.
Spinal Muscular Atrophy
SMA is a life threatening neurodegenerative disorder and is the most common genetic cause of death in childhood. Infants with this condition are unable to make a protein called Survival Motor Neuron (SMN) protein resulting in degeneration of motor neurons and progressive muscle weakness. Dr O’Rourke’s team are part of several international research teams investigating antisense oligonucleotide therapies to upregulate SMN protein in patients with SMA and are establishing an international SMA registry.
His team have been the first Irish team to deliver gene replacement therapy to children, treating children with SMA in collaboration with Professor Martina Hennessy’s group in the Clinical Research Facility at St James Hospital.

Duchenne Muscular Dystrophy
DMD is a life limiting neurogenerative disorder resulting from absent dystrophin protein production in muscles. The absent dystrophin production leads to muscle fibre degeneration through various pathways. Boys with DMD lose the ability to walk between 9 and 12 years of age and develop progressive cardiac and respiratory failure.
Previously Dr O’Rourke’s group were part of an international group looking at the efficacy of anti-oxidant therapy and anti-inflammatory, nfKb inhibition treatment in boys with DMD. His team are currently part of an international group investigating the efficacy of various exon skipping antisense oligonucleotide therapies for DMD investigating the potential for dystrophin restoration.
48 Clinical Research .
Spinal Muscular Atrophy and Duchenne Muscular Dystrophy . Dr Declan O’Rourke
“
The long term impact is improved therapies and international collaboration to achieve quality of life and lower mortality for children with SMA and DMD.”
Clinicals trials for Haemostasis & Thrombosis
Dr Beatrice Nolan, National Paediatric Consultant Haematologist, Children’s Health Ireland (CHI) at Crumlin
The Haemostasis & Thrombosis Department at Children’s Health Ireland at Crumlin provides the national service for all children with Haemophilia, Allied Bleeding Disorders and Thrombotic Disorders. We participate in both interventional and non-interventional (observational) clinical trials, working closely with a range of multinational pharmaceutical companies in order to ensure that Irish patients receive the best available treatments.
The European Paediatric Network for Haemophilia Management ( PedNet Registry)
Sponsor:
PedNet Haemophilia Research Foundation
Collaborator: Lund University Hospital
Long-term Safety and Efficacy Study of Fitusiran in Patients With Hemophilia A or B, with or without Inhibitory Antibodies to Factor VIII or IX
Drug: Fitusiran
Sponsor : Genzyme, a Sanofi Company
A Research Study Investigating Mim8 in Adults and Adolescents With Haemophilia
A With or Without Inhibitors
Drug:
NNC0365-3769 (Mim8)
Sponsor:
Novo Nordisk A/S
An International Study to Evaluate the Real-world Effectiveness and Usage of Alprolix in Patients With Haemophilia B
Drug: Alprolix
Sponsor: Swedish Orphan Biovitrum
Safety, Efficacy and PK of BIVV001 in Pediatric Patients With Haemophilia A
Drug: efanesoctocog alfa (BIVV001)
Funder: Bioverativ, a Sanofi company
rFVIIIFc (Elocta®) ITI Chart Review in Patients With Haemophilia A
Drug:
Other: rFVIIIFc
Sponsor: Swedish Orphan Biovitrum
Collaborator: Kantar Health
49 Clinical Research . Clinicals trials for Haemostasis & Thrombosis . Dr Beatrice Nolan
“
The Haemostasis & Thrombosis Department at Children’s Health Ireland at Crumlin provides the national service for all children with Haemophilia, Allied Bleeding Disorders and Thrombotic Disorders.”
Allergy in children
Dr Aideen Byrne, Consultant in Paediatric Allergy, Clinical Senior Lecturer
Dr Aideen Byrne is a Paediatric Allergy Consultant in the cross-site Allergy Department at Children’s Health Ireland (CHI). Dr Byrne together with Professor Jonathan Hourihane (now of RCSI) led the two Irish paediatric research sites in Cork and Dublin, taking part in 3 high profile, international, multisite, trials looking at mechanisms for peanut desensitisation in peanut allergic children and adolescents.
• The PEPITES Randomised Clinical Trial (2016-17) was designed to assess the efficacy and safety of wearing a peanut patch (Epicutaneous immunotherapy) in peanut-allergic children. The study demonstrated a response rate of greater than 20% with peanut patch treatment versus control group.
• The subsequent PEOPLE open label 2 year extension study (2017-19) demonstrated that 52% of participants could tolerate the equivalent of 1 peanut at month 36.
• The ARTEMIS trial (2017-2018) was the largest ever peanut treatment trial. It compared the efficacy of AR101 oral immunotherapy versus a taste-masked placebo in peanut allergic children. By the end of the study, 58% of the AR101 group were able to tolerate the equivalent of 4 peanuts versus only 2% in the placebo group.
Early introduction of food allergens
During the 2020 COVID-19 lockdown, Dr Byrne studied virtual approaches to the early introduction of food allergens into high-risk infants.
Accidental food allergic reactions
Dr Byrne’s team have recently completed a prospective study of accidental food allergic reactions in Irish children, funded by the National Children’s Hospital Foundation.
The results of this study will inform future planning of education for families of food allergic children.
Dr Byrne’s team, in collaboration with Dr Audrey Dunn Galvin, Department of Paediatrics and Child Health, University College Cork, are developing inexpensive, validated educational tools to improve the quality of life of carers of food allergic children.

50 Clinical Research . Allergy in children . Dr Aideen Byrne
“
Dr Byrne’s team have recently completed a prospective study of accidental food allergic reactions in Irish children.”
Perinatal Outcomes of Childbirth
 Professor Deirdre J Murphy, Chair in Obstetrics, School of Medicine
Professor Deirdre J Murphy, Chair in Obstetrics, School of Medicine
Child health starts with a safe birth and a healthy mother. My research group is focussed on intrapartum care with later phase translational research including clinical trials, cohort studies, systematic reviews and international evidence-based guidelines. The overall aim is to understand the aetiologies of adverse birth related events and to minimise maternal and perinatal morbidity and mortality by managing labour and birth safely.
The FIRSST trial - Fetal Scalp Stimulation (dFSS) versus Fetal Blood Sampling (FBS) to assess fetal well-being in labour – a multi-centre randomised controlled trial.
NCT05306756
Pregnant women have routine monitoring of the baby’s heart rate when in labour. Women with complicated pregnancies require continuous monitoring using an electronic recorder called a CTG. The CTG produces a continuous recording which is interpreted by the midwife as showing normal, suspicious or abnormal features of the baby’s heart rate. Babies quite commonly demonstrate abnormal features from time to time during the course of labour. In some cases, the abnormal features are of sufficient concern to warrant delivery by emergency caesarean section. In most of these cases the baby is born in good condition and the question arises whether the caesarean section was unnecessary.
In order to reduce the chance of an unnecessary caesarean section additional “second-line” tests can be offered. One such test is where a small drop of blood is taken from the baby’s scalp.
This test involves an internal examination with an instrument to visualise the baby’s head and a small scratch to the baby’s scalp. The blood is tested for acidosis which is an indicator of whether or not the baby is receiving enough oxygen. The test is called a fetal blood sample or FBS. An alternative test is where the doctor or midwife performs a vaginal examination with two fingers and gently rubs the baby’s scalp in an attempt to cause an increase in the baby’s heart rate.
This is a healthy response suggesting that the baby is receiving enough oxygen. The test is called digital fetal scalp stimulation or dFSS. These two “second-line” tests have never been compared in a properly conducted head-to-head comparison. This study aims to compare dFSS and FBS in a large clinical trial completed within four of Ireland’s largest maternity hospitals. This trial will generate important evidence of direct relevance to clinical care and outcomes for mothers and babies.
51 Clinical Research . Perinatal Outcomes of Childbirth . Professor Deirdre J Murphy
“
This research will establish the optimal approach to second-line testing of fetal wellbeing so that unnecessary caesarean sections can be minimised without compromising perinatal outcomes.”
Improving recruitment to clinical trials involving neonates
 Professor Valerie Smith, Professor in Midwifery
Professor Valerie Smith, Professor in Midwifery
Professor Valerie Smith has clinical and research expertise in Midwifery and Maternal and Family Health and leads a Trial Methodology research programme. Often referred to as ‘research on research’, Trial Methodology Research involves the rigorous scientific evaluation of the efficacy of trial research designs and their discrete components to identify how these can be improved or better organised for optimal efficiency and effectiveness. Professor Smith is an Executive Board Member and TCD Lead Partner of the Health Research Board Trials Methodology Research Network (HRB-TMRN).
Training tRial recruiters: An educational INtervention for recruiters to neonatal trials (TRAIN)
Under-recruiting or stopping a trial early due to insufficient recruitment has major implications for trial outcomes, including a reduction in the statistical power of the trial. Yet, overall, ≤50% of trials meet their recruitment targets or do so only with a trial extension. Evidence from qualitative studies suggest that clinicians struggle with both understanding and in communicating trial concepts to trial participants. Education and training trial recruiters helps improve
enthusiasm for trials, builds recruiter confidence, and has been prioritised as an area for future trial methodological research. The TRAIN project, using a Partnership (co-design/co-create) approach, developed and assessed the acceptability of an education and training intervention for recruiters to neonatal trials. The project is now complete. Phase 1 involved evidence synthesis, a systematic review, content analysis of previous training content, and concept analysis of trail recruitment. Phase 2 involved intervention development, and phase 3 involved a pilot study and acceptability testing.
52
Clinical Research . Improving recruitment to clinical trials involving neonates . Professor Valerie Smith
The long term expected impact is that parental decision making will be better informed. Recruitment, overall, will be improved, thereby producing better evidence for clinical care.”
“
footer 53

Child & Family Population health
Introduction to Child & Family Population Health at Trinity College Dublin
• Professor Noel McCarthy, Professor of Population Health Medicine, Public Health & Primary Care
• Dr. Judith Meehan, Assistant Professor, Paediatrics
• Future projected long-term impact of prioritising children
• Paediatrics- National Issues
Trinity College Principal Child Health Research Investigators in Child & Family Population Health
Growing up in Ireland
• Professor Elizabeth Nixon (School of Psychology), Professor Lina Zgaga (School of Medicine), Professor Trevor Spratt (School of Social Work and Social Policy) and Professor Richard Layte (School of Sociology).
• Body mass index and sleep in five year olds
• Timing of puberty and mental health
• An analysis of GUI datasets - GUI Alcohol and other Drugs Study
The Irish Longitudinal Study on Ageing (TILDA)
• Professor Rose Anne Kenny, Chair of Medical Gerontology, School of Medicine
• Adverse Childhood Experiences (ACEs) and wellbeing in older age
• Exploring the impact of the childhood social environment on later life health
• Impact of early life adversity on later life health
• The ALLOSTAT Project
Respiratory Paediatrics
• Professor Basil Elnazir, Consultant in Paediatric Respiratory Medicine. School of Medicine
• The Real World Clinical Outcomes with Novel Modulator Therapy Combinations in People with Cystic Fibrosis (RECOVER)
• The SPACE (Severe Paediatric Asthma Collaborative in Europe)
Epidemiology and addiction from pregnancy to adulthood
• Professor Catherine Comiskey, Professor in Healthcare Modelling and Statistics, School of Nursing & Midwifery
• Identifying and responding to drug and alcohol addiction from birth to young adulthood
• Estimates of the hidden prevalence of COVID-19 among children and young people in the early stages of the epidemic
• Alcohol use and alcohol-related harms: Exploring risk and protective factors among young people living in urban disadvantage
Childhood Diabetes
• Professor Edna Roche, Professor in Paediatrics, Children’s Health Ireland, Tallaght University Hospital
• Irish Childhood Diabetes National Register
• Monitoring and Preventing DKA
55 Child & Family Population Health . Contents
59 60 62 63 64 65 66
• International Diabetes Epidemiology
• Down Syndrome National Register
Children’s Palliative Care
• Dr Samantha Smith, Senior Research Fellow, Centre for Health Policy & Management, School of Medicine
• Improving Children's Palliative Care in Ireland (iCPCi): using evidence to guide and enhance palliative care for children with life-limiting conditions and their families
Severe Neurological Impairment in Ireland
• Professor Denise McDonald Consultant Paediatrician, Tallaght University Hospital & LauraLynn, Ireland's Children's Hospice
• Dr Joanne Balfe, Consultant Paediatrician in Neurodisability and Children's Palliative Care, Children's Health Ireland
• SPIRE- CONCEPT Severe neurological imPairment in IREland - CONsensus-based Clinical datasEt, Prevalence and healthcare uTilisation
• SPIRE-COPE Severe neurological imPairment in IREland: Carer or Parent Experience study
Childhood symptomatic hypermobility: a move towards improved care pathways and targeted treatment’
• Dr Sara Dockrell, Assistant Professor (Physiotherapy), School of Medicine
• Childhood symptomatic hypermobility: a move towards improved care pathways and targeted treatment.
Adolescent back pain in sport
• Dr. Fiona Wilson, Julia Wall, Discipline of Physiotherapy School of Medicine & Dr Bill Meehan, Micheli Center for Sports Injury Prevention and Harvard Medical School.
• Exploring adolescent back pain in sport; prevalence, risk factors, and athlete & clinician management strategies and experiences
Foetal Alcohol Spectrum Disorders (FASD)
• Dr. Katy Tobin, Assistant Professor in Biostatistics, Public Health & Primary Care Assistant Professor in Biostatistics
• FASDcare: Understanding the needs and caregiver burden among family caregivers of people with FASD in Ireland
Life-course health and wellbeing
• Professor Trevor Spratt, AIB Professor in Childhood Research, Social Studies
• Data as evidence: Assessing impact of therapeutic services
• The impact of adversities experienced in childhood on later life outcomes
Lifelong management of chronic conditions for adolescents and young people
• Professor Imelda Coyne, Professor in Children’s Nursing & Director of Trinity Research in Childhood Centre
• Promoting Adolescent Communication and Education (PACE) diabetes study
• Your Opinion Matters: How to Make the Most Out of Talking to Health Care Providers
• Young adults with a rheumatic diagnose; their experiences of participation in paediatric care and of the transition to adult care
• HRB Irish Network for Children's Clinical Trials (in4kids)
56 Child & Family Population Health . Contents
67 68 69 70 71 72 73
Improving outcomes for children with intellectual disabilities and their families
• Dr Carmel Doyle, Head of intellectual Disability Nursing, School of Nursing & Midwifery
• Blended diet for enteral feeding for children with intellectual disabilities and complex health needs
• The Patient's Experience of Nitrous Oxide for Sedation and Relief of Pain During Botulinum Toxin Injection Treatment for Muscle Spasticity in Children
Child and family focused research
• Dr Eleanor Hollywood, Associate Professor in Children’s Nursing, School of Nursing and Midwifery
• A case study of Meath Women’s Refuge and Support Services (MWRSS) children’s programme.
• An evaluation of the Barnardos Ballybeg Playground Service
• School-aged children and the management of Type 1 Diabetes in the primary school environment: an investigation of how to support children, parents, and schools
• Joint research project on identifying integrated family support approaches for families living in the International Protection Accommodation System (IPAS)
Digital Health & Health and wellbeing in childhood chronic illness
• Dr Mary Hughes, Associate Professor in Nursing, School of Nursing and Midwifery
• What Good Digital Health Looks like in the new Regional Health Areas: A Scoping Review
• Scoping Review and Requirements Analysis for design and development of an Advanced Nurse Practitioner digital service initiative for children and young people who have hydrocephalus.
• Gravitate-Health: Empowering and Equipping Europeans with health information for Active Personal Health Management and Adherence to Treatment
• The role of public health nurses in child welfare and protection
Social Environment, Health and Well-Being Among Adolescents in Ireland
• Professor Richard Layte, Head of the Department of Sociology and a Research Professor at the Economic and Social Research Institute
• TeenPath: Social Environment, Health and Well-Being Among Adolescents in Ireland
The impact of traumatic dental injuries and developmental defects of teeth
• Professor Anne C O’Connell, Head of Paediatric Dentistry, School of Dental Science
• Compliance and level of protection afforded by mouthguards for children in GAA clubs.
• A game–based e-learning tool for Trauma
• Prevalence of HSPM
Behaviour analysis and learning
• Dr. Olive Healy, Associate Professor, School of Psychology
• InterAcT- Accomplish & Thrive
• Instructional Design for Literacy
• Early Intervention: NDBI
• Implementation and Dissemination Science
Supporting student teachers to enhance LGBTQ+ inclusivity
• Dr Gavin Murphy, School of Education
• Capacity Building for LGBTI+ Inclusion in Teacher & School Leaders’ Education
• QUEER(Y)ING: Asking questions of teacher and school leader education for LGBTI+ youth and schooling
57 Child & Family Population Health . Contents
75 76 78 79 80 81 82
Establishing normative ranges for biochemical measures
• Professor Gerard Boran, Consultant Chemical Pathologist Tallaght University Hospital/Clinical Professor Trinity College
• CELTIC Ranges Project
• Ferrtest Project
Supporting function in children and young people
• Dr Michelle Spirtos, Assistant Professor, Discipline of Occupational Therapy, School of Medicine
• Dr Katie Cremin, Assistant Professor, Discipline of Occupational Therapy, School of Medicine
• Supporting Transitions to Adulthood Resources (STAR) project
• Assessment and diagnosis of handwriting disorders in children (JOT) Project
• Mobility assistance dogs and the impact on activity levels, gait patterns, balance and quality of life in children with cerebral palsy and neurological impairments.
• Complex Trauma in childhood: Informing Occupational Therapy Practice (COTIC Project)
• Prenatal predictors across biopsychosocial levels of birth outcomes, sensorimotor development and mental health in childhood
• Investigating potential benefits of weighted sleeper pillows for children with mild sensory-related sleep challenges
• The relationship between motor ability and the development of self-care skills in preschool children
Neonatal interventions for infants and families
• Dr Michelle Spirtos, Discipline of Occupational Therapy, School of Medicine
• Irish Neonatal Care Occupational Therapy Study (INCOT Study): The Development of an Occupational Therapy Intervention for Neonatal Units in Ireland
• The contribution of occupational therapy theories and frameworks in supporting critical reasoning for occupational therapists working in neonatal settings.
Supporting Students with Disabilities in Higher Education
• Dr. Clodagh Nolan, Discipline of Occupational Therapy, School of Medicine
• Refining the Psychometric Properties of the Trinity Student Occupational Performance Profile (TSOPP) – A self-report measure of occupational performance difficulties within the student role
• Kim Lombard, PhD Candidate, Dr Clodagh Nolan & Dr. Elizabeth Heron
• The TCD Sense Project and Sensory App
• Dr Clodagh Nolan & Dr. Kieran Lewis
• Uni-Link Self-Management Tool (2021)
• Dr Kieran Lewis, Dr. Clodagh Nolan & Dr Elizabeth McKay
Equitable provision of paediatric care to children experiencing social adversity
• Dr Aoibhinn Walsh, General Paediatrician with special interest in Inclusion Health
• General Paediatrics, Children’s Health Ireland at Temple Street
• The Lynn Clinic: Equitable provision of Paediatric care to children experiencing social adversity
Child Physical and Mental Health
• Dr Prakashini Banka-Cullen, School of Nursing & Midwifery
• A case study of the needs of families living in the International Protection Accommodation System (IPAS)
58
83 84 86 87 88 89 Child & Family Population Health . Contents
Introduction to Child & Family Population Health at Trinity College Dublin
Professor Noel McCarthy, Professor of Population Health Medicine, Public Health & Primary Care, Dr. Judith Meehan, Assistant Professor, Paediatrics
Ireland is investing hugely in reform of acute and specialist paediatric services, and these are critically important for all children when severely ill and for children with longer term severe illness, and their families. However, this is accompanied by extraordinarily underdeveloped community paediatric services, where equivalent initiatives are lacking. Measurement of need and research to guide service development will be important to support the radical policy and implementation that is needed. Outside healthcare the gap in basic services for children is even more striking. Early years intervention through childcare can improve child and family health and social outcomes [http://www.ness.bbk.ac.uk/impact/ documents/RR067.pdf,doi:10.1920/wp.ifs.2022.4322]. In Ireland early years childcare is extremely poorly supported and regulated. A National Action Plan for Childminding 2021-2028 is addressing this. The long timeline echoes the scale of the challenges faced.
The EU Child Guarantee offers a framework for both mapping the areas of service that need to be addressed and monitoring progress against the targets within this guarantee. As well as service provision, direct interventions to reduce child poverty are critical for success. Although still shocking at 18%, the proportion of children in Ireland at risk of poverty or social exclusion is decreasing and lower than averages across the EU (Eurostat ILC_PEPS01). Even with increased national efforts supported by this EU framework major challenges are likely to emerge. Globally, childhood mortality and most physical indices have been improving steadily. Mental health in childhood and adolescence is in contrast disimproving substantially. This highlights the relative importance of childhood mental health for research, intervention and evaluation.
Future projected long-term impact of prioritising children
Organising our society around providing a physically and mentally healthy environment for our children, as prioritised in the EU Child Guarantee, is important of itself apart from any future benefits. However, it additionally offers the dividends for these children in the future of improved health and socially rich lives. Adverse childhood experiences contribute greatly to a range of health and social problems through adulthood as well as in childhood itself. These cost all of society alongside their direct impact on those suffering individually. Prioritising children, and in particular children at risk of adverse childhood experiences, also offers the potential to break intergenerational cycles of poverty and disadvantage.
Paediatrics- National Issues
Nationally and internationally paediatricians are represented by the Faculty of Paediatrics -the postgraduate training body for Paediatricians in Ireland. There are a number of issues which need prioritising and require strong clinical leadership. Paediatricians are leading in collaboration with colleagues in public health and general practice across a number of these areas: immunisation, tobacco and vaping legislation, obesity and sugar tax, alcohol and the public Health Alcohol Act (2018),direct provision and its detrimental effect on children, breastfeeding, effects of homelessness/inadequate housing on children and the effects of the Covid-19 pandemic on children.
59 Child & Family Population Health . Introduction to Child & Family Population Health at Trinity College Dublin .
.
Meehan
Professor Noel McCarthy
Dr. Judith
“
Measurement of need and research to guide service development will be important to support the radical policy and implementation that is needed.”
Trinity College Principal Child Health Research Investigators in Child & Family Population Health
Name of Researcher
Professor Gerard Boran, Consultant Chemical Pathologist Tallaght University Hospital/Clinical Professor, Trinity College Dublin
Dr Prakashini Banka-Cullen, School of Nursing & Midwifery
Professor Catherine Comiskey, Professor in Healthcare Modelling and Statistics, School of Nursing & Midwifery
Professor Imelda Coyne, Professor in Children’s Nursing & Co-Director of Trinity Research in Childhood Centre (TRiCC)
Dr Carmel Doyle, Head of intellectual Disability Nursing, School of Nursing & Midwifery
Dr Sara Dockrell, Assistant Professor (Physiotherapy), School of Medicine
Professor Basil Elnazir, Consultant in Paediatric Respiratory Medicine, School of Medicine
Dr Olive Healy, Associate Professor, School of Psychology
Dr Eleanor Hollywood, Associate Professor in Children’s Nursing, School of Nursing and Midwifery
Dr Mary Hughes, Associate Professor in Nursing, School of Nursing and Midwifery
Professor Rose Anne Kenny, Chair of Medical Gerontology, School of Medicine
Professor Richard Layte, Head of the Department of Sociology and a Research Professor at the Economic and Social Research Institute (ESRI)
Topic (s) of Study
Establishing normative ranges for biochemical measures: Celtic Ranges Study
Child Physical and Mental Health
Epidemiology and addiction from pregnancy to adulthood
Lifelong management of chronic conditions for adolescents and young people
Improving outcomes for children with intellectual disabilities and their families
Childhood symptomatic hypermobility: a move towards improved care pathways and targeted treatment
Respiratory Paediatrics
Behaviour analysis and learning
Child and family-focused research
Digital health and health and wellbeing in childhood chronic illness
The Irish Longitudinal Study on Ageing (TILDA)
Social Environment, Health and Well-Being Among Adolescents in Ireland
Professor Denise McDonald, Consultant Paediatrician, Tallaght University Hospital & LauraLynn, Ireland’s Children’s Hospice
Dr Gavin Murphy, Associate Professor at the School of Education
Severe Neurological Impairment in Ireland
Supporting student teachers to enhance LGBTQ+ inclusivity in secondary school communities
60 Child & Family Population Health . Trinity College Principal Child Health Research Investigators in Child & Family Population Health
Dr. Clodagh Nolan, Discipline of Occupational Therapy, School of Medicine
Professor Elizabeth Nixon, Professor Lina Zgaga, Professor Trevor Spratt; Professor Richard Layte.
Professor Anne C O’Connell, Head of Paediatric Dentistry, School of Dental Science
Professor Edna Roche, Professor in Paediatrics, Children’s Health Ireland, Tallaght University Hospital
Professor Trevor Spratt, AIB Professor in Childhood Research, Social Studies
Dr Samantha Smith, Senior Research Fellow, Centre for Health Policy & Management, School of Medicine
Dr Michelle Spirtos, Assistant Professor, Discipline of Occupational Therapy
Dr Katy Tobin, Assistant Professor in Biostatistics, Public Health & Primary Care Assistant Professor in Biostatistics
Dr Aoibhinn Walsh, General Paediatrician with special interest in Inclusion Health
Dr Fiona Wilson, Julia Wall, Discipline of Physiotherapy & Dr Bill Meehan, Micheli Center for Sports Injury Prevention and Harvard Medical School
Supporting Students with Disabilities in Higher Education
Growing up in Ireland
The impact of traumatic dental injuries and developmental defects of teeth on children and their parents
Childhood Diabetes
Life-course health and wellbeing
Children’s Palliative Care
Disability and Transitions to Adulthood
Foetal Alcohol Spectrum Disorders (FASD)
Equitable provision of paediatric care to children experiencing social adversity
Adolescent back pain in sport
61 Child & Family Population Health . Trinity College Principal Child Health Research Investigators in Child & Family Population Health
Growing up in Ireland
Professor Elizabeth Nixon (School of Psychology), Professor Lina Zgaga (School of Medicine), Professor Trevor Spratt (School of Social Work and Social Policy) and Professor Richard Layte (School of Sociology).
The Growing up in Ireland study is directed from within the Economic and Social Research Institute (ESRI) and led by Professor Emer Smyth, Research Professor at the ESRI.
Growing up in Ireland (GUI) is the first national study of children in Ireland and has been ongoing since 2006. This study has been following two groups of children and their families for nearly 15 years. One group comprises 8,568 families of 9-year-olds, subsequently followed at ages 13, 17, and 20 years. The second group comprises 11,132 families of 9-month olds; subsequently followed at ages 3, 5, 7, 9 years and 13 years. Growing Up in Ireland’s large portfolio of work serves to inform and shape Irish policy in relation to improving well-being and life chances of children growing up in Ireland.
Body mass index and sleep in five year olds
Professor Zgaga, Dr. Gail Nicolson and Professor Catherine Hayes, Associate Professor/Specialist in Public Health, Public Health and Primary Care have been investigating how sleep duration is related to body mass index (BMI) in five-year-olds. Data from the third wave of the infant cohort were analysed (n=7,432, children age 5 years). Fewer than 11 hours sleep in 24 hours was associated with 19% increased risk of being overweight/obese compared to those who slept for >11.5 hours. The strongest predictor of overweight/ obese was mothers’ BMI. These findings demonstrate that short sleep duration is associated with overweight/ obesity in five-year-olds.
Timing of puberty and mental health
Professor Nixon has been investigating how age of onset of puberty and quality of relationships with parents and peers predict stability and change in mental health outcomes across the transition to adolescence (9-13 years, n=7,400). Early maturing girls had poorer outcomes than girls who were either on time or late maturers (higher depressive scores and anti-social behaviour). Being an early maturer was not as clearly associated with boys’ mental health outcomes. However, the effect of pubertal timing was weakened for both boys and girls, once quality of relationships with parents and peers were considered.
An analysis of GUI datasets - GUI Alcohol and other Drugs Study
This is an analysis of childhood factors predicting drug and alcohol and other drug use in adolescents and young adults in the GUI cohort. It is led by Noel McCarthy, Professor of Population Health Medicine, Trinity College with colleagues bringing GUI analysis expertise (Elizabeth Nixon, Cathal McCrory, Associate Professor (Psychology) of Life Course Development and Ageing in the Department of Medical Gerontology, and Lina Zgaga) as well as addiction researchers (Dr Jo-Hanna Ivers, Associate Professor in Addiction Studies and Bobby Smyth, Clinical Professor, Public Health and Primary Care). The project is Health Research Board (HRB) funded and being conducted in collaboration with the HRB Drugs and Alcohol team.
62 Child & Family Population Health . Growing up in Ireland . Professor Elizabeth Nixon . Professor Lina Zgaga . Professor Trevor Sprat . Professor Richard Layte
“
Growing Up in Ireland’s large portfolio of work serves to inform and shape Irish policy in relation to improving well-being and life chances of children growing up in Ireland.”
The Irish Longitudinal Study on Ageing (TILDA)
Professor Rose Anne Kenny, Chair of Medical Gerontology, School of Medicine
The Irish LongituDinal Study on Ageing (TILDA) is a large-scale, nationally representative, longitudinal study on ageing in Ireland, the overarching aim of which is to make Ireland the best place in the world to grow old. Starting in 2009, TILDA recruited over 8,500 people aged 50 years and older and has returned to these same participants every two years since then. Through repeated comprehensive survey interviews and clinical health assessments, TILDA has documented all aspects of the lives of older adults including their health and well-being, behaviours, social activities, caring, and family lives. TILDA’s research informs the work of policymakers and public sector service planners as well as voluntary sector actors engaged in activities that seek to enhance the lives of older adults. TILDA’s large portfolio of work highlights the legacy of childhood experiences for health throughout the life-course.
Adverse Childhood Experiences (ACEs) and wellbeing in older age
TILDA is interested to learn how experiences in childhood continue to shape people’s lives into older age. In this project, the team examined whether resilience in adulthood mediates the association between Adverse Childhood Experiences (ACEs) and later life depression. The ACEs included in this analysis were: physical abuse, sexual abuse, parental alcohol or drug misuse, and poverty in childhood. We found that a history of ACEs before the age of 18 was associated with increased depressive symptoms and lower resilience in older age.
While higher resilience was associated with a decreased likelihood of late-life depressive symptoms, resilience did not protect against the association between ACEs and depression. These results show that later life depression is a possible outcome of early childhood trauma that may or may not be responsive to the protective influence of resilience. This project along with others in TILDA shows us that there are long term consequences of childhood experiences within the Irish context and the increased risk among affected individuals is independent of other risk factors for depression.
Exploring the impact of the childhood social environment on later life health
Individuals from more disadvantaged social backgrounds live fewer years on average compared with their more advantaged counterparts. They will live a larger proportion of their shorter lives with illness and disability. The social gradient in health is apparent in early infancy and extends through adolescence into adulthood and older ages, which implies that socio-economic position is a strong determinant of health across the life course.
TILDA’s research utilises other population-level data from prospective cohort studies including, Growing Up in Ireland (GUI) to explore how social adversity becomes embedded at the level of cellular and molecular biology to precipitate earlier ageing of those who are marginalised and disadvantaged.
Impact of early life adversity on later life health
An extensive evidence base suggests that early life adversity (ELA) is associated with increased risk of disease, disability, psychopathology, and premature mortality. TILDA’s research has shown that different types of adversity including poverty, parental loss, childhood abuse and maltreatment is associated with faster biological ageing as indexed using cellular and molecular markers of biological age acceleration including leukocyte telomere shortening and epigenetic clocks. TILDA’s current focus is on exploring whether childhood represents a critical period for the biological embedding of social exposures and the extent to which social mobility can ameliorate the impact of early life adversity on later life health.
The ALLOSTAT Project
Cumulative lifetime exposure to social, psychological and/or environmental stressors increases the risk of diseases in later life by disrupting the physiological regulatory systems that are involved with initiating, maintaining, and inhibiting the stress response leading to greater ‘wear and tear’ on the body, leaving it susceptible to disease (i.e. allostatic load). The ALLOSTAT project is designed to explore the panoply of factors contributing to social variation in Allostatic Load burden over the life course and examine the predictive utility of allostatic load for identifying emergent disease states, frailty, and mortality.
63 Child & Family Population Health . The Irish Longitudinal Study on Ageing
(TILDA) . Professor Rose Anne Kenny
“
TILDA’s large portfolio of work highlights the legacy of childhood experiences for health throughout the life-course.”
Respiratory Paediatrics
Professor
Basil Elnazir, Consultant in Paediatric Respiratory Medicine, Trinity College Dublin, School of Medicine
Professor Basil Elnazir is a Respiratory Paediatrician with research interest in Asthma and Cystic Fibrosis. He collaborates with National & International Groups looking into evolution of lung inflammation and real world studies in patient with asthma, cystic fibrosis and other paediatric respiratory conditions.
The Real World Clinical Outcomes with Novel Modulator Therapy Combinations in People with Cystic Fibrosis (RECOVER)
This project is a real-world non interventional study examining the impact of the new triple combination CFTR modulator compound, Kaftrio®, on clinical outcomes across ten paediatric and adult CF centres in the UK and Ireland in collaboration with the CF registry of Ireland and the UK. The team will be examining a wide range of well-established tests in these people, as well as some newer, more sensitive tests looking at how this new treatment might help the lung and abdominal problems in people with CF (PWCF). Researchers will explore how PWCF feel about this new treatment, how it affects their quality of life and whether it affects their need for - or ability to take - other CF treatments. Lastly the team will determine whether they can predict who will respond to this treatment by taking blood samples from PWCF, generating lung cells from these samples and testing medications on PWCF in the lab.
The SPACE (Severe Paediatric Asthma Collaborative in Europe)
This clinical research collaboration was launched by the European Respiratory Society (ERS) in 2015. The core project is the creation of a multicentre registry of paediatric patients with severe asthma. It was started on the initiative of the European Medicines Agency, which observed a lack of participation of children and adolescents with severe asthma in trials of biologics, leading to reduced access to these drugs for paediatric patients. Severe asthma differs in children and adults – including mechanisms, patterns of inflammation, and pathophysiology. Thus, we cannot automatically extrapolate clinical characteristics, phenotypes, quality of life or unmet needs from severe asthma in adults to children with apparently the same clinical disease

64 Child & Family Population Health . Respiratory
Paediatrics
. Professor Basil Elnazir
“
The long term expected impact is better understanding of medication impact, discovery of new diagnostic tools and therapies.”
Epidemiology and addiction from pregnancy to adulthood
 Professor Catherine Comiskey, Professor in Healthcare Modelling and Statistics, School of Nursing & Midwifery
Professor Catherine Comiskey, Professor in Healthcare Modelling and Statistics, School of Nursing & Midwifery
Professor Comiskey’s group explores epidemiology and addiction from infectious diseases to substance use in a range of settings, exploring these challenges across all stages of the child development framework, from pregnancy to adulthood.
Identifying and responding to drug and alcohol addiction from birth to young adulthood
This research covers the lifespan of the child from children born to parents who use substances to substance use of young adults. It builds upon ongoing work with practicing nurses, midwives, outreach workers and other healthcare professionals. It has developed in consultation with service users and their families a nurse led model of care. This research has culminated in a free Massive Open Online Course (MOOC) with global contributors illustrating through video, practical examples of brief interventions, assessment and responding to overdoses.
See https://www.futurelearn.com/courses/ identifying-and-responding-to-drug-andalcohol-addiction
Estimates of the hidden prevalence of COVID-19 among children and young people in the early stages of the epidemic
Asymptomatic cases of COVID-19 make the identification of the true numbers of positive cases more challenging and inhibits policy makers in their ongoing decisions on key topics such as mixing between age groups, school openings, and protecting older vulnerable communities in countries with low vaccination rates. Using a back-calculation model, we estimated the hidden prevalence of COVID-19 from late February 2020 to early January 2021. We found that the prevalence may be close to double the number which have tested positive for the virus.. There is need to tackle the transmission within this cohort as young people may act as a bridge to older cohorts, which remains a concern for communities with low vaccination coverage.
Alcohol use and alcohol-related harms: Exploring risk and protective factors among young people living in urban disadvantage
The study explores the risk and protective factors of alcohol use among 15–17-year-olds living in urban disadvantage, under the broad domains of healthrelated quality of life. Modelling predicted the relationship between physical well-being, psychological well-being, autonomy and parent relations, social supports and peers, school environment, leisure time activities and depression on the likely outcome of alcohol use, binge drinking and suffering alcohol-related harms. The results present a comprehensive platform to inform prevention and harm reduction strategies, addressing fundamental health inequities and risk and protective factors among young people living in urban disadvantage.
65 Child & Family Population Health . Epidemiology and addiction from pregnancy to adulthood
. Professor Catherine Comiskey
“
The long term expected impact of the work of Professor Comiskey and her team is actively contributing to practice development and policy change.”
large populations and exploring trends in disease incidence in different regions adds to our understanding of T1D.”
Childhood Diabetes
Professor Edna Roche, Professor in Paediatrics, Children’s Health Ireland, Tallaght University Hospital
Professor Edna Roche’s clinical research areas include Paediatric Diabetes and Endocrinology (rare syndromes, growth and development which underpin health in childhood and adult life) and Down syndrome. Amongst Professor Roche’s research achievements, she has developed the Irish Childhood Diabetes National Register, a major asset in diabetes care. She has extensive research collaborations nationally and internationally. She is a member of a number of important research networks including the Hvidoere International study group in diabetes, and EURODIAB.
Irish Childhood Diabetes National Register
Good diabetes management requires accurate disease data, previously unavailable in Ireland. Following a baseline study of national type 1 diabetes epidemiology, the Irish Childhood National Diabetes Register (ICDNR) was established to provide accurate diabetes data in children and young people in Ireland. Now in its 12th year, the database is governed by a highly skilled steering group, with a broad range of expertise (Medical, Nursing, IT, Statistics, Health Informatics). It has extensive collaborations: International (EURODIAB, NI Register, Hvidore, ISPAD) and national (Paediatricians, Diabetologists, RCPI, PCRS, HSE, Diabetes Ireland, and Technological University Dublin). These national data are crucial for health planning, resource allocation, enabling audit, research and optimising clinical care, as well as developing targeted interventions. Ongoing research includes prevalence modelling and forecasting in type 1 diabetes in collaboration with Professor Myra O'Regan, Department of Statistics and Computer Science. In addition, the ICDNR monitors national diabetic ketoacidosis rates to gain insight into factors associated with its development and prevention.
Monitoring and Preventing DKA
Diabetic ketoacidosis (DKA) is an avoidable severe life-threatening complication of T1D with significant morbidity and persisting long-term adverse effects on metabolic control. Poor metabolic (glycaemic) control is associated with diabetes related complications, such as amputation, kidney failure and blindness.
The Irish Childhood Diabetes National Register (ICDNR) is monitoring national DKA rates before and after a 2 year collaborative national DKA prevention campaign. In parallel the ICDNR seeks to gain insight into modifiable factors associated with the development of DKA to better guide its prevention. Analysis of the baseline data demonstrates a very high rate of DKA at diagnosis in those with T1D in Ireland.
The intervention phase is in progress with a broad based multicomponent communication strategy and health promotion campaign independently targeting healthcare professions, families of those with children, schools and the wider population. It includes print and radio campaigns and targeted campaigns directed at healthcare professionals with webinars, conference attendance and publications in the medical literature. A broad social media campaign is also in progress targeting young people, their families and the wider population.
International Diabetes Epidemiology
The ICDNR is a member of the EURODIAB collaboration since 2011, a network of 26 approved international local/regional diabetes registers which monitor trends in T1D epidemiology in children including Europe, North America and Israel.
Down Syndrome National Register
The National Register for Children with Down syndrome was established in 2015 to increase our knowledge of Down syndrome in Irish children with the aim of improving the quality of care and quality of life for children with DS and their families. The DS Register is governed by a Steering Group with a broad expertise and includes parent representation. The Register was hosted by Tallaght University Hospital.
66 Child & Family Population Health . Childhood Diabetes . Professor Edna Roche
Preventing DKA at diagnosis is the most important therapeutic target in new onset diabetes second only to preventing diabetes itself. Effective prevention requires an understanding of DKA at diabetes diagnosis and a measure of its frequency.
“
Monitoring diabetes epidemiology systematically across
“
Children’s Palliative Care
Dr Samantha Smith, Senior Research Fellow, Centre for Health Policy & Management, School of Medicine
Dr Samantha Smith’s main collaborators are Dr Joanne Balfe, Consultant Paediatrician in Neurodisability and Children's Palliative Care, Children's Health Ireland and LauraLynn, Ireland's Children's Hospice. Dr Peter May, Research Assistant Professor, Centre for Health Policy & Management, School of Medicine. Additional collaborators from the Children’s Palliative Care Strategic Advisory Group, Department of Health, PPI, King’s College London, St Vincent’s University Hospital, University College Dublin, National Office of Clinical Audit, Healthcare Pricing Office.
Improving Children's Palliative Care in Ireland (iCPCi): using evidence to guide and enhance palliative care for children with life-limiting conditions and their families

Children’s palliative care (CPC) can improve symptom control and quality of life for children with lifethreatening or life-limiting conditions (LLCs) and their families, potentially reduce hospitalisations, and increase the likelihood that children will die in their preferred location. In Ireland, although universal access to CPC is a national policy objective, there are concerns about inconsistent referral patterns, unmet needs, and lengthy hospital stays for children with LLCs, limited CPC workforce planning, and geographic inequalities in CPC supply.
These problems are consequences of substantial gaps in evidence needed to properly plan and deliver CPC in Ireland. The number of children with LLCs needing CPC in Ireland is unknown. Available estimates are based on English prevalence data despite documented concerns about cross-country differences, and are insufficiently detailed for service planning (e.g., demographic profile, stage of illness, complexity of need).
We don’t know how many children miss out on CPC referral because some clinicians view it as end-of-life care, or because LLC definitions change over time as prognoses improve. There are gaps in evidence on healthcare use by children with LLCs, and on geographic patterns of CPC supply.
This project will examine and discuss definitions of LLCs and CPC need using qualitative and quantitative methods. In addition, quantitative analytic techniques will be used to undertake needs assessment (profile of children with CPC needs), examine patterns of hospital use, and measure geographic equality/equity in CPC supply. The project team, comprising parents of children with LLCs, CPC policymakers, planners, providers, and researchers is well-placed to interpret and translate the findings into improvements in Irish CPC policy, planning and delivery, progressing towards the national goal of universal CPC.
The above project is phase one of a planned larger programme of work in children’s palliative care in Ireland. Further funding opportunities will be sought once the current project is well underway.
67 Child & Family Population Health .
Children’s Palliative Care . Dr Samantha Smith
We don’t know how many children miss out on CPC referral because some clinicians view it as end-of-life care, or because LLC definitions change over time as prognoses improve.”
Severe Neurological Impairment in Ireland
Professor Denise McDonald Consultant Paediatrician, Tallaght University Hospital & LauraLynn, Ireland's Children's Hospice, Dr Joanne Balfe, Consultant Paediatrician in Neurodisability and Children's Palliative Care, Children's Health Ireland
The Severe Neurological Impairment in Ireland research network (SPIRE) aims to advance understanding of children with Severe Neurological Impairment (SNI) with particular focus on the prevalence of SNI across Ireland, the healthcare utilisation of this group, and the collection of baseline data informed by international Delphi study consensus. We aim to inform a programme of healthcare delivery to children with SNI that is individualised, pro-active and responsive. The focus is on supporting care on an ambulatory basis and minimising hospital contact and inpatient stays. This will be achieved through better understanding the trajectory of care and using this understanding to anticipate and manage expectantly episodes of acute illness. Central to SPIRE is exploring parental experience and the involvement of parents as partners in research.
SPIRE- CONCEPT Severe neurological imPairment in IREland - CONsensus-based Clinical datasEt, Prevalence and healthcare uTilisation
CONCEPT, the first research phase under SPIRE, will examine prevalence of SNI in Ireland through national prevalence estimation and inpatient point prevalence studies. The development of an internationally agreed core “minimum” dataset for SNI will establish variables of importance when collecting baseline data as well as planning and conducting research in this area. Proposed uses of the consensus dataset include collaborative and comparative research outputs to advance understanding in key areas such as aetiologies (causation of a disease), healthcare utilisation and investigative processes, symptoms and morbidity, symptom management practices and medications, nutrition, trajectories of growth and factors associated with end-of-life care. Children fulfilling SNI criteria attending CHI hospitals will be invited to participate in the baseline data study. Wider public and parent input and involvement will be explored through a qualitative prioritisation survey and the establishment of a Family Faculty.
SPIRE-COPE Severe neurological imPairment in IREland: Carer or Parent Experience study
The SPIRE-COPE study will explore carer and parent experiences of parenting a child with Severe Neurological Impairment (SNI) through focus group research for the parents within our service. The aims of our exploration are threefold; we hope to understand the experiences of these parents better, we hope to identify ways in which we can develop our service for these families, and we hope to identify some important research questions related to SNI. Children with Severe Neurological Impairment and their families are a heterogeneous group. They are highly dependent on medical care, have cognitive impairment and their condition is often life-limiting. Parents and children typically engage with multiple services and the children require multiple medical technologies. Despite this, there is little research on understanding the family perspective when a child has SNI. We hope and foresee that taking part in the research will lead to real change and may be therapeutic for participants.
68 Child & Family Population Health . Severe Neurological
in
Impairment
Ireland . Professor Denise McDonald . Dr Joanne Balfe
“
We aim to inform a programme of healthcare delivery to children with SNI that is individualised, pro-active and responsive.”
Childhood symptomatic hypermobility: a move towards improved care pathways and targeted treatment
Dr Sara Dockrell, Assistant Professor (Physiotherapy), School of Medicine
The key direction of Sara Dockrell’s research is the investigation and promotion of musculoskeletal health and well-being in both children and student populations in education, and adults in the workplace, with an emphasis on ergonomics.
Childhood symptomatic hypermobility: a move towards improved care pathways and targeted treatment.
Joint hypermobility is the term used to describe the capability that a joint has to move beyond normal limits. Other terms used to describe this are joint laxity or double-jointedness. Children are more hypermobile than adults. For most children, their hypermobility causes no problems, and can be an advantage in some sports like gymnastics, or swimming. Symptomatic Hypermobility is a term used to describe the symptoms associated with joint hypermobility. Synonymous terms include hypermobile Ehlers Danlos Syndrome and Hypermobility Spectrum Disorders. Children and young people with symptomatic hypermobility frequently complain of pain in multiple joints and muscles which is often worse towards the end of the day or following activity. They may complain of fatigue or difficulties with functional tasks, which can limit their ability to participate in daily activities like attending school or doing sport and physical activity.

A range of gastrointestinal, cardiovascular, psychological, and urogenital characteristics are also reported to be associated with Symptomatic Hypermobility. However, varied terminology across different clinical settings makes clinical interpretation difficult in children and young people.
The diagnosis and management of children and young people with symptomatic hypermobility can be challenging. Currently, there is no consensus about how to effectively manage children and young people with joint hypermobility-related conditions. Chartered Physiotherapist Susan Ward is currently undertaking a PhD to explore: (i) the symptomatology of SH using a developmental framework; and (ii) the impact of symptomatic hypermobility on quality of life for the patients and their families. She also aims to develop a decision-making tool that could be used as part of an improved pathway for the management of patients with hypermobility-related conditions.
69 Child & Family Population Health
Childhood
.
symptomatic hypermobility: a move towards improved care pathways and targeted treatment . Dr Sara Dockrell
“
The long term expected impact is to improve the symptomatic hypermobility patient journey for children and young people from diagnosis to treatment.”
Adolescent back pain in sport
Dr. Fiona Wilson, Julia Wall, Discipline of Physiotherapy School of Medicine & Dr Bill Meehan, Micheli Center for Sports Injury Prevention and Harvard Medical School.
Fiona Wilson’s research aims to understand athletes’ pain and injury, to support their performance, welfare and safety in the short term, and their health and wellbeing through their life trajectory. This is done by exploring injury prevention, early recognition and optimal management strategies (injury treatment). Specific research focus is the role of sport and exercise on low back pain (LBP) by exploring: i) epidemiology to identify injury risk factors, and ii) biomechanics to explain mechanisms associated with risk and iii) knowledge translation (through evidence synthesis) for end users (clinicians, athletes and sport support staff).
Exploring adolescent back pain in sport; prevalence, risk factors, and athlete & clinician management strategies and experiences

Back pain is the most prevalent musculoskeletal condition. Most people will experience an episode in their life, and it has significant implications for the economy in terms of medical funding and time loss from work. The strongest risk factor for back pain is history of a previous episode. This means prevention strategies are aimed at reducing the risk of the first episode. Adolescent sport has adopted high performance approaches, meaning that junior athletes have never trained so hard at such volumes. This comes with risk of injury such as back pain and can mean that they can no longer compete in sport or even exercise and may then experience repeated episodes of disabling back pain into adulthood.
There has been a lack of research exploring adolescent sport-related back pain, meaning that our understanding is limited. This research programme aims to provide a comprehensive profile of this condition from a biopsychosocial experience. The programme partners with the globally respected Micheli Center for Sports Injury Prevention in Boston. Sackett’s model of evidence-based medicine has provided a framework for exploration. We have synthesised epidemiological data to define prevalence, incidence, and risk factors. Qualitative interviews have explored the athlete experience. A deep dive into a Boston-based patient registry and medical records has characterised clinical presentation and triage. Clinician experience, opinions, beliefs, and preferences for management will be explored through a comprehensive survey. Further planned research aims to explore a management intervention (RCT) based on findings of the profiling study. From this, a clinical treatment guideline and consensus statement will be created to reflect that published from this group in adult athlete back pain.
Child & Family Population Health . Adolescent
in
back pain
sport . Dr. Fiona Wilson . Julia Wall . Dr Bill Meehan
70 “
There has been a lack of research exploring adolescent sportrelated back pain, meaning that our understanding is limited.”
Foetal Alcohol Spectrum Disorders (FASD)
 Dr. Katy Tobin, Assistant Professor in Biostatistics, Public Health & Primary Care Assistant Professor in Biostatistics
Dr. Katy Tobin, Assistant Professor in Biostatistics, Public Health & Primary Care Assistant Professor in Biostatistics
Katy’s current research is focused on the impact of alcohol and substance use on brain health over the life course. Exposure to alcohol during the prenatal period can have lifelong detrimental effects on brain health. Current research explores these effects and looks at the prevalence of associated conditions, the needs and availability of services and supports for those affected.
FASDcare: Understanding the needs and caregiver burden among family caregivers of people with FASD in Ireland
Foetal Alcohol Spectrum Disorders (FASD) are a range of conditions that can occur following exposure to alcohol before birth. Prenatal alcohol exposure is the most common preventable cause of intellectual disability. It is predicted that Ireland has the third highest rate of FASD in the world. A majority of individuals with FASD are never diagnosed and they lack much needed support services.
The FASDcare study invited caregivers of children/young people living in Ireland with FASD to complete an anonymous online survey about their experiences. This study examines out-of-pocket spending related to FASD, the core difficulties experienced by caregivers and children/young people with FASD, the amount and type
of support needed and how much of these needs are currently met, the level of burden experienced by caregivers, and the pathway to diagnosis with FASD in Ireland.
This project aims to:
• Improve the supports available to families affected by FASD by generating information regarding access to services.
• Promote equitable access to healthcare services for children/young people living with FASD, and their caregivers.
This study is carried out in partnership with Alcohol Forum Ireland. ENDpae, a national support group for people affected by FASD also collaborated on the study.
71 Child & Family Population Health . Foetal Alcohol Spectrum Disorders
(FASD) . Dr. Katy Tobin
“
It is predicted that Ireland has the third highest rate of FASD in the world. A majority of individuals with FASD are never diagnosed and they lack much needed support services.”
Life-course health and wellbeing
Professor Trevor Spratt, AIB Professor in Childhood Research, Social Studies
My research interests are in four areas, international comparisons of child protection systems, examination of professional decision making in child protection, the effects of adversities experienced in childhood as realised across the life-course and the impact of services on the health and well-being of families receiving therapeutic services. With a background in social work practice and management before taking up positions in universities, I have a concern to undertake empirical research to address ‘real-world’ issues and develop partnerships with providers of services to measure impact in practice.
Data as evidence: Assessing impact of therapeutic services
A multi-disciplinary team of Trinity researchers are using standardised measures to assess impact of therapeutic services on families using a range of services, including family centres (for reasons of child welfare), early learning centres (to improve school readiness), and services to address domestic violence. The overall aim is to develop evidence informed practices with measurable impact on the lives of children and their parents.
The impact of adversities experienced in childhood on later life outcomes
A long standing project with a team of international researchers to carry out empirical research to explore the association between the experience of adversities in childhood and later adult outcomes, as measured by health and social circumstances. This project has also generated further research on the mechanisms by which such early experiences become embodied and reproduced.

72 Child & Family Population Health . Life-course health and wellbeing
. Professor Trevor Spratt
“
The long term expected impact is establishing an evidence base for therapeutic interventions to improve health and wellbeing outcomes.”
Lifelong management of chronic conditions for adolescents and young people
Professor Imelda Coyne, Professor in Children’s Nursing & Director of Trinity Research in Childhood Centre
The Child and Family Health Research group led by Professor Imelda Coyne has a substantial record of research in children’s nursing and child health across a variety of areas including the care of children and their families in acute and community care, child and adolescent mental health, school health and the organisation of models of care and health care services for children nationally and internationally. The research projects are characterised by innovative research methods, patient and public involvement, interdisciplinary and clinical collaborations, and strong relationships with healthcare providers and charities. The researchers include: Professor Imelda Coyne, Associate Professor Mary Hughes, Dr Colman Noctor, Dr Mary Quirke, Dr. Carmel Doyle, Thelma Begley, and Dr.Eleanor Hollywood.
Shared decision-making and family-centred care.
Professor Imelda Coyne leads on two areas of research internationally, shared decision-making and familycentred care. Her family-centred care research has transformed children’s nursing practice and collaboration with the New Children’s Hospital will lead to the development of an Irish model of care for children’s nursing. Professor Coyne’s research highlights that hospitalised children prefer to be involved in healthcare decisions (at a level of their choosing) and feel less anxious, and more prepared.
This new knowledge challenges the traditional view of children as vulnerable and needing protection from treatment discussions. Her expertise in innovative research techniques with children led to being PI on the research that underpins the Irish Government children’s policy framework Better Outcomes, Brighter Futures (2011) and the First 5 Early Years (2017). Imelda Coyne’s group have developed an App to help children aged 3-5 yrs interact in clinic consultations and are currently testing an intervention to promote adolescents with chronic conditions engagement in clinic encounters. Other research highlights includes development of e-health interventions to prepare adolescents and young people with chronic conditions for transition to adult healthcare services.
Professor Coyne’s specific interest is in how adolescents and young people are prepared for life-long management of chronic conditions. This has led to research studies on issues around autonomy, participatory preferences, decision-making,
self-management, and transition to adult services. This research has contributed to the development of a decision-making resources, a national policy on transition, and creation of a dedicated free eHealth resource (www.SteppingUp.ie ) to prepare adolescents for transition. This resource has won awards for co-design and best hospital project. Professor Coyne’s research has also contributed to the development of an app to enhance children’s participation in doctor-patient consultations.
Promoting Adolescent Communication and Education (PACE) diabetes study
Adolescence is a risky period for adolescents with Type 1 diabetes because of non-adherence to treatment, infrequent attendance and poor engagement at clinics, and poorly controlled blood sugars. Hence there is a real need for youth focused interventions to promote adolescents’ communication, engagement and selfadvocacy skills in encounters with their healthcare providers. This study is an RCT of an intervention (co-designed with adolescents and parents) to improve adolescents’ question-asking and encourage the doctors to provide more education during clinic visits. Adolescents’ views and preferences were central to the design and development of the intervention (video & question prompt list).
Your Opinion Matters: How to Make the Most Out of Talking to Health Care Providers
Self-management can lead to better health outcomes and a reduction in emergency room visits, unplanned
73 Child & Family Population Health . Lifelong management of chronic conditions for adolescents and young people
. Professor Imelda Coyne
“
Professor Coyne’s research highlights that hospitalised children prefer to be involved in healthcare decisions (at a level of their choosing).”
physician visits, and reduced risk of disability over time. Adolescents have reported several barriers to asking questions during office visits, including feeling intimidated, forgetting questions, and having parents dominate the conversation with the provider. In this project, Professor Coyne is collaborating with Professor Betsy Sleath, Director of the Child and Adolescent Health Program at the Sheps Center for Health Services Research, University of North Carolina, USA. The aim of this study is to: (a) develop and evaluate a brief ADHD question prompt list/video intervention for use by youth and parents during pre-visit wait time to empower them to be more actively involved during visits and (b) create a website with youth that provides tips and videos on how youth can raise issues and ask questions when talking to health care providers.
Young adults with a rheumatic diagnose; their experiences of participation in paediatric care and of the transition to adult care
In this project, Professor Coyne is collaborating with Dr Veronica Lundberg (PI), Professor Anncristine Fjellman-Wiklund, Professor Maria Wiklund from the Department of Community Medicine and Rehabilitation, Physiotherapy, and Dr K Hornberg from Department of Public Health and Clinical Medicine, Umeå University, Sweden.

HRB Irish Network for Children’s Clinical Trials (in4kids)
In this project, Professor Coyne is collaborating with Professor Geraldine Boylan (PI) University of Cork and Professor Eleanor Molly (Co-PI, Trinity College Dublin) and colleagues. The network aims to support researchers in Ireland to develop and deliver a portfolio of high quality clinical trials that will benefit children’s health. Clinical trials in children are more challenging than those in adults and the pool of eligible children for trials is often small, making collaboration crucial. Children must have at least the same rights as adults regarding access to high quality and evidence-based medications, interventions, and health care services. In4kids will build on existing national and EU investment and will work closely with the CRF infrastructure, CRCI, the HRB TMRN and the national PPI network, to build a sustainable clinical trial network that will support a portfolio of interventional research for children. The network will integrate a strong education and training programme, a young person’s advisory group providing a voice for children and a robust public engagement platform. The network will also work closely with Children’s Health Ireland (CHI) and the Paediatric Academic Health Science Network.
74 Child & Family Population Health
. Lifelong management of chronic conditions for adolescents and young people . Professor Imelda Coyne
Improving outcomes for children with intellectual disabilities and their families
 Dr Carmel Doyle, Head of intellectual Disability Nursing, School of Nursing & Midwifery
Dr Carmel Doyle, Head of intellectual Disability Nursing, School of Nursing & Midwifery
Dr Doyle leads a programme of research relating to children with intellectual disabilities. This integrates with associated work on complex care needs. She works with numerous national and international organisations and institutions and is a member of the first Working Group on Complex Care in the European Academy of Paediatrics.
Blended diet for enteral feeding for children with intellectual disabilities and complex health needs
Enteral feeding is commonly used in children with intellectual disabilities. Traditionally, sterile, readyto-use commercial feeds are the recommended method of enteral feeding. However, the use of blended diets –where home-made food is mixed to a smooth consistency – has been increasing, with parents preferring to use these to ensure more natural nutritional management and to control their child’s gastrointestinal symptoms. This research explores the feasibility of using blended feeds in this population. Dr Doyle is principal investigator on this project which is supported by the work of the Trinity Centre for Practice and Healthcare Innovation in the School of Nursing & Midwifery and is led by Dr Julia Louw. This research is in collaboration with Stewarts Care and the Trinity Centre for Practice and Healthcare Innovation.
The Patient's Experience of Nitrous Oxide for Sedation and Relief of Pain During Botulinum Toxin Injection Treatment for Muscle Spasticity in Children
The purpose of the research study is to explore the child’s experience of nitrous oxide for sedation and relief of pain during botulinum toxin injection treatment for muscle spasticity in children. Children attend the day ward for botulinum toxin injection treatment for muscle spasticity and routine data is gathered as part of the procedure. This information and a series of questions posed to the child and parents form the basis of this mixed method study on their experience. Dr Doyle is principal investigator on this research which includes Dr Sandra Fleming and Dr Karin O’Sullivan. This collaboration with CHI Tallaght University Hospital is supported by the work of the Trinity Centre for Practice and Healthcare Innovation in the School of Nursing & Midwifery and drives the development and implementation of evidence-based care in practice with nurses engaging in supported research.
75 Child & Family Population Health . Improving outcomes for
intellectual
children with
disabilities and their families . Dr Carmel Doyle
“
The long term expected impact is to build nursing research capacity in practice to support the development and implementation of quality changes that will improve outcomes for children and their families.”
Child and family focused research
Dr
Eleanor
Hollywood, Associate Professor in Children’s Nursing, School of Nursing and Midwifery
Eleanor leads on child and family focused research and has specific interest in understanding the experiences and needs of children who live with type 1 diabetes and children who have been exposed to domestic abuse and / or violence. More recently Eleanor’s research interests have expanded to the experiences of families who live in the International Protection Accommodation System (IPAS). She is currently principal investigator on a joint research project funded by Tusla and the Children’s Rights Alliance which is seeking to identify the needs of families who live in Direct Provision. She is also principal investigator on a Barnardos funded project entitled ‘An evaluation of the Barnardos Ballybeg playground service’ which is an evaluation of a weekend playground service designed for children who have adversity in their lives. Eleanor has a special interest in hearing the voice of children in research and creative participatory research techniques for school-aged children. She was also the recipient of the prestigious ‘Dean’s Research Initiative Fund’ from the Faculty of Health Sciences in 2022.
A case study of Meath Women’s Refuge and Support Services (MWRSS) children’s programme.
Domestic abuse and domestic violence have significant consequences for large numbers of – mostly - female victims, across the globe and children can be direct or indirect victims of this abuse, meaning children can experience abuse themselves at the hands of the perpetrator or that they can be witnesses of the abuse. Living in a home where there is domestic abuse and / or domestic violence can have a profoundly negative impact on a child’s development. At Meath Women’s Refuge and Support Services (MWRSS) the ‘Where I’m At’ programme is offered to children when they enter the refuge with their mother. The aim of this research is to conduct an evaluation of the programme and to establish what works best for children who have experienced or who have been exposed to domestic abuse and / or violence. The project’s objective is to make recommendations and to propose a best practice model of work with children in refuge in Ireland.
An evaluation of the Barnardos Ballybeg Playground Service
Children’s charity Barnardos delivers services, works with families, communities, and partners to transform the lives of children who have adversity in their lives. One such service provided by Barnardos is the Ballybeg Playground Service which has served the community of Ballybeg in Waterford since it opened in 1999. This supervised playground service caters for a variety of children aged between 4 and 12 years who may be experiencing adversity and trauma, be a member of the ethnic minority community, have special educational needs or neurodiversity/sensory or processing needs.
All children have the right to play as set out in Article 31 of the United Nations Convention on the Rights of the Child (UNCRC 1989).
Indeed, play is a very important activity for children since it helps children to make sense of the world around them, provides children with a means of expressing their feelings and also helps children to make sense of the relationships in their lives. The aim of this project is to evaluate the Barnardos Ballybeg Playground Service and to explore the impact of the service on the lives of the children and families who use the service.
School-aged children and the management of Type 1 Diabetes in the primary school environment: an investigation of how to support children, parents, and schools
Type 1 diabetes (T1D) is a common chronic medical condition that affects many children around the world. The successful management of T1D requires close monitoring of blood glucose levels, the administration of insulin and a fine balancing of insulin requirements with food intake and physical activity. Young children with T1D rely on their parents to manage their condition, until they are old enough to understand how to self-care. The reliance of young children on their parents for the management of their T1D poses challenges for parents of school-aged children. This research project seeks to investigate how children with T1D can be supported in the primary school environment, from the perspective of the child with T1D, and to inform schools and healthcare professionals regarding the needs of children with T1D while in school.
76 Child & Family Population Health . Child and family focused research . Dr Eleanor Hollywood
“
Play is a very important activity for children since it helps children to make sense of the world around them, provides children with a means of expressing their feelings.”
Joint research project on identifying integrated family support approaches for families living in the International Protection Accommodation System (IPAS)
According to statistics published by the International Protection Accommodation Service (IPAS) in January 2022, there are 45 International Protection (Direct Provision) accommodation centres nationwide and 24 emergency accommodation centres. At the beginning of 2022, more than one in four residents in these centres was a child, totalling 1,822 children, living with one or both parents. Previous research has identified a need for the development of tailored family support programmes with a view to providing support for parents as they adjust to living and parenting in a new context of the IPAS. Using case study research this project will explore the current family support practices that are available in the IPAS and examine and evaluate the training and support provided to staff working with families in the IPAS. This research will also explore and identify the needs of families (parents and children) in terms of parenting support and integration.

77 Child & Family Population Health . Child and family focused research
. Dr Eleanor Hollywood
“
The long term expected impact is to create a greater understanding of the health and well-being issues impacting children and families whilst empowering families to express their thoughts on matters affecting them and simultaneously ensuring that the voice of the child is heard during the research process.”
Digital Health & Health and wellbeing in childhood chronic illness
Dr Mary Hughes, Associate Professor in Nursing, School of Nursing and Midwifery
Professor Hughes leads on a programme of research on Health and Wellbeing in Childhood Chronic Illness and the development of digital health to enhance the quality of lives for these children. She has strong interprofessional research links in the voluntary sector, within the Health Service Executive, and the academic community. Professor Hughes is part of interprofessional research networks nationally and internationally.
What Good Digital Health Looks like in the new Regional Health Areas: A Scoping Review
This Health Service Executive project is undertaking a scoping review of the digital health of health services nationally and internationally to support the development of good digital health in the new Regional Health Authorities (RHA). This is the first phase in the national project to enhance digital health across the health service executive.
Scoping Review and Requirements Analysis for design and development of an Advanced Nurse Practitioner digital service initiative for children and young people who have hydrocephalus.
This study will develop a virtual Advanced Nurse Practitioner service for children who have hydrocephalus that will be compatible with the Electronic Health Record being developed for CHI. This is phase 1 of a PPI project that aims to enable children to receive care closer to home, while maintaining close contact with specialist services in CHI Temple Street through the interactive portal.
Gravitate-Health: Empowering and Equipping Europeans with health information for Active Personal Health Management and Adherence to Treatment
In a project led by Associate Professor Catherine McCabe, Professor Hughes is a collaborator on the Innovative Medicines Initiative (IMI)-funded Gravitate Health Project to develop a digital tool for patientcentred healthcare information to enhance adherence to treatment, safer use of medications, better health outcomes and quality of life. She is a member of the Trinity College team who are leading on the child health component in the area of complex care, and in the development of digital health KPIs for the project.
The role of public health nurses in child welfare and protection
Professor Hughes is work package lead on ONMSD (Office of the Nursing and Midwifery Services) funded Trinity Centre for Practice and Healthcare Innovation project with Public Health Nurses (PHNs) in CHO7 (Kildare/West Wicklow, Dublin West, Dublin South West areas) investigating the role of PHNs in child welfare and protection. This project is supporting the development of research skills among PHNs , by addressing a clinical need that has been raised by PHNs in the CHO area.
78 Child & Family Population Health . Digital Health & Health and wellbeing in childhood chronic illness . Dr Mary Hughes
“
The long term expected impact is to empower children and their families to be more actively involved in their healthcare through development of innovative service delivery systems, and through the development and use of digital technologies to enhance quality of life.”
Social Environment, Health and Well-Being Among Adolescents in Ireland
Professor Richard Layte, Head of the Department of Sociology and a Research Professor at the Economic and Social Research Institute
Professor Richard Layte’s work stems from a core interest in the structure of social and economic stratification in modern societies and its impact on individual life-chances, health and well-being. His research examines the fundamental processes which influence the distribution of health and well-being in societies and how these are shaped by political economy and the structure and functioning of health care systems. He has a particular interest in improving understanding of how family background influences child health and development and the impact this has on the child's educational outcomes, adult health and life expectancy. Recent work has examined whether the 'Great Recession' in Ireland had an effect on child health and development (the short answer is that it did in several very important ways), the pathways and mechanisms through which these effects occurred and the implications of this for life course models of health and well-being. He has a keen interest in the intersection of social, psychological and biological science and works with colleagues across a range of disciplines.
TeenPath: Social Environment, Health and Well-Being Among Adolescents in Ireland
A person's physical growth, psychological development and personal behaviours in adolescence are the foundation upon which the life course is built. Health behaviours established in adolescence continue into adulthood with long-term implications for health and life-expectancy. For example, 80% of teenagers measured as obese will remain obese as adults and so experience a substantially higher risk of disease later in life. Health and psychological development in adolescence can also have life-long consequences if they obstruct the person's acquisition of important skills and educational qualifications. Educational failure brings with it more unemployment, lower pay and a greater risk of experiencing poverty across the lifecourse, all of which are associated with worse psychological and physical health and well-being.
This project seeks to understand how family, neighbourhood environment and parental social and economic position interact with individual characteristics such as sex, personality and temperament to shape mental health, health behaviours and educational outcomes at the end of secondary schooling and the cusp of adulthood. We ask three inter-linked questions: 1) How do peer relationships and exposure to social media influence the risk of developing anxiety and depression?
2) How do family, neighbourhood and individual characteristics shape the development of health behaviours such as diet, exercise, smoking and alcohol consumption, and 3) Did the financial crisis and recession experienced in Ireland between 2008 and 2014 influence educational outcomes at the end of senior cycle and if so, how? The team will analyse large-scale, longitudinal data from two national cohort studies following child development from birth to 18 years. Research findings will provide evidence about what factors in the child's environment in childhood and adolescence are modifiable and so possible targets for changes in policy and practice.
79 Child & Family Population Health . Social Environment, Health and Well-Being Among Adolescents in Ireland . Professor Richard Layte
“
Health and psychological development in adolescence can also have life-long consequences if they obstruct the person's acquisition of important skills and educational qualifications.”
The impact of traumatic dental injuries and developmental defects of teeth
 Professor Anne C O’Connell, Head of Paediatric Dentistry, School of Dental Science
Professor Anne C O’Connell, Head of Paediatric Dentistry, School of Dental Science
The Paediatric dental team have 2 main threads for research.
1.Dental trauma affects approximately 25% of children and adolescents. Damage to or missing anterior teeth may have significant effects on the child’s psychological health as well as increased healthcare need throughout life. Prevention of traumatic dental injuries is a priority.
2. Defects in the development of the dentition will cause altered appearance and often limit appropriate function of teeth in the oral cavity. They also can have a major psychosocial impact on children and their families. The complexity of the needs of the individual children and support of the families means regular and intensive complex dental management through adolescence. While some defects are genetic in origin, some defects of unknown origin are now prevalent in the community (estimated at 6.8 % worldwide in a systematic review.
Compliance and level of protection afforded by mouthguards for children in GAA clubs.
Prevention of injury using personal protection in sport is essential. There is little data on the compliance with mouthguard wear and no data on the quality of devices used by children in contact sports. We are accessing children via GAA clubs and examining their dentition and assessing the quality of the mouthguards worn. Covid unfortunately interrupted the field work.
A game–based e-learning tool for Trauma
Due to the unpredictable nature of trauma, undergraduate (UG) students have limited exposure to emergency situations. We are developing an e-learning interactive tool to expose UG students to a variety of scenarios and will evaluate if the tool standardises and aids clinical knowledge and confidence in diagnosis.
Prevalence of HSPM
This research examines HSPM, (hypomineralised lesions on secondary primary molars), a dental defect in primary teeth in children (aged 4-6 years) and its association with future development of MIH (dental defect in permanent teeth in children (aged 7-9 years)). Presence of these defects significantly increases treatment need and can lead to increased disease levels in some children. Experience of pain, loss of school time and cost of dental treatment can have an impact on future dental experiences. Prevalence in Ireland has not been estimated. Access, for research purposes, to the appropriate age children is organised via national schools. 90 children were examined before COVID interrupted field work. The oral examination highlighted high presence of defects as well as unmet treatment need. Work will continue once schools are in a position to accommodate the examinations.
80 Child & Family Population Health .
The impact of traumatic dental injuries and developmental defects of teeth . Professor Anne C O’Connell
“
Prevention of tooth injury and early recognition of dental effects should minimise the adverse impact of both trauma and developmental defects on children and their families.”
Behaviour analysis and learning
Dr. Olive Healy, Associate Professor, School of Psychology
Dr Olive Healy designs and conducts research in community and clinical settings that aims to increase our understanding of how children with complex needs learn and how they change across developmental spans. She has a particular interest in the application of findings to neurodevelopmental disabilities conducting research that addresses behavioural intervention, health care and accelerating learning by engaging in a fully integrated approach linking basic and clinical research. She investigates human contingency learning, avoidance and generalisation in fear conditioning, assistive technology and instructional design in education informed by behaviour analytic research.
InterAcT- Accomplish & Thrive
This project aims to improve life experiences for autistic children and those with an intellectual or developmental disability through assistive technology solutions. With Dr. Rhona Dempsey (co-founder),the team has designed a mobile application employing psychosocial behavioural interventions that can be used to ease stress and reduce fearful responding that impacts quality of life. They are developing this app further to investigate threat value as a stimulus feature and the transfer of responding that can occur between stimuli sharing this feature. This will further inform the technology on personalised solutions for avoidance action for example.
Instructional Design for Literacy
Dr Healy leads a suite of research programmes that aim to translate knowledge derived from the scientific study of reading instruction, based on the principles of behavioural science, into special education practice. Children with intellectual and developmental disabilities (IDD) frequently experience significant delays in reading development, and many do not progress in the acquisition of functional reading skills. This group investigates methods of instructional design that can accelerate reading outcomes and subsequent effects on social-emotional difficulties in childhood and adolescence.
Early Intervention: NDBI
With colleagues at Al Jalila Children’s Specialty Hospital UAE, Dr Healy is investigating how caregiverimplemented naturalistic developmental behavioural interventions (NDBIs) for toddlers at risk for autism can be evaluated. Using pragmatic evaluations this project aims to build scalable and sustainable early intervention solutions individualising elements of intervention that may need to be adapted or modified to increase contextual fit with settings.
Implementation and Dissemination Science
This research stream provides an analytical framework of science communication to bridge the gap between behaviour analysis findings and the public, including education, health and social care sectors as well as stakeholders themselves.
81 Child & Family Population Health . Behaviour analysis and learning . Dr. Olive Healy
“
The long term expected impact is to improve lifelong learning in intellectual and developmental disabilities; Dissemination of evidence informed effective practices to increase early intervention services.”
Supporting student teachers to enhance LGBTQ+ inclusivity
 Dr Gavin Murphy, School of Education
Dr Gavin Murphy, School of Education
My research expertise in teacher education and educational policy connected to in/ ex-clusion, (in)equity and diversity – specific to that of the educational and personal experiences of LGBTQ+ school community members – has spanned a number of projects and initiatives in recent years, funded by both the Department of Children, Equality, Disability, Integration and Youth Affairs, and the Department of Justice. I have organised webinars in this area with eminent (inter)national researchers for both research and practice communities, collaborated with national leaders in this area and a number of colleagues in national higher education institutions to disseminate and embed the work, created multimodal resources, presented and published on implementations of innovations, and worked with Master of Education students in this area.
Capacity Building for LGBTI+ Inclusion in Teacher & School Leaders’ Education
This research project leverages the collective (i) LGBTI+ Youth Strategy (ii) Wellbeing Policy Statement and Framework for Practice and (iii) the Sustainable Development Goals policy contexts and the research available - both internationally and nationally - about the sustained challenges experienced by LGBTQ+ school community members, most notably children and young people, including their wellbeing. In collaborative partnership with ShoutOut, the research project focuses on empowering student teachers to learn about and positively impact outcomes in school communities related to LGBTQ+ inclusivity and school curriculum in the broadest of senses, including cognitive, social and emotional emphases. ShoutOut promotes inclusion through education by delivering LGBTQ+ Educational Programmes in schools, workplaces and service providers.
QUEER(Y)ING: Asking questions of teacher and school leader education for LGBTI+ youth and schooling
This project mapped the provision of formal and informal evidence-based education through teacher and school leader education provision nationally. Its aims were: 1) to assist in the promotion of LGBTI+ inclusive schools and society; 2) to have equal, fair and just educational experiences for the LGBTI+ community in all schools; and 3) to realise Ireland's inclusive education policy context through professional learning opportunities, including the generation of a website for this purpose from an LGBTI+ perspective. It was a government-funded project and is connected to the National LGBTI+ Youth Strategy. This project is in collaboration with Dr Declan Fahie, School of Education, University College Dublin. The final project website is available at www.queerying.ie
82 Child & Family Population Health . Supporting student
teachers to enhance LGBTQ+ inclusivity . Dr Gavin Murphy
“
The research project focuses on empowering student teachers to learn about and positively impact outcomes in school communities related to LGBTQ+ inclusivity and school curriculum in the broadest of senses.”
Establishing normative ranges for biochemical measures
Professor Gerard Boran, Consultant Chemical Pathologist Tallaght University Hospital/ Clinical Professor Trinity College
Professor Gerard Boran leads several laboratory medicine projects relevant to paediatrics. The CELTIC Ranges project is establishing normative values in Irish children for widely used laboratory medicine investigations.
CELTIC Ranges Project
This collaborative project is establishing improved normative ranges for Irish Children and young people across a wide variety of biochemical and haematological measures including thyroid function, kidney, liver and bone health, diabetes and lipid levels, haematinics and vitamin D status. Basic anthropometric data is also being collected for correlation with the laboratory findings.
Currently used normal ranges, such as in thyroid disease may be based on very small numbers and so of reduced reliability. Over 1,000 children and their families living in Tallaght and South Dublin have already volunteered. The project team includes lead scientist Dr Ann Leonard and a panel of collaborators including Professors Eleanor Molloy, Edna Roche, Ciara Mc Donnell, Drs Johnny Mc Hugh and Turlough Bolger, and Ms Jacinta Greene (Nutrition & Dietetics).
This study will enhance the clinical care of children and avoid unnecessary investigation by providing a more relevant and appropriate reference interval for commonly used investigations in childhood. The results will also benefit paediatric laboratory medicine services around the country and will contribute to better knowledge of the metabolic health of Irish children.
Ferrtest Project
The DTIF-funded FerrTest project at Trinity College is developing a novel point-of-care blood test for ferritin levels (ferritin is a blood protein that contains iron). This will improve the detection and subsequent treatment of iron-deficiency anaemia in many settings around the world, including children and in pregnancy.

83 Child & Family Population Health . Establishing normative ranges for biochemical measures
. Professor Gerard Boran
“
This study will enhance the clinical care of children and avoid unnecessary investigation by providing a more relevant and appropriate reference interval for commonly used investigations in childhood.”
Supporting function in children and young people
Dr Michelle Spirtos, Assistant Professor, Discipline of Occupational Therapy, School of Medicine, Dr Katie Cremin, Assistant Professor, Discipline of Occupational Therapy, School of Medicine
The Disability and Transitions to Adulthood Research Team is developing and researching programmes and resources to support young people with disability experiences in preparing for life as adults. Young people with physical and sensory impairments report receiving disability focused medical and support services in childhood and adolescence, but an absence of support related to the challenges of negotiating impending transitions to adult life with a disability in their social, educational and work lives (Spirtos and Gilligan, 2022).
Supporting Transitions to Adulthood Resources (STAR) project
The disability and transitions to adulthood research team is developing resources to support young people with disabilities in preparing for life as adults. The early stages of the project have focused specifically on young people with cerebral palsy. The current stage of the project is now collaborating with other organisations and is related to young people with physical and sensory impairments. The project team has a range of stakeholders influencing and collaborating on the project including members of different disciplines, service providers and adults with disability experience.
Assessment and diagnosis of handwriting disorders in children (JOT) Project
Handwriting difficulties have considerable impact on the educational attainment potential of children with disabilities and form a significant part of occupational therapy practice with children. This research project is examining the assessment and diagnosis of handwriting disorders in children and the current stage of the project involved gaining consensus from expert occupational therapy practitioners and the development of a practice framework. Future research will be on testing the implementation of these guidelines on clinical paediatric populations.
Mobility assistance dogs and the impact on activity levels, gait patterns, balance and quality of life in children with cerebral palsy and neurological impairments.
Children with cerebral palsy and neurological impairments frequently demonstrate decreased walking ability which is influenced by altered muscle tone and
decreased balance and motor co-ordination. The use of assistance dogs traditionally used to assist in functional independence are now being used to provide external guidance and support during ambulation both in adults and in children, however, there is a paucity of evidence to support their use. The purpose of this study is to explore the effect of mobility assistance dogs on activity levels, gait patterns, balance, lower limb strength and quality of life in children with cerebral palsy and neurological impairments.
Complex Trauma in childhood: Informing
Occupational Therapy Practice (COTIC Project)
Complex trauma in children results from repeated or prolonged exposure to traumatic events and adversity during childhood. Children with experience of complex trauma can require multidisciplinary intervention due to the consequential impact on developmental skill acquisition, functional performance and areas such as engagement in education. Occupational therapists are working in children’s services including Children’s Disability Network Teams and there is limited guidance for how the specific needs of children with experience of complex trauma can be addressed. This current phase of this project is examining the state of practice. The next phase will involve an international Delphi consensus method to develop a guidance document for practice.
Prenatal predictors across biopsychosocial levels of birth outcomes, sensorimotor development and mental health in childhood
Due to the wide variability in how prenatal risks (encompassing preconception) are conceptualised to
84 Child & Family Population Health . Supporting function in children and young people
. Dr Michelle Spirtos . Dr Katie Cremin
“
The long term expected impact is to make transformative impact on transition experiences of young people with disabilities and models of service provision.”
date, it is not explicit what types of risks (biological, psychological or social) and the potential cumulative effect of risks have on specific developmental outcomes. Using large cohort data sets, this study seeks to quantify prenatal risks across biopsychosocial domains both independently, cumulatively and domain specific, examining their influence on 1) specific adverse birth outcomes (e.g. gestational age, birthweight, mode of delivery and neonatal complications), 2) sensory regulation behaviour trajectories in infancy, 3) fine and gross motor trajectories in early childhood and 4) mental health trajectories in middle/late childhood. Moderators such as infant sex, post-natal chronic sociodemographic stress (CSS), activity engagement and special educational needs (SEN) will also be considered. Protective factors such as social support will also be examined. A predictive model will be developed to identify children at-risk of lower developmental outcomes based on early life experiences.
Investigating potential benefits of weighted sleeper pillows for children with mild sensory-related sleep challenges
Sleep is essential to daytime performance for all children. Non-pharmacological aids to children’s sleep are not well researched. There is anecdotal evidence for weighted blankets being effective in helping children sleep. Weighted products use children’s sensory processing needs to enable calm and comfort. This study aimed to look at the potential of the Siest Sleeper Wishbone pillow in improving children’s sleep. The focus was on sleep latency, sleep quality and sleep associations of participants.
This was a small pilot study and utilised questionnaires, sleep diaries and qualitative feedback to analyse the participants’ sleep and the impact of the Siest Sleeper. No sleep restriction therapy was used during this pilot. In addition, bedtime and wakening times patterns were not directed or controlled. Findings were positive with improved sleep latency, fewer night wakenings and positive sleep associations. It is intended to further research the value of weighted sleepers with more diverse sleep challenges in children and to also understand the relationship of sensory processing to sleep in children.
The relationship between motor ability and the development of self-care skills in preschool children
The primary aim of this project is to explore the relationship between developing motor ability in pre-school children and their self-care skills. Motor skill development plays an essential role in enhancing self-care skills among children. Motor skills and ability are integral to a child’s ability to participate in self-care skills (Clark & Kingsley, 2020). How children are supported to develop self-care skills and acquire the necessary motor skills to carry out many self-care activities such as feeding, dressing and toileting within education and home environments is poorly understood. This project aims to understand the parallel development of motor and self-care skills for preschool children in Malaysia and develop an intervention module for children, their teachers and caregivers which will support the development of self-care skills through developmental motor activity and activity analysis.

85 Child & Family Population Health . Supporting function
in
children and young people . Dr Michelle Spirtos . Dr Katie Cremin
“
A predictive model which identifies children at risk of lower developmental outcomes can contribute significantly to resource allocation and programme development to support the developmental trajectories of high-risk children.”
The goal of this collaborative research team is to bring together experts from occupational therapy and specialist professionals in this area to advance neonatal interventions for infants and families.”
Neonatal interventions for infants and families
 Dr Michelle Spirtos, Discipline of Occupational Therapy, School of Medicine
Dr Michelle Spirtos, Discipline of Occupational Therapy, School of Medicine
Occupational therapy in neonatal units of maternity hospitals is now part of international practice with occupational therapists making a significant contribution to the care of preterm and high-risk infants. The goal of this collaborative research team is to bring together experts from occupational therapy and specialist professionals in this area to advance neonatal interventions for infants and families. It also has a specific focus on occupational therapy development in neonatal units in Ireland.
Irish Neonatal Care Occupational Therapy Study (INCOT Study): The Development of an Occupational Therapy Intervention for Neonatal Units in Ireland
Although an established practice internationallyincluding the UK and the US - neonatal occupational therapy has not been a part of routine services in maternity hospitals in Ireland. While there is some empirical evidence for specific components of occupational therapy intervention there is a significant lack of empirical research examining occupational therapy programmes in neonatal units. This study is examining the current developmental care practices in neonatal units in Ireland, and piloting an occupational therapy intervention in the neonatal unit in The Coombe Women’s Hospital.
The contribution of occupational therapy theories and frameworks in supporting critical reasoning for occupational therapists working in neonatal settings.
The overall aim of this international collaboration is to develop occupational therapy practice frameworks, interventions and specific outcome measures to influence and inform interventions to high-risk infants and their families. The primary aim of this phase of the project is to explore how occupational therapy theories and frameworks are used in occupational therapy practice with high-risk infants and their families within neonatal settings. This is critical in ensuring that developing practice maximises the impact of occupational therapy with both the infant and the family.
86 Child & Family Population Health .
Neonatal interventions for infants and families . Dr Michelle Spirtos
“
Supporting Students with Disabilities in Higher Education
Dr. Clodagh Nolan, Discipline of Occupational Therapy, School of Medicine
Dr Nolan is the founder of the ‘Unilink Approach’ to supporting students with mental health difficulties and hidden disabilities in Higher Education. Disabled students are viewed as having unique abilities and experiences.
The research:
• Explores the impact of their mental health difficulties and disabilities on the student lives using the ‘Trinity Student Occupational Performance Profile’
• Enables us to establish the issues facing disabled students in higher education and build tools such as the ‘Unilink Self-Management Programme’, for the self-management of their student role.
• Examines the pathways in and out of university for those on the autistic spectrum.
Refining the Psychometric Properties of the Trinity Student Occupational Performance Profile (TSOPP) – A selfreport measure of occupational performance difficulties within the student role
Transitioning to higher education requires students to make academic, social, and personal adjustments as they navigate institutional environments which have an impact upon their occupational performance (Baker and Siryk, 1984; Keptner and Rogers, 2018)). Occupational performance difficulties can include difficulties with social-related occupations, time management, academic-related occupations, sleep, managing stress and managing money (Keptner and Rogers, 2018). The transition to higher education may be accompanied by additional difficulties for students with disabilities such as mental health difficulties (Storrie, Ahern and Tuckett, 2010) including autism spectrum disorder (ASD; Nuske et al., 2019) and attention deficit hyperactivity disorder (ADHD; Jansen et al., 2017).
There has been a call for a robust tool that could measure and capture the difficulties in occupational performance (Keptner 2018) and the Trinity Student Performance Profile (TSOPP) which is a self-report measure of a student’s occupational performance fits this call (Nolan, 2011; Lombard, Nolan & Heron, 2022). This study aims to refine the psychometric properties of the TSOPP.
The TCD Sense Project and Sensory App
Dr Clodagh Nolan has been involved in research to gather the views of disabled students to enhance our understanding of their experiences of college environments. This research has informed the development of the TCD ‘Sense Project’ which aims to make Trinity more inclusive, by examining, and creating different sensory environments to meet the needs of students and staff who experience barriers to managing and adapting the sensory aspects of college.
The Sensory App Project is a collaboration between Trinity College (Discipline of Occupational Therapy and Trinity College Disability Services) and TU Dublin to build an online tool to enable disabled students to assess their environmental spaces from a sensory perspective using an adaptative version of Winnie Dunn’s Ecological Assessment of Sensory Processing Features of the Context which is a part of the Sensory Profile 2 Family of Assessments (2014).
Uni-Link Self-Management Tool (2021)
The Unilink Self-Management Tool (Lewis & Nolan, 2021) has been developed from research with disabled students over a five-year period. This tool enables students to develop skills and strategies to self-manage their mental health within a college environment. Each of these projects have several stakeholders influencing and collaborating on the projects.
87 Child & Family Population Health . Supporting Students with Disabilities in Higher Education . Dr.
Clodagh Nolan
“
This tool enables students to develop skills and strategies to self-manage their mental health within a college environment.”
Equitable provision of paediatric care to children experiencing social adversity
Dr Aoibhinn Walsh, General Paediatrician with special interest in Inclusion Health General Paediatrics, Children’s Health Ireland at Temple Street
Paediatric Inclusion Health (PIH) aims to identify and overcome barriers towards equitable healthcare access for children at risk of social exclusion within the Irish healthcare system. Adverse social determinants of health (SDH) contribute to higher rates of illness and increased complexities in accessing healthcare with profound impacts on long term health and development. The Lynn clinic was established as a community outreach clinic for children experiencing social adversity to better understand the needs of marginalised children and families when accessing and engaging with healthcare and to adapt our clinical practice to reflect that. The Lynn Clinic is the first of its kind in Ireland and has already shed much needed light on important health and social metrics for children experiencing social adversity
The Lynn Clinic: Equitable provision of Paediatric care to children experiencing social adversity
Knowledge of social determinants of health (SDH) and the barriers that exist to accessible healthcare and successful healthcare provision are key skills in adapting our existing infrastructure to accommodate the needs of children from disadvantaged backgrounds (for example: children who are homeless, children from the Roma and Irish Traveller communities, international protection applicants, refugees and undocumented migrants). To ascertain population needs whilst appreciating diversity of these needs, The Lynn Clinic, a community outreach clinic for children experiencing social adversity was founded in 2020. The aim is to prove the efficacy and efficiency of this model of care in improving patient outcomes.
To achieve this the following is taking place:
1. Collecting and quantifying demographic data e.g. vaccination uptake, primary care infrastructure (Medical Card, GP etc), housing situation, language and literacy barriers, migration status (when applicable).
2. Identify specific health presentations where SDH have a clear impact on outcome and create adapted guidelines to facilitate optimal management e.g. faltering growth in emergency accommodation with no cooking facilities.
3. Delve deeper into lived experience of social adversity and healthcare SDH by performing semi-structured interviews with families/caregivers, patients, and community health and social care professionals (HSPCs).
4. Development of pictorial aids and accessible, understandable (e.g. translated) resources to overcome language and literacy barriers to improve health literacy and adherence and measure their feasibility and acceptability within different cultural and ethnic backgrounds.
5. Establishing strong links between hospitals, community health and social care professionals (HSCPs) and non-governmental organisations to create clear integrated-care pathways is fundamental to effective PIH service delivery and will assist with the creation of reproducible frameworks for tailored care designed to overcome barriers to healthcare access through what can be a complex system of supports.
88 Child & Family Population Health . Equitable provision of paediatric care to children experiencing social adversity . Dr Aoibhinn Walsh
“
We want to demonstrate that this model of care is an effective and efficient use of hospital resources, resulting in improved patient outcomes with the evidence to inform local and national policies that impact children experiencing social adversity.”
Child Physical and Mental Health
Dr Prakashini Banka-Cullen,
School of Nursing & Midwifery
Research areas include working with vulnerable populations, child physical and mental health, and addiction.
A case study of the needs of families living in the International Protection Accommodation System (IPAS)
The aim of this project is to identify the needs of families living in the International Protection Accommodation System (IPAS) in Ireland and to propose an integrated family support approach that will support the individual needs of these families.

The specific objectives are:
• To explore the current family support practices and establish what is currently working well for families living in IPAS.
• To examine and evaluate the training and support provided to staff working with families in IPAS and to identify any gaps that may exist in relation to
interagency work supporting refugee families.
• To explore and identify the needs of families living in IPAS in terms of parenting support, integration, prevention and early intervention and family support.
• To consult with relevant stakeholders to identify what approaches are currently working well for families living in IPAS.
All data collection methods among children have been informed by the Lundy Model of Child Participation and incorporate its four elements: space, voice, audience, and influence (Lundy 2007). The model provides a way of conceptualising a child ‘s right to participation as laid down in Article 12 of the United Nations Convention on the Rights of the Child (UNCRC 1992).
89 Child & Family Population Health . Child Physical and Mental Health . Dr Prakashini Banka-Cullen
“
The long term expected impact is to integrate a family support approach that will support the individual needs of families.”

Immunology and Infection
Trinity College Principal Investigators in Immunology and Infection
Infection and Inflammation in early childhood
• Professor Eleanor Molloy, Professor of Paediatrics & Child Health, School of Medicine
• Preterms
• Gender, neonatal inflammation and preterm outcomes (GENIE)
• Preterm infant immunomodulation to treat sepsis and brain injury prevention (PLATYPUS)
• Sustained inflammation in preterm infants and long term outcomes (STARFISH)
• Complex needs studies: Down syndrome
• Down syndrome, Immunodeficiencies and Systemic Responses (DINOSAUR)
• SARS-CoV-2 virus infections in children
• Understanding neonatal and child immune responses to SARS-CoV-2 virus (CONTINUUM)
Potential therapies for atopic dermatitis in babies and children
• Professor Alan Irvine, Professor in Dermatology, Consultant Dermatologist
• Skin barrier function in atopic dermatitis
• Innate immune Regulation of Skin Barrier Function in Childhood Atopic Dermatitis.
• Host pathogen Interactions in Atopic Dermatitis
Childhood Allergy
• Professor David Coghlan, Consultant Paediatrician, Children’s Health Ireland (CHI), Tallaght
• The SAD study ( The On the Spot Allergy Delabelling study)
• New diagnostic techniques
Paediatric Tuberculosis Immunology
• Dr Cilian Ó Maoldomhnaigh, Dr Sharee Basdeo, Professor Joseph Keane Dept Clinical Medicine, Trinity Translational Medicine Institute (TTMI)
• Targeting immunometabolism to protect against childhood mortality from tuberculosis (TB)
Allergy in children
• Dr Aideen Byrne, Consultant in Paediatric Allergy, Clinical Senior Lecturer , School of Medicine
• Early introduction of food allergens
• Accidental food allergic reactions
Immune responses in children and new born babies
• Dr Sarah Doyle, Associate Professor in Immunology (Clinical Medicine)
• Young human innate immune response
• Innate immune Regulation of Skin Barrier Function in Childhood Atopic Dermatitis
• Genetic predisposition to coronary artery aneurysm formation in children with Kawasaki Disease
91
Immunology and Infection . Contents
94 96 97 98 99 100 101
Better adjuvants for paediatric vaccines
• Dr Sarah Doyle, Associate Professor in Immunology, Clinical Medicine (PI), Dr Kiva Brennan (Senior Research Fellow)
• Improving neonatal responses to current paediatric vaccines
Immunological responses to Staphylococcus aureus in paediatric atopic dermatitis
• Professor Rachel McLoughlin, Professor of Immunology, School of Biochemistry & Immunology, Trinity Biomedical Sciences Institute (TBSI)
• Identification of T cell profiles associated with Staphylococcus aureus flares in paediatric atopic dermatitis
Immunity to Infection, including paediatric infections
• Prof Kingston Mills, Professor of Experimental Immunology, School of Biochemistry and Immunology and Academic director TBSI.
• Understanding the role of T cells in sustained protective immunity to Bordetella pertussis to inform the design of third generation vaccines against pertussis
• PERtussIS COrrelates of Protection Europe (PERISCOPE)
Understanding the pathogenesis of paediatric Inflammatory Bowel Disease
• Professor Patrick Walsh, Associate Professor (Clinical Medicine)
• Identifying the mechanism of action of a novel therapeutic target during the earliest phases of IBD onset in childhood
Paediatric Rheumatology Research
• Professor Orla Killeen, Dr Emma McDermott, Professor Ursula Fearon. National Centre for Paediatric Rheumatology
• Distinct pathogenic mechanisms in Downs Arthritis (DA) and Juvenile Idiopathic Arthritis (JIA)
• Whole exome mapping of genetic variants linked with the development of chronic recurrent multifocal osteomyelitis (CRMO).
• Family Resilience and Adaptive Coping in Children with Juvenile Idiopathic Arthritis (JIA)
• Developing a UK/ROI study of the incidence of JSLE in children and young people and their access to care: a collaborative approach.
Investigating the immune evasion mechanisms of Viruses
• Professor Nigel Stevenson, Viral Immunology Group, School of Biochemistry and Immunology, Trinity Biomedical Sciences Institute (TBSI)
• Respiratory Syncytial Virus (RSV) in children
• Towards a Cure for COVID-19
Paediatric Laryngeal fibrotic disease
• Professor John Russell, Paediatric Otolaryngology CHI (Crumlin) & Discipline of Paediatrics
• Investigation into prevention of fibrotic scar formation as treatment for subglottic stenosis
92
Immunology and Infection . Contents 102 103 104 105 106 107 108
How is information stored in the brain?
• Dr. Tomás Ryan, Associate Professor, School of Biochemistry and Immunology, Principal Investigator, Trinity College Institute of Neuroscience
• Disorders of memory range from conditions of transience
Airway microbiome in young children with cystic fibrosis
• Dr Julie Renwick, Assistant Professor, Clinical Microbiology
• Airway Microbiome in Cystic Fibrosis (AIM-CF)
Harnessing innate T cells for the treatment of disease
• Professor Derek G. Doherty, Professor in Immunology, School of Medicine, Trinity Translational Medicine Institute, St. James’s Hospital, Dublin.
• Analysis of innate T cell reconstitution after allogeneic stem cell transplantation and CAR-T cell therapy
• Analysis of innate T cell responses in patients with mild, moderate and severe COVID-19 and in patients with long COVID
• Dynamics of peripheral lymphocyte subsets from birth until old age
Rainbow Clinic Research Group - Clinical Paediatric Infectious Diseases
Global Child Health
• Dr Bridget Freyne MB BcH BAO, PHD. Consultant in Paediatric Infectious Diseases at CHI, Rainbow Clinic Research Group
• Safe Motherhood Malawi & Zambia
• PeriCOVID Africa
• Syph_STAT - Evaluation of the coverage and equity of same day test and treat services for PMTCT of syphilis in Malawi
• COCOA – COVID infection in children in Africa
• COCOA Quality of Care.
Immunometabolism in Tuberculosis infection
• Dr Cilian Ó Maoldomhnaigh Consultant in Paediatric Infectious Diseases at CHI, Rainbow Clinic Research Group
• Longitudinal immunological responses in Children with Bone and Joint Infection
• Non-Tuberculous Mycobacterium
• Non Sinogenic Brain Infections
Invasive fungal disease in Paediatric patients
• Dr Alida Fe Talento MD FRCPath FFPath FRCPI Consultant Microbiologist at CHI, Clinical Senior Lecturer, Dept of Clinical Microbiology, Sir Patrick Dun Laboratory
• The Fungi-HOPe project
93 Immunology and Infection . Contents
109 110 111 112 113 114
Trinity College Principal Investigators in Immunology and Infection
Name of Researcher
Dr Aideen Byrne, Consultant in Paediatric Allergy, Clinical Senior Lecturer , School of Medicine
Professor David Coghlan, Consultant Paediatrician, Children’s Health Ireland (CHI) Tallaght Hospital
Dr Sarah Doyle, Associate Professor in Immunology (Clinical Medicine)
Dr Alida Fe Talento Consultant Microbiologist at CHI, Clinical Senior Lecturer, Department of Clinical Microbiology, Sir Patrick Dun Laboratory
Dr Bridget Freyne, Consultant in Paediatric Infectious Diseases at CHIMRainbow Clinic research group
Professor Alan Irvine, Professor in Dermatology, Consultant Dermatologist
Professor Orla Killeen, Dr Emma McDermott, Professor Ursula Fearon. National Centre for Paediatric Rheumatology
Dr Rachel Mary Mc Loughlin, Professor in Immunology, School of Biochemistry & Immunology, Trinity Biomedical Sciences Institute (TBSI)
Professor Kingston Mills, Professor of Experimental Immunology, School of Biochemistry and Immunology and Academic director TBSI.
Professor Derek G. Doherty, Professor in Immunology, School of Medicine, Trinity Translational Medicine Institute, St. James’s Hospital, Dublin.
Professor Eleanor Molloy, Professor of Paediatrics & Child Health, Paediatrics
Dr Cilian Ó Maoldomhnaigh, Dr Sharee Basdeo, Professor Joseph Keane, Clinical Medicine, Trinity Translational Medicine Institute
Topic (s) of Study
Allergy in children
Childhood allergy
Immune responses in children and new born babies
Invasive fungal disease in paediatric patients
Global child health & Clinical paediatric infectious diseases
Potential therapies for atopic dermatitis in babies and children
Paediatric rheumatology research
Immunological responses to Staphylococcus aureus in paediatric atopic dermatitis
Immunity to Infection, including paediatric infections
Harnessing innate T cells for the treatment of disease
Dr Cilian Ó Maoldomhnaigh, Consultant in Paediatric Infectious Diseases at CHI Rainbow Clinic research group
Inflammation in neonatal stage and early childhood
Paediatric tuberculosis immunology
Immunometabolism in Tuberculosis infection and Clinical Paediatric Infectious Diseases
94
Immunology and Infection . Trinity College Principal Investigators in Immunology and Infection
Professor Nigel Stevenson, Viral Immunology Group, School of Biochemistry and Immunology
Dr Julie Renwick, Assistant Professor, Clinical Microbiology

Professor John Russell, Paediatric Otolaryngology CHI (Crumlin) & Discipline of Paediatrics
Dr. Tomás Ryan, Associate Professor, School of Biochemistry and Immunology
Professor Patrick Walsh, Associate Professor, Clinical Medicine
Investigating the immune evasion mechanisms of viruses
Airway microbiome in young children with cystic fibrosis
Paediatric Laryngeal fibrotic disease
How is information stored in the brain
Understanding the pathogenesis of paediatric Inflammatory Bowel Disease
95 Immunology and Infection . Trinity College Principal Investigators in Immunology and Infection
Infection and Inflammation in early childhood
Professor Eleanor Molloy, Professor of Paediatrics & Child Health, School of Medicine
The Children’s Research lab focus on two main areas: clinical evaluation and immune response research in cohorts of children with different inflammatory-related conditions such as pre-term babies and Down Syndrome. We collect detailed clinical data and biological samples like blood, urine and saliva to analyse the inflammatory response in the children, determine possible biomarkers of inflammation and assess potential mechanism of immunomodulation that could help to improve their conditions and medical treatments.
All research on Neonatal Encephalopathy (NE), Cerebral Palsy (CP) and Traumatic brain injury (TBI) and high-risk follow-up are in the Neuroscience section, including inflammatory responses.
Preterms
Gender, neonatal inflammation and preterm outcomes (GENIE)
Studies a cohort of preterm Very Low Birth Weight (VLBW) infants. Detailed multiorgan clinical assessment and immune profiles are collected to identify multiorgan dysfunction in this cohort.
Preterm infant immunomodulation to treat sepsis and brain injury prevention (PLATYPUS)
This SFI Frontiers for the Future Programme aims to look at perinatal and early neonatal periods and examine the inflammatory responses to sepsis, and necrotising enterocolitis, with subsequent brain injury complications.
Sustained inflammation in preterm infants and long term outcomes (STARFISH)
Sustained inflammaTion in preterm infAnts and multioRgan dysFunctIon correlateS witH long term outcomes (STARFISH): Preterm infants commonly are affected by multiorgan dysfunction and dysregulated systemic inflammation in the newborn period.
Follow-up of multiorgan dysfunction in childhood and correlation with inflammatory responses may allow organ specific early intervention and improve neurodevelopmental outcome, quality of life and the development of new immunomodulatory therapies.
Complex needs studies: Down syndrome
Down syndrome, Immunodeficiencies and Systemic Responses (DINOSAUR)
Funded by the the National Children's Research Centre (NCRC) Clinical Research Fellowship, the DINOSAUR study aims to increase our understanding of the causes of altered immune responses in children with Down syndrome.
SARS-CoV-2 virus infections in children
Understanding neonatal and child immune responses to SARS-CoV-2 virus (CONTINUUM)
COvid-19 NeonaTal, child and adult: Understanding immune responses (CONTINUUM): Evaluated immune responses in children and adolescents with multisystem inflammatory condition (MIS-C), a syndrome similar to Kawasaki disease which has been associated with previous infection to SARS-CoV-2 virus.
96
Immunology and Infection . Infection and Inflammation in
early
childhood . Professor Eleanor Molloy
“
The long term expected impact is to identify potential immunomodulatory therapies and biomarkers to predict outcomes and inform families.”
Potential therapies for atopic dermatitis in babies and children
Professor Alan Irvine, Professor in Dermatology, Consultant Dermatologist
Professor Alan Irvine’s primary research focus for the last 20 years is on the pathogenesis, prevention and treatment of atopic dermatitis (AD), the most common chronic inflammatory disease of children. His program centres on the genetics of AD, biophysical measurement of the skin barrier, immune mechanisms in AD and assessment of novel therapies. The Irvine Research Group developed one of the largest case collections of childhood AD, and this case collection has been used to discover several new genetic insights into this common disease.
Alan has coordinated clinical trials for novel therapies in Atopic Dermatitis and early intervention trials in high-risk infants to prevent Atopic Dermatitis. He has developed extensive industry collaboration on designing and conducting clinical trials. He is the Founding Chairman of NISR Solutions, a non-profit provider of registries for skin diseases.
Skin barrier function in atopic dermatitis
Professor Irvine’s group have long standing research programmes examining the structural biology of the skin barrier and the systematic effects of skin inflammation in both children and adults with atopic dermatitis. They use non-invasive techniques such as Raman spectroscopy and tape stripping to gain mechanistic and functional insights into atopic dermatitis (AD) pathogenesis.
Innate immune Regulation of Skin Barrier Function in Childhood Atopic Dermatitis.
Atopic dermatitis (AD) is the most common persistent inflammatory disease of early childhood. AD affects approximately 20% of children worldwide, is extremely itchy and has a very significant impact on the quality of life of affected children and their families. It is caused by skin and immunological dysfunctions and environmental factors. While milder cases may resolve, in a significant number, the condition relapses and remits throughout childhood. In a smaller minority, the course is more severe, persists into early adulthood and can be lifelong.
In AD an increase in trans-epidermal water loss (TEWL) occurs which means the skin is effectively dysfunctional. Elevated TEWL in AD is well documented, however the factors that cause this remain elusive. Certain cytokines induced through activation of the innate immune response may have the potential to regulate TEWL. Dr Doyle’s group are examining links between these cytokines and increased TEWL. Identification of pathways involved in AD causation and early pathogenesis will help lead to new therapeutic approaches to this distressing childhood disease.
Host pathogen Interactions in Atopic Dermatitis
Current collaborative projects in this space involve better understanding of immune responses to the most common pathogen associated with atopic dermatitis: Staphylococcus aureus (with Rachel McLoughlin, Trinity College) and mechanisms of Staphylococcus aureus adhesion to the skin (with Joan Geoghegan, Trinity College/Birmingham).
97
Immunology and Infection . Potential therapies for atopic dermatitis in
and children . Professor
Irvine “
The long term expected impact is to identify potential therapies for atopic dermatitis in babies and children.”
babies
Alan
Professor Coghlan has recently completed a publication series based around the experience of managing childhood food allergy during the COVID 19 pandemic.”
Childhood Allergy
Professor David Coghlan, Consultant Paediatrician, Children’s Health Ireland (CHI), Tallaght
Dr David Coghlan is a consultant paediatrician and Clinical Associate Professor, Paediatrics, Trinity College Dublin. Allergy, including food and penicillin allergy, is one of his areas of research expertise. Other conditions in which he has an interest are asthma, recurrent infections, and convulsions such as fits and seizures. David’s more recent work has focused on interventions including Vitamin D supplementation to improve symptoms in children with Autism and Asthma. While adequate nutrition is essential many children still require daily medication and his work has also looked at improving methods of medication administration in those with acute infection, allergy and complex needs.
Managing childhood food allergy during the COVID 19 pandemic
Professor Coghlan has recently completed a publication series based around the experience of managing childhood food allergy during the COVID 19 pandemic. Over 6 weeks we challenged 474 children involving 3 Dublin paediatric hospitals and colleagues in Portlaoise and Cork units. The major risk was how we manage the child with anaphylaxis from a field hospital site. We had 25 anaphylaxis episodes (5%) that were managed according to a novel clinical pathway utilising in-patient beds if required at the nearest paediatric hospital. There were no adverse outcomes and no child required PICU care. We concluded that children undergoing food challenges at scale could be safely managed in a field hospital including episodes of anaphylaxis.
The SAD study ( The On the Spot Allergy Delabelling study)
The majority of children who have been labelled as ‘penicillin allergic’ are not in fact beta-lactam allergic when rechallenged with penicillin. Most are diagnosed based on the presence of a rash only which is a common finding during any acute childhood infectious illness. This project aims to delabel children of penicillin allergy expeditiously, across multiple clinical settings, and on a ‘same day basis’, aligning with the HSE and CHI plans of delivering care to the right child, at the right time, by the right clinicians. Every child with a label of antibiotic allergy will be prospectively assessed, by a single, trained, paediatric staff-nurse, using an evaluation decision making tool. Children attending general medicine, respiratory and surgical OPD will be targeted. The decision around the likelihood of true penicillin allergy will be reviewed, in real time, by a member of the Allergy service (Consultant or Fellow).
Then to offer ON THE SPOT, observed dose administration to all children deemed suitable. This procedure will take one hour. For those that are unable for same day dosing, an alternate date will be offered. Exclusion criteria include children under 2 years of age, those with a formal antibiotic allergy diagnosis from an allergist and those who have acute symptoms at the time of recruitment. The anticipated outcomes are that 90% of children will be delabelled of penicillin allergy. This initiative will raise awareness across secondary and primary care settings of the low positive predictive value of childhood rash associated with antibiotic ingestion. This initiative also supports the CHI antibiotic stewardship programme. Funding has been applied for through the Spark Hospital Innovation Fund 2022. CHI Tallaght will be the initial study site with future plans to expand the initiative to CHI Crumlin and Temple Street pending funding.
New diagnostic techniques
Professor Coghlan’s group with Dr Aideen Byrne have assessed the performance of new food allergy component tests in an Irish context. Cashew nut (Anacardium occidentale) allergy is the second commonest seed allergen causing anaphylaxis in children. Accurate biomarkers to indicate future risk of seed anaphylaxis continue to elude us. Ana O 3 is a 2S storage protein in cashew nut. Those with an IgE response to Ana O 3 have been found to have a higher risk of true allergy including anaphylaxis. The aim of this study is to assess if IgE sensitisation to Ana O 3 predicts cashew nut allergy in an Irish paediatric population. This study is ongoing through the OPD department in CHI Tallaght. If this component testing is found to be predictive, it may reduce our reliance on food challenges which continue to be the gold standard in food allergy diagnosis.
98
Immunology and Infection . Childhood Allergy .
Professor David Coghlan
“
Paediatric Tuberculosis Immunology
Dr Cilian Ó Maoldomhnaigh, Dr Sharee Basdeo, Professor Joseph Keane Dept Clinical Medicine, Trinity Translational Medicine Institute (TTMI)
Tuberculosis (TB) is one of the biggest infectious killers in the world. There is a far higher chance of a baby getting TB disease following exposure to the bug than an adult. Babies tend to get more severe disease, often spreading outside the lungs. Our research aims to figure out the ways in which adult and baby immune systems are different. Understanding these differences and the cellular mechanisms behind them will help to inform vaccine strategies for infants and develop immunotherapies to support their immature immune system and help them fight off infection
Targeting immunometabolism to protect against childhood mortality from tuberculosis (TB)
The group will address the following research questions:
1. What deficits in innate immune cells cause increased susceptibility to infection with Mycobacterium tuberculosis in infancy?
2. How can these deficits in innate immune function be therapeutically overcome to support immunity in infants and protect against mortality?
The overall aim of this project is to address these research questions by examining the ability of immune cells from neonates, and throughout childhood, to respond to infection in a lab dish. We then aim to apply a therapeutic intervention to the cells to determine if the cells are then better able to clear the infection. This knowledge can then be translated towards patient benefit by progressing the therapeutic intervention into pre-clinical and clinical trials.

99
Immunology and Infection . Paediatric Tuberculosis Immunology . Dr Cilian Ó Maoldomhnaigh . Dr Sharee Basdeo . Professor Joseph Keane “
There is a far higher chance of a baby getting TB disease following exposure to the bug than an adult. Babies tend to get more severe disease, often spreading outside the lungs.”
Allergy in children
Dr Aideen Byrne, Consultant in Paediatric Allergy, Clinical Senior Lecturer , School of Medicine
Dr Aideen Byrne is a Paediatric Allergy Consultant in the cross-site Allergy Dept at Children’s Health Ireland (CHI). Dr Byrne together with Professor Jonathan Hourihane (now of RCSI) led the two Irish paediatric research sites in Cork and Dublin, taking part in 3 high profile, international, multisite, trials looking at mechanisms for peanut desensitisation in peanut allergic children and adolescents.
• The PEPITES Randomised Clinical Trial (2016-17) was designed to assess the efficacy and safety of wearing a peanut patch (Epicutaneous immunotherapy) in peanut-allergic children. The study demonstrated a response rate of greater than 20% with peanut patch treatment versus control group.
• The subsequent PEOPLE open label 2 year extension study (2017-19) demonstrated that 52% of participants could tolerate the equivalent of 1peanut at month 36.
• The ARTEMIS trial (2017-2018) was the largest ever peanut treatment trial. It compared the efficacy of AR101 oral immunotherapy versus a taste-masked placebo in peanut allergic children. By the end of the study, 58% of the AR101 group were able to tolerate the equivalent of 4 peanuts versus only 2% in the placebo group.

Early introduction of food allergens
During the 2020 COVID-19 lockdown, Dr Byrne studied virtual approaches to the early introduction of food allergens into high-risk infants.
Accidental food allergic reactions
Dr Byrne’s team have recently completed a prospective study of accidental food allergic reactions in Irish children, funded by the National Children’s Hospital Foundation. The results of this study will inform future planning of education for families of food allergic children.
Dr Byrne’s team, in collaboration with Dr Audrey Dunn Galvin, Department of Paediatrics and Child Health, University College Cork, are developing inexpensive, validated educational tools to improve the quality of life of carers of food allergic children.
100
Immunology and Infection . Allergy in children . Dr Aideen Byrne “
The long term expected impact is to improve the management and outcomes of children with food allergies.”
Immune responses in children and new born babies
Dr Sarah Doyle, Associate Professor in Immunology (Clinical Medicine)
This group researches the workings of the innate immune system in relation to age/life-course.
Young human innate immune response
New born babies are highly susceptible to infections by bacteria, fungi and viruses, and as a result, infection remains the single most common killer in early life. Based in the National Children’s Research Centre (NCRC), Dr Doyle’s group are investigating the PRR signalling pathways in new born babies, infants and children. These pathways are altered compared to the adult immune response. The research group aims to analyse the pathways that may contribute to their increased susceptibility to infectious agents and provide a greater understanding of the young human innate immune response. As infection remains the most common cause of death in early life, and vaccination is by far the most effective means of preventing infectious diseases, this work will help in the design of targeted vaccines by directly activating immune responses that are fully function in neonates and infants.
Innate immune Regulation of Skin Barrier Function in Childhood Atopic Dermatitis
Atopic dermatitis (AD) is the most common persistent inflammatory disease of early childhood. AD affects approximately 20% of children worldwide, is extremely itchy and has a very significant impact on the quality of life of affected children and their families. It is caused by skin and immunological dysfunctions and environmental factors. While milder cases may resolve, in a significant number the condition relapses and remits throughout childhood. In a smaller minority, the
course is more severe, persists into early adulthood and can be lifelong. In AD an increase in trans-epidermal water loss (TEWL) occurs which means the skin is effectively dysfunctional. Elevated TEWL in AD is well documented, however the factors that cause this remain elusive. Certain cytokines induced through activation of the innate immune response may have the potential to regulate TEWL. Dr Doyle’s group are examining links between these cytokines and increased TEWL. Identification of pathways involved in AD causation and early pathogenesis will help lead to new therapeutic approaches to this distressing childhood disease.
Genetic predisposition to coronary artery aneurysm formation in children with Kawasaki Disease
Kawasaki disease (KD) is the most common acquired cardiac condition in childhood in the developed world. Up to a quarter of untreated children affected by the disease develop coronary artery aneurysms (CAA) which require life-long follow up and medication. It is thought to be caused by an exaggerated immune-response to microbial infection in genetically susceptible children. This research aims to find an association between certain genetic variants and increased susceptibility to CAA formation. This may help predict the children who are predisposed to developing coronary artery aneurysms leading to more aggressive management in this cohort of high risk patients.
101
Immunology and Infection . Immune responses in children and new born babies . Dr
“
New born babies are highly susceptible to infections by bacteria, fungi and viruses, and as a result, infection remains the single most common killer in early life.”
Sarah Doyle
Better adjuvants for paediatric vaccines
 Dr Sarah Doyle, Associate Professor in Immunology, Clinical Medicine (PI), Dr Kiva Brennan (Senior Research Fellow)
Dr Sarah Doyle, Associate Professor in Immunology, Clinical Medicine (PI), Dr Kiva Brennan (Senior Research Fellow)
Vaccinations have saved millions of lives, but still millions of children die before the age of two every year of infectious diseases. This raises the question of whether childhood vaccination could be made even more effective. In their first year, children receive vaccinations against dangerous infections, but achieve protection only after several booster vaccinations. This is because elements of their immune systems are not fully ‘mature’ and do not function in the same way as an adult’s immune system. This leaves a so called ‘window of vulnerability’ in a child’s life before booster vaccinations can be administered and take effect. To maximise the effectiveness of vaccines, adjuvants can be added to boost the immune response. Our aim is to narrow this window of vulnerability in a child’s life by identifying and developing innovative adjuvants for paediatric vaccines, improving paediatric responses to vaccines.
Improving neonatal responses to current paediatric vaccines
Following extensive work in human cord blood cells, the team has identified a new adjuvant which is an excellent activator of the innate immune system in neonates and young children. They are currently carrying out proof-of-concept studies in neonatal animal models to test whether addition of this adjuvant can improve vaccine responses in neonates in vivo. The pneumococcal conjugate vaccine (PCV) is the vaccine chosen for these studies.
Pneumococcal disease is a bacterial infection caused by Streptococcus pneumoniae and kills approximately half a million children under 5 each year. Children in Ireland are currently immunised against the 13 most common serotypes of pneumococcal disease at 2, 6 and 13 months using pneumococcal conjugate vaccines (PCV-13). However, PCV-induced protection may not be
fully achieved until completion of the current vaccination schedule (12–18 months).
PCV-13 currently contains ALUM in the form of aluminium phosphate as an adjuvant. The team’s recent work has shown that ALUM does not activate cells of the neonatal immune system, however combination of a novel paediatric adjuvant with ALUM can induce neonatal immune activation, which is key in driving vaccination responses. These current studies will provide critical information on whether the innovative adjuvant can improve ALUM-containing vaccine responses in neonates & infants in vivo.
While Dr Doyle’s team has chosen PCV-13 as our proof-of-concept vaccine - if successful - this novel adjuvant could be combined with other paediatric vaccines to improve vaccine responses, allowing for earlier protection against infectious diseases and potentially reducing the need for booster vaccinations.
102
The long term expected impact is to transform the current vaccination schedule for infants, cutting down on the number of boosters needed and opening up the possibility of earlier vaccination.”
“
Immunology and Infection . Better adjuvants for paediatric vaccines . Dr Sarah Doyle . Dr Kiva Brennan
Immunological responses to Staphylococcus aureus in paediatric atopic dermatitis
Professor Rachel McLoughlin, Professor of Immunology, School of Biochemistry & Immunology, Trinity Biomedical Sciences Institute (TBSI)
Professor Mc Loughlin leads the Host Pathogen Interactions Group, whose work centres on understanding the interaction of bacteria, primarily Staphylococcus aureus, with the host's immune system. There is an urgent and unmet need for therapeutic alternatives to antibiotics to treat S.aureus, due to the ever increasing prevalence of antimicrobial resistance. The successful development of novel treatments, including immunomodulatory therapies and vaccines, requires an in-depth understanding of host-pathogen interactions to be established. Clinical collaborators include Professor Alan Irvine in CHI, Crumlin, Prof Hilary Humphreys, Beaumont Hospital.
Identification of T cell profiles associated with Staphylococcus aureus flares in paediatric atopic dermatitis
The group’s clinical research in paediatric patients focuses on the role of S. aureus in atopic dermatitis. Atopic dermatitis (AD), also known as eczema, is a highly prevalent inflammatory skin condition affecting approximately 1 in 5 children in Ireland.
Staphylococcus aureus is the most common pathogen implicated in flares of AD, which can have a profound impact on quality of life for both patients and their careers. This study utilises blood samples and skin tape strips to gain a greater understanding of the role played by specific immune cells, known as T-cells, during S. aureus infections in AD.

103
Immunology and Infection . Immunological
“
The long term expected impact is to identify immunological targets for antiStaphylococcus aureus therapies in atopic dermatitis.”
responses to Staphylococcus aureus in paediatric atopic dermatitis . Professor Rachel McLoughlin
Immunity to Infection, including paediatric infections
Professor Kingston Mills, Professor of Experimental Immunology, School of Biochemistry and Immunology and Academic director TBSI.
My research is focused on understanding the role of the immune response in the control of infection and how this can become dysregulated to cause autoimmune diseases. My work on Immunity to infection focuses on Bordetella pertussis and SARS-CoV-2 and attempts to uncover the mechanism of protective immunity in the upper and lower respiratory tract and how this can inform the design of improved vaccines against pertussis and COVID-19, in particular vaccine delivered by the nasal route. The research is funded by an SFI PI grant, two IRC scholarships, a Wellcome Trust-funded PhD studentship (joint with Rachel McLoughlin), an IMI/Gates Foundation Award and collaborative grants from Industry. I am also co-lead on the COVID-19 research hub a €7.5m strategic partnership co funded by SFI and philanthropic donors.
Understanding the role of T cells in sustained protective immunity to Bordetella pertussis to inform the design of third generation vaccines against pertussis
Current pertussis vaccines prevent whooping cough in infants and young children but do not prevent nasal colonization or transmission of Bordetella pertussis and immunity wanes rapidly after vaccination. This project has established the mechanism of protective immunity against B. pertussis and has demonstrated that a novel nasally-delivered pertussis vaccine formulation can induce long-term sterilizing immunity in the nose and lungs. The work will inform the design of more effective third generation vaccines to control the re-emergence of pertussis in children and adults, and is also being applied in the development of a candidate COVID-19 vaccine that prevents SARS-CoV-2 infection of nasal cavity as well as COVID-19 disease.
PERtussIS COrrelates of Protection Europe (PERISCOPE)
Globally, there are 16 million pertussis cases and about 195,000 pertussis deaths in children per year (estimates by CDC), making it one of the leading causes of vaccine-preventable deaths. The WHO has recommended more extensive vaccination in lowincome countries and in particular the implementation of maternal immunization programs to protect infants who are most vulnerable to pertussis.
The PERISCOPE (PERtussIS COrrelates of Protection Europe) consortium brings together internationally renowned scientists with many years of experience in Bordetella pertussis research, clinical trials, bioinformatics, immunology and public health. PERISCOPE combines two major industrial partners with public researchers from academic and public health institutes and SMEs with expertise in clinical trials, vaccinology, immunology, molecular microbiology, (human) challenge models and bioinformatics. This project will assist in the development and licensing of the next generation of improved vaccines depends on: 1) a more thorough understanding of the immune response to infection and vaccination 2) identification of biomarkers of protective immunity and 3) development of human and preclinical models as well as bioassays to predict and evaluate vaccine efficacy.
104
A consortium of 19 academic labs and two industrial partners with over €30m funding from The Innovative Medicines Initiative (IMI) and Bill & Melinda Gates Foundation.
Immunology and Infection . Immunity to Infection, including paediatric infections . Professor Kingston Mills
“
The work will inform the design of more effective third generation vaccines to control the re-emergence of pertussis in children and adults.”
Understanding the pathogenesis of paediatric Inflammatory Bowel Disease
Professor Patrick Walsh, Associate Professor (Clinical Medicine)
The research conducted by the Walsh group investigates the mechanisms which control immunity and tolerance, particularly in the context of autoimmune and inflammatory disease conditions. The group take a translational research approach, using both preclinical models, and patient samples, to investigate novel mechanisms implicated in the pathogenesis of diseases, which often first arise in childhood, such as psoriasis and inflammatory bowel disease. The primary goal of these efforts is aimed at identifying novel targets for therapeutic intervention. Professor Walsh’s laboratory is located at the National Children’s Research Centre at Our Lady’s Children’s Hospital, Crumlin, allowing close collaboration with paediatric clinician scientists to facilitate these studies. The group also collaborate with colleagues in the pharmaceutical drug development industry.
Identifying the mechanism of action of a novel therapeutic target during the earliest phases of IBD onset in childhood
Inflammatory Bowel Disease (IBD) is a life-long chronic intestinal inflammatory condition comprising of separate disease manifestations known as ulcerative colitis (UC) and crohns disease (CD) which are increasingly being first diagnosed during childhood.

While many new treatment options have emerged over the past 20 years there remains a very high number of patients for whom these approaches are ineffective. Moreover, our understanding of how disease develops during its earliest phases, when therapeutic intervention will likely be most beneficial, is relatively poor.
This project will uncover precisely how a new target pathway for IBD mediates the initiation of disease during childhood.
This research is aimed at uncovering new mechanisms which underlie the earliest phases of onset of IBD among children. With paediatric patients at its core, this study will underscore efforts improve treatment options for children and facilitate better outcomes for what is currently a life-long debilitating disease.
The project brings together an international collaborative and translational research enterprise including partners from academic, paediatric hospital and pharmaceutical drug development backgrounds. This will expedite efforts to improve treatment options for children.
105
“ Immunology and Infection . Understanding the pathogenesis of paediatric Inflammatory
Disease
This study will underscore efforts improve treatment options for children and facilitate better outcomes for what is currently a life-long debilitating disease.
Bowel
. Professor Patrick Walsh
The National Centre for Paediatric Rheumatology (NCPR) was established in 2006, providing care for children with rheumatic and musculoskeletal disorders both on a local and national level.”
Paediatric Rheumatology Research
National Centre for Paediatric Rheumatology
Professor Orla Killeen, Dr Emma McDermott, Professor Ursula Fearon.
The National Centre for Paediatric Rheumatology (NCPR) was established in 2006, providing care for children with rheumatic and musculoskeletal disorders both on a local and national level. Research strengths include care of the Young person/Adolescent Rheumatology focusing in particular on Transition to adult clinics, in addition to examining mechanisms of disease in juvenile idiopathic arthritis (JIA), Down Syndrome Associated Arthropathy (DA), juvenile dermatomyositis (JDM) and Auto-Inflammatory Syndromes. The Molecular Rheumatology group specifically focus on examining the molecular, metabolic and functional analysis of immune cell dysfunction and synovial cell-cell interactions in children with inflammatory forms of Arthritis, the aim of which is to better understand the underlying molecular mechanisms that drive diseases pathogenesis in order to develop better treatment strategies for children living with these debilitating diseases.
Distinct pathogenic mechanisms in Downs Arthritis (DA) and Juvenile Idiopathic Arthritis (JIA)
DA is rarely recognised at onset, and remains underdiagnosed, thus children with DA can present with significant joint damage and disability at diagnosis. Clinical analysis demonstrates an aggressive erosive form of inflammatory arthritis in children with Down syndrome. This is associated with immune cell dysfunction and increased synovial inflammation in the joint. This study investigates the underlying molecular mechanisms of disease, specifically focused on dysregulation of immune-stromal cell interactions, the goal of which is to identify biomarkers of disease progression/response and development of new therapeutic strategies.
Whole exome mapping of genetic variants linked with the development of chronic recurrent multifocal osteomyelitis (CRMO).
Chronic recurrent multifocal osteomyelitis (CRMO) is an auto-inflammatory condition primarily affecting children, and has an estimated prevalence of 1 per 106. It is characterized by relapsing episodes of localized bone inflammation. Researchers are currently undertaking whole exome sequencing to identify genetic variants associated with CRMO.
This data may inform a personalized therapeutic approach based on target therapies leading to reduced inflammatory load and bone damage.
Family Resilience and Adaptive Coping in Children with Juvenile Idiopathic Arthritis (JIA)
This is a prospective study focused on investigating the resilience resources and mechanisms in families of children with chronic pain due to JIA.
Developing a UK/ROI study of the incidence of JSLE in children and young people and their access to care: a collaborative approach.
The incidence of Juvenile-onset Systemic Lupus Erythematosus (JSLE) in the UK/ROI is unknown. Furthermore, we do not know how children and young people present and when and where they access care. This study aims to determine the incidence of JSLE and to understand how and where we look after children/ young people with JSLE in ireland/UK.
106
Immunology and Infection . Paediatric Rheumatology Research . Professor Orla Killeen . Dr Emma McDermott . Professor Ursula Fearon
“
Investigating the immune evasion mechanisms of Viruses
Professor Nigel Stevenson, Viral Immunology Group, School of Biochemistry and Immunology, Trinity Biomedical Sciences Institute (TBSI)
Dr Stevenson’s Viral Immunology Team in Trinity are investigating how several viruses target and evade the immune response, with a particular interest in the anti-viral Interferon response. Currently, his research focuses on the immune-modulation of RSV, HIV, MERS-CoV, SARS-CoV-1 and SARS-CoV-2/COVID-19 in children and adults. By deciphering the mechanisms through which viruses block the immune response, his research is identifying new targets for therapeutic treatment of viral infection and inflammatory disorders.
Respiratory Syncytial Virus (RSV) in children

Many children are infected with Respiratory Syncytial Virus (RSV) each year. It is a seasonal infection, peaking around October to February, causing flu-like symptoms. In some children it can progress to severe lung infections, most commonly bronchiolitis, which result in the need for hospital care. Currently there are no drugs available to cure RSV. Dr Stevenson is carrying out a study, Investigating the immune evasion mechanisms of Respiratory Syncytial Virus (RSV) in children, to see why the body’s natural immune protection struggles to clear RSV. They take blood samples from children and look at how their immune cells respond to RSV infection and anti-viral molecules in the lab.
Towards a Cure for COVID-19
Our world is increasingly under threat from contagious viral infection, whether from ongoing epidemics/ pandemics, seasonal outbreaks, cross-species transmission or new emerging viruses. In 2019, the deadly SARS-2 Coronavirus emerged in China and has quickly spread globally, infecting millions and killing thousands of people. To develop a cure, we must study how SARS-CoV-2 affects the immune system. During infection our bodies produce Interferon, a molecule that naturally kills viruses. Dr Stevenson’s Viral Immunology Team at Trinity College Dublin, have discovered that several viruses (including HIV, HCV and RSV) use a specific process to block Interferon activity. They also have exciting new evidence to suggest that Coronaviruses act in a similar fashion to inhibit Interferon. Therefore, this project investigates how SARS-CoV-2 blocks immune responses to Interferon, with the aim of revealing new, curative therapeutic targets.
107
This project investigates how SARS-CoV-2 blocks immune responses to Interferon, with the aim of revealing new, curative therapeutic targets.”
“
Immunology and Infection . Investigating the immune evasion mechanisms of Viruses . Professor Nigel Stevenson
Paediatric Laryngeal fibrotic disease
 Professor John Russell, Paediatric Otolaryngology CHI (Crumlin) & Discipline of Paediatrics
Professor John Russell, Paediatric Otolaryngology CHI (Crumlin) & Discipline of Paediatrics
In collaboration with Drs Madeline Murphy, Emma Dorris and David Phelan (School of Medicine, UCD) investigating development of a novel biotherapeutic for treatment of subglottic stenosis. This research is funded by National Children’s Research Centre.
Investigation into prevention of fibrotic scar formation as treatment for subglottic stenosis
Subglottic stenosis (SGS) is the term given to a narrowing of the area beneath the vocal cords which leads to chronic upper airway obstruction, causing severe morbidity and mortality. Acquired SGS, which occurs in premature and medically fragile infants, has been the most frequent cause of laryngeal stenosis since the introduction of prolonged intubation in neonates. SGS results from increased deposition of fibrotic tissue and is managed by surgical techniques and treatment with adjuvant therapy. Routine surgical treatment can result in inflammation and fibrosis leading to restenosis. Current adjuvant therapies have limited efficacies and there is a critical need to develop therapies to reduce the rate of formation and extent of SGS in children.
The objective of this research proposal is 1) to investigate the role of cytokine bone morphogenetic protein (BMP) 3 expression in subglottic stenosis, 2) to determine whether BMP3 can inhibit fibrogenesis and 3) the molecular mechanisms involved. Our preliminary data indicates increased BMP3 expression can inhibit profibrotic signalling in fibroblasts indicating that BMP3 holds promise as a novel anti-fibrotic therapeutic
Child health benefit: Defining the mechanisms by which BMP3 regulates pro-fibrotic signalling in association with BMP3 expression in SGS holds great potential for the development of novel therapies. BMP3 could potentially be administered to children to prevent stenosis and restenosis. An efficacious adjuvant therapy would protect against the morbidities and mortalities associated with airway stenosis and thus significantly improve child healthcare.
108
Immunology and Infection . Paediatric Laryngeal fibrotic disease . Professor
“
An efficacious adjuvant therapy would protect against the morbidities and mortalities associated with airway stenosis and thus significantly improve child healthcare.
John Russell
How is information stored in the brain?
Dr. Tomás Ryan, Associate Professor, School of Biochemistry and Immunology Principal Investigator, Trinity College Institute of Neuroscience
How is information stored in the brain? The Ryan Lab engages in fundamental research into how long-term information is stored in the brain in a stable state. The physical site of a specific memory in the brain, the memory engram is embodied in as persistent changes in neuronal ensembles. Using genetic methods to label specific memory engram cells in the mouse brain, and then reversibly control them in awake behaving mice, this program aims to understand how engrams change over development and how they interact with innate representations to enable adaptive behaviour.
Disorders of memory
Range from conditions of transience e.g. Alzheimer’s disease, to disorders of persistence, e.g. posttraumatic stress disorder. But some of the most pervasive changes in memory occur during early development in the healthy population. Infantile amnesia refers to the global loss of episodic and contextual memories formed during early life, and is conserved across the mammalian kingdom. By labelling memory engrams in the mouse, we have shown that apparently lost infant memories can be retrieved in adults by direct optogenetic stimulation of engram cells.
Based on these findings, and others from clinical models, we view many forms of amnesia or memory loss as “retrieval deficits”, with information persisting in the brain in a latent state. Furthermore, we have found that in maternal immune activation models of autism spectrum disorder, infant memories persist in an accessible form beyond infant development. These findings feed into a broader research program aimed at understanding the adaptive function of ‘forgetting’. Though forgetting is often considered to be a deficit of brain function, we investigate the mechanisms of forgetting from the perspective of it being a ‘feature’ of brain plasticity that enables an organism to update its representations of the world.

Immunology and Infection . How is information stored in the brain? . Dr. Tomás Ryan 109
“
The long term aim is to better understand the functions and mechanisms of forgetting, as an adaptive process across the lifespan”
The AIM CF project aims to characterise the lower airway microbiome of children with CF from birth.
Airway microbiome in young children with cystic fibrosis
 Dr Julie Renwick, Assistant Professor, Clinical Microbiology
Dr Julie Renwick, Assistant Professor, Clinical Microbiology
Dr Julie Renwick’s research focuses on chronic respiratory infections, with a particular interest in cystic fibrosis (CF). In recent years the airways of people with CF have been found to harbour a diverse community of microorganisms. These finding are forcing a paradigm shift in how airway infections are viewed. To date the clinical significance of the presence of these microbial communities in the CF airways is poorly understood. Dr Renwick has established and developed a number of national and international clinical studies and research projects including co-founding the AIrway Microbiome in Cystic Fibrosis (AIM-CF) project. As a principle investigator of the National Children's Research Centre, her research focused on identifying and characterising the microbial communities present in the airways of children with CF and understanding how these microbial communities interact with the host and impact on disease progression.
Airway Microbiome in Cystic Fibrosis (AIM-CF)
AIM-CF is a branch of the larger Study of Host Immunity and Early Lung Disease in Cystic Fibrosis (SHIELD CF) biobanking project established by Professor Paul McNally (RCSI) and Dr Barry Linnane (LUH). The AIM CF project aims to characterise the lower airway microbiome of children with CF from birth.
Dr Renwick and her team have employed a 16S rRNA microarray, 454 pyrosequencing, Illumina MiSeq and NovaSeq to characterise the upper and lower CF airway microbiome and compare it to healthy controls. This is an ongoing longitudinal study and the group are now beginning to focus on characterising the metabolic profiles of these microbial communities with the specific goal of identifying bacterial metabolites with the potential to influence inflammation and thus disease severity in CF.
110
“
Immunology and Infection . Airway microbiome in young children with cystic fibrosis . Dr Julie Renwick
Harnessing innate T cells for the treatment of disease
Professor Derek G. Doherty, Professor in Immunology, School of Medicine, Trinity Translational Medicine Institute, St. James’s Hospital, Dublin.
Our research is aimed at finding out how the immune system protects against or causes disease in humans and how it can be manipulated for the development of novel therapies. We are particularly interested in populations of 'innate T cells' (natural killer T cells, gamma/delta T cells and mucosa-associated invariant T cells), which play early roles in controlling immune responses and tissue homeostasis and are impaired in children and adults with cancer and infectious disease. We are investigating the molecular and cellular interactions that take place between innate T cells, pathogens and other cells and attempting to manipulate these processes to promote the generation of therapeutic immune responses.
Analysis of innate T cell reconstitution after allogeneic stem cell transplantation and CAR-T cell therapy
Our current research suggests that early reconstitution of innate T cells is associated with favourable outcomes in patients undergoing allogeneic stem cell transplantation and CAR-T cell therapy for blood cancers. We are currently investigating the mechanisms by which innate T cells prevent infection, cancer re-emergence and graft versus host disease in these patients. Data to date suggest that analysis of immune cell reconstitution will yield prognostic biomarkers and novel therapeutic interventions for patients with blood cancers.
Analysis of innate T cell responses in patients with mild, moderate and severe COVID-19 and in patients with long COVID
We are analysing the phenotypes, differentiation and activation status and functions of innate T cells in patients with COVID-19 in attempts to identify roles for individual cell populations in immunity against SARS-CoV-2 and the pathogenesis of COVID-19.
We are also seeking to determine if conventional or innate T cells are involved in the pathology present in patients with post-acute sequalea of COVID-19.
Dynamics of peripheral lymphocyte subsets from birth until old age
The immune system is inexperienced before birth and tends to be tolerogenic, rather than immunogenic. After birth, the adaptive immune system develops while facing microbial challenges, but it can become impaired as old age progresses and persistent inflammation can lead to chronic morbidity, disability and frailty.
To investigate potential contributions of lymphocyte subsets to immunity from birth until old age, we are enumerating and functionally characterising circulating innate and conventional lymphocytes and measuring serum cytokine levels in blood samples from healthy neonates, school-age children, young adults and older subjects.
111
Immunology and Infection .
Harnessing innate T cells for the treatment of disease . Professor Derek G. Doherty
“
The immune system is inexperienced before birth and tends to be tolerogenic, rather than immunogenic.”
Rainbow Clinic Research Group - Clinical Paediatric Infectious Diseases Global Child Health
Dr Bridget Freyne MB BcH BAO, PHD. Consultant in Paediatric Infectious Diseases at CHI Rainbow Clinic Research Group
My research aims to have direct clinical impact on child health outcomes in Ireland and globally through understanding how health systems and social determinant of health interact with childhood infection. Currently my work in sub-Saharan Africa is focused on I am advancing current knowledge on the global prevalence of preventable, treatable congenital infections such as HIV, syphilis, STI, CMV and Toxoplasmosis. Through collaboration with multi-disciplinary teams I seek to understand the barriers to diagnosis and management of these infections and to develop acceptable, sustainable interventions which can be evaluated prospectively. In Ireland I am working with a multidisciplinary team of microbiologists, pharmacists and nurses to understand the epidemiology of invasive fungal infection in children with haematological and oncological malignancy.
Safe Motherhood Malawi & Zambia
The Safe Motherhood group is a multi-disciplinary team of researchers from Malawi, Zambia and other international collaborators which aims to develop and implement enhanced antenatal care in sub-Saharan Africa to improve maternal and neonatal outcomes. Dr Freyne is a co-lead of Work Stream 8 which seeks to co-design acceptable and sustainable interventions for the prevention of mother to child transmission of syphilis and the diagnosis and management of congenital syphilis in LMICs.
PeriCOVID Africa
PeriCOVID Africa collected clinical and serological data from 5 African countries to determine the effect of COVID-19 on pregnancy and neonatal outcomes. In Malawi we recruited 400 mother-infant pairs to determine sero-epidemiology, the effects of co-infection with HIV and malaria and the potential for mother to child transmission of Sars-CoV-2.
Syph_STAT - Evaluation of the coverage and equity of same day test and treat services for PMTCT of syphilis in Malawi
The Syph_STAT project is utilising mixed methods to identify the health systems and quality of care bottlenecks in the delivery of services for PMTCT of syphilis across 6 health facilities in Malawi.
COCOA – COVID infection in children in Africa
The COCOA study implemented the WHO ISARIC (International Severe Acute Respiratory and Emerging Infection Consortium) protocol to describe the epidemiology, clinical features and outcome in Paediatric COVID-19 disease in Malawi.
COCOA Quality of Care.
This study oversaw the implementation of a multifaceted intervention including infection prevention, PPE alternatives and a digital health platform to monitor inpatient quality of care during the COVID-19 pandemic at a tertiary children’s hospital in Malawi.
112
Immunology and Infection . Rainbow Clinic Research Group - Clinical Paediatric Infectious Diseases Global Child Health . Dr Bridget Freyne
“
My research aims to have direct clinical impact on child health outcomes in Ireland and globally through understanding how health systems and social determinant of health interact with childhood infection.”
The long term expected impact is to use multidisciplinary expertise to improve paediatric outcomes from infectious disease through the generation of high quality evidence on both the epidemiology of paediatric infection but also the optimal pathways for prevention and treatment in diverse contexts.”
Immunometabolism in Tuberculosis infection
Dr Cilian Ó Maoldomhnaigh Consultant in Paediatric
Infectious Diseases at CHI Rainbow
Clinic Research Group
My laboratory based research has been through the Keane laboratory and focused on neonatal immunometabolic responses to Tuberculosis infection during which time I have identified potential immunometabolic modulators including lactate and I am in the process of applying for further research funding to progress my research findings towards host directed therapies. My clinical research is based on improving the outcomes of the patients that we see in the Rainbow team in Children’s Health Ireland involves a wide range of infections including meningococcal disease and group A Strep.
Longitudinal immunological responses in Children with Bone and Joint Infection
Dr Ó Maoldomhnaigh is leading a project that will examine the immune responses of children with osteo-articular infection over the course of their illness from samples biobanked as part of the All-Ireland Infectious Disease Cohort Study (UCD).

Non-Tuberculous Mycobacterium
There has been a sharp rise in the number of atypical mycobacterium lymphadenitis presenting to the Rainbow service and Dr Ó Maoldomhnaigh is leading a multi-disciplinary team including Infectious Disease, Microbiology, ENT and Histopathology in an effort to determine the previous epidemiology of this illness and to ascertain why this increase in incidence has occurred.
Non Sinogenic Brain Infections
Dr Ó Maoldomhnaigh is collaborating with Professor Darach Crimmins on a Masters project examining the presentation and clinical outcome of children with non-sinogenic brain infections over a 15 year period, co-authoring a publication that will be submitted for publishing in the coming months.
113
Immunology and Infection . Immunometabolism in Tuberculosis infection . Dr Cilian Ó Maoldomhnaigh “
Invasive fungal disease in Paediatric patients
 Dr Alida Fe Talento MD FRCPath FFPath FRCPI Consultant Microbiologist at CHI, Clinical Senior Lecturer, Dept of Clinical Microbiology, Sir Patrick Dun Laboratory
Dr Alida Fe Talento MD FRCPath FFPath FRCPI Consultant Microbiologist at CHI, Clinical Senior Lecturer, Dept of Clinical Microbiology, Sir Patrick Dun Laboratory
My research work is focused on 2 main areas namely invasive fungal disease (IFD) and antimicrobial stewardship (AMS). With regards IFD research, these are focused and fungal diagnostics, surveillance, antifungal resistance and antifungal stewardship (IFD). My antifungal stewardship work has close links with research done on antimicrobial stewardship and antimicrobial resistance. Recent work has focused in paediatric patients given the dearth of data on both topics in paediatric patients
The Fungi-HOPe project
Dr Alida Fe Talento is leading a project on invasive fungal disease and antifungal stewardship in paediatric Haematology-Oncology patient in the Republic of Ireland (The Fungi-HOPe project). This project is a collaboration with CHI colleagues in infectious diseases, haematology-oncology and pharmacy.
This is an observational descriptive study which will provide much needed information on the epidemiology of IFD, the approach to diagnosis and management of these infections in this immunocompromised cohort of patients. We will also explore the barriers to implementation of antifungal prophylaxis and treatment guidelines which have been recently updated based on international evidence based guidelines.
114
Immunology and Infection . Invasive fungal disease in Paediatric patients . Dr Alida Fe
“
This is an observational descriptive study which will provide much needed information on the epidemiology of IFD, the approach to diagnosis and management of these infections in this immunocompromised cohort of patients.”
Talento
footer 115

Neuroscience and Mental Health
Introduction to Neuroscience and Mental Health at Trinity College Dublin
Trinity College Principal Child Health Research Investigators in Neuroscience and Mental Health
Neonatal and child brain injury
• Professor Eleanor Molloy, Professor of Paediatrics & Child Health, School of Medicine
• Neonatal Encephalopathy (NE)
• Gender and inflammation in neonatal encephalopathy (GEMINI)
• Neonatal Inflammation, multiorgan dysfunction and brain injury (NIMBUS)
• Modified Delphi approach for definition and diagnostic of Neonatal encephalopathy (DEFINE)
• Circadian rhythm alterations and outcome in Neonatal Encephalopathy (CRADLE)
• Point of care ultrasound for functional multiorgan evaluation in neonatal encephalopathy (PUFFIN)
• Develop a Core Outcome Set for use in clinical trials, and other studies, for interventions for the treatment of Neonatal Encephalopathy (COHESION)
• Traumatic brain injury
• Traumatic brain injury in paediatric patients (PROSPER)
• Paediatric Traumatic Brain injury and Outcomes using miRNAs (POLARIS)
• Cerebral Palsy and high risk follow-up
• Severe neurological impairment and children with medical complexity (SERENITY)
• Inflammatory responses and multiorgan outcomes in children who experienced neonatal brain injury (FIREFLY)
• Childhood multiorgan outcomes after Neonatal encephalopathy (CHAMPION).
The Developing Brain
• Professor Clare Kelly, Associate Professor, Trinity College Institute of Neuroscience (TCIN)
• Sex matters: Identifying the neurodevelopmental origins of sex differences in depression
• Innovating Neuroimaging Markers in Neurodevelopmental Disorders (InMind)
Infant brain and mind
• Professor Rhodri Cusack, Thomas Mitchell Professor of Cognitive Neuroscience
• FOUNDCOG
• The developing brain and mind
• Interplay
• Many Babies At Home
The neurophysiology of auditory cognition across the lifespan
• Dr. Giovanni Di Liberto, Assistant Professor, School of Computer Science and Statistics (discipline of Artificial Intelligence), ADAPT Centre, Trinity College Centre of Neuroscience
117
Neuroscience and Mental Health . Contents
121 122 124 126 127 128
• The emergence of language in infants
• Natural speech listening in autism spectrum disorder
Exploring early-life experiences and brain dynamics
• Professor Mark Cunningham, Ellen Mayston Bates Professor of Neurophysiology of Epilepsy
• Impact of variations in early life maternal care on brain activity
• Chicken-Stress
Exploring typical neurodevelopment and mental health disorders
• Professor Arun Bokde, Associate Professor Psychiatry
• The IMAGEN Study
• Brain Injuries in Neonates Study
• Network Lesions and Outcomes in Neonatal Encephalopathy Study
• Functional brain changes in neonatal encephalopathy infants and associated behavioural and cognitive consequences (NEON)
Child and Adolescent Psychiatry
• Professor Jane McGrath, Associate Professor Consultant, Psychiatry
• PRISM Study
• Multimodal neuroimaging in ADHD
• Clinical Research studies in ADMiRE
Cognitive neuroscience
• Professor Robert Whelan, Associate Professor in Psychology
• IMAGEN
• Attention Deficit Hyperactivity Disorder (ADHD)
Attention Deficit Hyperactivity Disorder
• Professor Robert Whelan and Professor Jane McGrath
• Understanding the mechanism of action of methylphenidate in ADHD: A computational psychiatry approach
• Predicting who will respond to stimulant medication in ADHD: A precision medicine approach using neurally informed computational models
Genomics of Neurodevelopmental Disorders and Biomarkers
• Professor Louise Gallagher, Chief of the Child and Youth Mental Health Collaborative, SickKids, University of Toronto and Professor of Child and Adolescent Psychiatry in Trinity College Dublin
• Risk, Resilience and Developmental Diversity in Mental Health? (R2D2-MH)
• The Synaptic Gene Study (SynaG)
• Social cognition and social reward in Prader Willi Syndrome and relationship to autism spectrum disorder symptoms and oppositional behaviours
• Validation of an eye-tracking attentional bias paradigm as a biomarker for satiety in PWS
Multisensory perception in children
• Professor Fiona Newell, Professor of Experimental Psychology
• Multisensory object categories Project
• The ‘weDRAW’ Project
118
Neuroscience and Mental Health . Contents 129 130 131 132 133 134 136
The development of conscious awareness in infancy
• Dr. Lorina Naci, Associate Professor of Psychology
• The development of the brain circuitry for conscious awareness in infancy
• Brain network dynamics in human infants
Antenatal depression and infant development
• Professor Veronica O’Keane, Professor in Psychiatry & Consultant Psychiatrist
• Antenatal depression and the impact on infant development
• Perinatal depression and the HPA axis
Child Health & Wellbeing
• Dr. Lorraine Swords, Assistant Professor in Child & Adolescent Psychology
• REFUGE-ED
• Childhood Adverse Experiences
• ADAPT
Parent-Child Interaction & Children’s Development
• Dr. Elizabeth Nixon, Associate Professor, Psychology & Dr. Jean Quigley, Assistant Professor, Psychology
• PETIT: Preterm Infant Interaction and Development
• PANDA: Psychological and Neuro-Developmental Assessment of Neonatal Encephalopathy
• DIAMOND: Dyadic InterAction in Down SyndroMe & Outcomes for Neuro-Development
• LEAP: Links between Early parenting and Academic Performance
• EMERALD: Eye Movements & early markers of Atypical Language Development in Down syndrome
Mental Health and Well Being
• Professor Agnes Higgins, Professor in Mental Health, School of Nursing and Midwifery and Trinity Center for Practice and Health Care Innovation
• Being LGBTQI+ in Ireland
Contemporary perspectives on adolescent mental health
• Dr Alina Cosma (MSCA IF) School of Social Sciences and Philosophy & Dr Yekaterina Chzhen (Host Supervisor)
• GenerationZ – Marie Skłodowska-Curie Action
Improving Education for GPs regarding Adolescent Mental Health
• Dr. Dónal Wallace, Assistant Professor in General Practice, Institute of Population Health, Public Health & Primary Care
• Development and evaluation of a CME educational tool designed to equip General practitioners (GPs) in Ireland to manage adolescent mental health presentations
Birth asphyxia and neuroinflammation
• Dr Eva Jimenez-Mateos, Assistant Professor, Physiology
• Inflammation after neonatal brain damage
119
Neuroscience and Mental Health . Contents 137 138 139 140 141 142 143 144
Rett Syndrome and related neuropsychiatric disorders
• Dr Daniela Tropea, Associate Professor Psychiatry, School of Medicine
• Uncovering the molecular mechanisms of Trofinetide
• DATARETT: a data sharing platform for Rett Syndrome
Predicting childhood development after neonatal brain injury
• Dr. Jason Wyse, Assistant Professor, Statistics, School of Computer Science & Statistics
• Data driven scoring for childhood development in neonatal brain injury
Feeding and Swallowing Disorders in Infants
• Dr Margaret Walshe, Department of Clinical Speech and Language Studies, School of Linguistic, Speech and Communication Sciences
• Oral stimulation for promoting oral feeding in preterm infants
Rare neurodevelopmental disorders research
• Dr. Massimiliano Bianchi, Founder/President & CEO, Ulysses Neuroscience Ltd; Adjunct Assistant Professor, Trinity College - Institute of Neuroscience (TCIN), Trinity College Dublin, Lloyd Institute; Adjunct Associate Professor, Department of Chemistry, University of Maynooth
• Plasma microtubule proteins as potential biomarkers for CDKL5 Deficiency Disorder (CDD)
• Syrens: A Neurolinguistic study to assess cognitive abilities and develop composite biomarkers in Fragile X Premutation Carriers.
120 Neuroscience and Mental Health . Contents
Patient-centric initiatives: Podcasts and awareness events 145 146 147 148
•
Introduction to Neuroscience and Mental Health at Trinity College Dublin
Dr Lynne Kelly, Discipline of Paediatrics, School of medicine

Research at the neonatal and infancy stage of life through to early childhood is paramount in our understanding of neurodevelopmental outcomes in neonatal brain injury. The scope of neuroscience in Trinity College is wide and spans multiple disciplines. Our areas of research focus on neonatal, infant, childhood and teenage years and we have experts in the fields of laboratory-based work, neuroimaging and genomics.
Laboratory
Research in the laboratory setting involves Neonatal and childhood research in immunology and infection. The work in the Children’s Research lab studies children from birth through to early childhood with Hypoxic-Ischemic injury, Neonatal Encephalopathy, Traumatic Brain Injury, Cerebral Palsy and severe neurological injuries. Understanding the role of inflammation and immunomodulation in these cohorts of patients will enable researchers to plan and develop new therapies and improve quality of life for these children. This theme continues in the fields of psychology, psychiatry, physiology and computer science and statistics studying typical brain development and neuropsychiatric conditions and how early-life experiences shape our brains. We research childhood development and work on parent and child interactions and pre-clinical animal models to examine, evaluate and understand the mechanisms of brain damage and neuronal dynamics. We also use statistical modelling to classify and predict children’s development over time.
Neuroimaging and Genomics
Our neuroimaging research takes place in the Trinity College Institute of Neuroscience (TCIN), where our experts use translational brain imaging techniques to study typical brain development and how that development becomes disrupted in various conditions. We can use neuroimaging to understand how our brains develop and how changes to this developmental process are in infants with brain injury. By combining brain imaging, genetics, and psychiatry we can increase our understanding of brain development and behaviour. In the field of genomics, researchers are developing multisensory technology for learning, investigating brain organisation in how it develops in infancy to how it breaks down in the disordered brain.
We are also researching the antenatal phase of pregnancy and infant development, child health with
both mothers and fathers’ interactions, and a great body of work is focused on mental health as a key priority for shaping government and national/ international mental health policy, driving mental health service reform and overall improving mental health practice. Studies in mental health are paramount in giving our youth of today the best possible quality of life and research into the cause of impaired mental health, how interactions with parents influence children’s development and how potential new therapies will help to improve the management of children with mental health issues. A better understanding of the genetic causes of some brain disorders are enabled by our genetic and biomarker research which is helpful to progress clinical trials in children.
Impact
Our key strengths are that in addition to characterising the development of the human mind to understand how it is disrupted by brain injury and to produce new diagnostic tools for neonatologists, we hold many national and international collaborations in improving the brain health and developmental outcome of infants and children to improve their future and we are at the forefront of understanding children’s needs, informing interventions, promoting resilience and understanding more about young people’s mental health and wellbeing. Our findings will be used to guide recommendations for policy and education and directly influence legislation going forward. This area of Neuroscience and Mental Health research is actively funded from multiple sources including Irish Health Research Board, European Research Council, Science Foundation Ireland, Irish Research Council, Horizon 2020, European Commission, multiple charities and more. The overall impact of this field of research within Trinity College will be to improve children’s health and better outcomes for a sustained quality of life.
121
Neuroscience and Mental Health . Introduction to Neuroscience and Mental Health at Trinity College Dublin . Dr Lynne Kelly
Trinity College Principal Child Health Research Investigators in Neuroscience and Mental Health
Name of Researcher
Professor Eleanor Molloy, Professor of Paediatrics & Child Health, School of Medicine
Dr Alina Cosma & Dr Yekaterina Chzhen School of Social Sciences and Philosophy
Professor Arun Bokde, Associate Professor Psychiatry
Professor Mark Cunningham, Ellen Mayston Bates Professor of Neurophysiology of Epilepsy
Professor Rhodri Cusack, Thomas Mitchell Professor of Cognitive Neuroscience
Dr. Giovanni Di Liberto, Assistant Professor, School of Computer Science and Statistics
Professor Louise Gallagher, University of Toronto and adjunct Professor of Child and Adolescent Psychiatry in Trinity College Dublin
Professor Agnes Higgins, Professor in Mental Health School of Nursing and Midwifery and Trinity Center for Practice and Health Care Innovation
Dr. Eva Jimenez-Mateos, Assistant Professor, Physiology
Professor Clare Kelly, Associate Professor, Trinity College Institute of Neuroscience (TCIN)
Professor Jane McGrath, Associate Professor Consultant, Psychiatry
Topic (s) of Study
Neonatal and child brain injury
Contemporary perspectives on adolescent mental health
Exploring typical neurodevelopment and mental health disorders
Exploring early-life experiences and brain dynamics
Infant brain and mind
The neurophysiology of auditory cognition across the lifespan
Genomics of Neurodevelopmental Disorders and Biomarkers
Mental Health and Well Being
Birth asphyxia and neuroinflammation
The Developing Brain
Child and Adolescent Psychiatry
Professor Eleanor Molloy, Professor of Paediatrics & Child Health, Paediatrics
Dr. Lorina Naci, Associate Professor of Psychology
Professor Fiona Newell, Professor of Experimental Psychology
Dr. Elizabeth Nixon, Associate Professor, Psychology & Dr. Jean Quigley, Assistant Professor, Psychology
Neonatal Brain injury (neonate encephalopathy - NE)
The development of conscious awareness in infancy
Multisensory perception in children
Parent-Child Interaction & Children’s Development
122
Neuroscience and Mental Health . Trinity College Principal Child Health Research Investigators in Neuroscience and Mental Health
Professor Veronica O’Keane, Professor in Psychiatry & Consultant Psychiatrist
Dr. Lorraine Swords, Assistant Professor in Child & Adolescent Psychology
Dr Daniela Tropea, Associate Professor Psychiatry, School of Medicine
Dr. Dónal Wallace, Assistant Professor in General Practice, Institute of Population Health, Public Health & Primary Care
Professor Robert Whelan, Associate Professor in Psychology
Dr Jason Wyse, Assistant Professor, Statistics, School of Computer Science & Statistics
Dr Margaret Walshe, School of Linguistic, Speech and Communication Sciences
Antenatal depression and infant development
Child Health & Wellbeing
Rett Syndrome and related neuropsychiatric disorders
Improving Education for GPs regarding Adolescent Mental Health
Cognitive neuroscience
Predicting childhood development after neonatal brain injury
Feeding and swallowing disorders in infants
123
Neuroscience and Mental Health . Trinity College Principal Child Health Research Investigators in Neuroscience and Mental Health
Traumatic brain injury (TBI) is more common in childhood and adolescence than at any other time of life and is one of the most common causes of neurological morbidity (including concussion).”
Neonatal and child brain injury
Professor Eleanor Molloy, Professor of Paediatrics & Child Health, School of Medicine
The Children’s Research lab focus on clinical evaluation and immune response research in its impact on neurodevelopment. Detailed clinical data and biological samples like blood, urine and saliva are collected to analyse the inflammatory response in the children, determine possible biomarkers of inflammation and assess potential mechanism of immunomodulation that could help to improve their conditions and medical treatments.
Neonatal Encephalopathy (NE) Gender and inflammation in neonatal encephalopathy (GEMINI)
This project aims to understand the role of the immune system in neonatal brain injury and the role of gender. There is a well-recognised difference in incidence and outcome of NE according to gender with a pronounced male disadvantage. GEMINI will delineate the clinical differences as well as the immunological and inflammatory alterations according to gender by understanding the effect of sex hormones on immune metabolic function.
Neonatal Inflammation, multiorgan dysfunction and brain injury (NIMBUS)
This HRB funded study investigates neonatal inflammation and multiorgan dysfunction in Neonatal Encephalopathy. It also hopes to identify clinical and biomarker prognostic indicators.
Modified Delphi approach for definition and diagnostic of Neonatal encephalopathy (DEFINE)
The aim of the DEFINE study is to use a modified Delphi approach to form a consensus definition and set of diagnostic criteria for neonatal encephalopathy. With a consensus-based definition, we hope to be able to improve communication with families and between professionals and ultimately have a positive impact on patient care.
The following projects are part of the HRB Neonatal Encephalopathy PhD Training Network (HRB NEPTuNE) - funded by the HRB. Their long-term expected impact is to improve outcomes for infants with neonatal encephalopathy.
Circadian rhythm alterations and outcome in Neonatal Encephalopathy (CRADLE)
Changes in circadian rhythm are common in many illnesses including neonatal brain injury and neonatal encephalopathy (NE). CRADLE will investigate the role
of circadian rhythm in Neonatal Encephalopathy and explore whether alterations in duration of light exposure will decrease inflammation and improve outcome.
Point of care ultrasound for functional multiorgan evaluation in neonatal encephalopathy (PUFFIN)
PUFFIN will examine the use of ultrasound in the diagnosis and management of multi-organ dysfunction and study both routine and novel biomarkers of organ dysfunction. The project aims to improve management of multiorgan dysfunction, and therefore outcome. It will also assess potential adjuvant treatment strategies to therapeutic hypothermia that may improve developmental and health outcomes as well as providing a definition for NE. This project is part of the HRB Neonatal Encephalopathy PhD Training Network (HRB NEPTuNE).
Develop a Core Outcome Set for use in clinical trials, and other studies, for interventions for the treatment of Neonatal Encephalopathy (COHESION)
A challenge faced by systematic reviewers when trying to synthesise evidence from studies on a particular topic is heterogeneity in the outcomes measured in those studies. COHESION will develop a Core Outcome Set for use in clinical trials, and other studies, for interventions for the treatment of Neonatal Encephalopathy. This will ensure that a standardised set of outcomes (COS) will be considered across an entire research area which will enable effective comparison of study and trial results.
Traumatic brain injury
Traumatic brain injury in paediatric patients (PROSPER)
PaediatRic Outcomes and Serum biomarker Panel in acutE traumatic bRain injury /concussion to severe traumatic (PROSPER): Traumatic brain injury (TBI) is more common in childhood and adolescence than at any other time of life and is one of the most common causes of neurological morbidity (including
124
Neuroscience
and Mental Health . Neonatal and child brain injury . Professor Eleanor Molloy
“
concussion). Post-concussion syndrome (PCS) combines clinical, cognitive and behavioural symptoms and occurs in one in seven school children sustaining a mild TBI for three months or longer. It is also associated with persistent inflammation. At present there are no evidence-based clinical guidelines or accurate early tests to predict PCS in children.
Paediatric Traumatic Brain injury and Outcomes using miRNAs (POLARIS)
The aim of the POLARIS project is to evaluate clinical tools and potential biomarkers used in the diagnosis, management and prognostication of children who have sustained a mild traumatic brain injury. Researchers will investigate the role of microRNA as a biomarker for diagnosing paediatric traumatic brain injury and its correlation with severity of brain injury. The team will also evaluate cytokines, in particular serum total tau, as a biomarker for persisting post-concussive symptoms and compare clinical concussion tools used in the initial assessment and diagnosis of children with mild traumatic brain injury.
Cerebral Palsy and high risk follow-up

Severe neurological impairment and children with medical complexity (SERENITY)
The term Severe Neurological Impairment (SNI) is commonly used to describe children with significant disability and complex medical needs. Consistency in research in the area of SNI is hampered by the lack of a consistent definition of the term. To date, no one has quantified the multiorgan dysfunction that is associated with SNI. This impacts our ability to plan healthcare services and ensure that these children and their families are receiving the support that they require. The project aims to create a consensus-based definition of Severe Neurological Impairment, to quantify the multi-organ dysfunction associated with SNI and to assess the quality of life of these children and their families.
Inflammatory responses and multiorgan outcomes in children who experienced neonatal brain injury (FIREFLY)
Aims to examine multi-organ dysfunction in early childhood in children who had neonatal encephalopathy (NE) by evaluating detailed multiorgan dysfunction outcomes, and immunological markers present at neonatal stage that may persist in early childhood.
Childhood multiorgan outcomes after Neonatal encephalopathy (CHAMPION).
The project aims to examine multi-organ injury in
children who had NE at birth alongside their neurodevelopmental follow-up. This research will provide insight into persistent inflammation and long-term developmental outcome of these children as specific cognitive functions continue to develop through childhood. This study will also measure the impact of multiorgan dysfunction on the quality of life in these children. Research in this area is required to provide better predictive data and contribute to improved prognosis.
125
Research in this area is required to provide better predictive data and contribute to improved prognosis.
“
Neuroscience and Mental Health . Neonatal and child brain injury . Professor Eleanor Molloy
The Developing Brain
Professor Clare Kelly, Associate Professor, Trinity College Institute of Neuroscience (TCIN)
Dr Clare Kelly is a developmental cognitive neuroscientist whose research uses translational brain imaging techniques to study typical brain development and how that development becomes disrupted in neuropsychiatric conditions. The goal of this work is to better understand psychiatric conditions such as depression by tracing the origins of these conditions in the developing brain. She is a passionate proponent of open and reproducible science, of accessible science communication and public engagement, an advocate for equality, diversity, and inclusion, and is one of a group of TCD staff seeking to prioritise action on climate and biodiversity in TCD. These fundamental questions are also giving shape to new directions in Clare's research programme.
Sex matters: Identifying the neurodevelopmental origins of sex differences in depression
Depression is the leading cause of illness, worldwide. It affects twice as many women as men, suggesting that female biology increases vulnerability to depression. Yet, most basic scientific research on causes of and treatments for depression is conducted in male animals, creating a "data gap" that impedes translation of findings to humans, which disadvantages women. This project addresses this gap by identifying how stress affects brain development in male and female juvenile rodents, using the same neuroimaging methods we use in humans. Our findings will reveal how the stressrelated brain dysfunction underlying depression takes root and how sex affects this process.
Innovating Neuroimaging Markers in Neurodevelopmental Disorders (InMind)
Despite its promise, no functional imaging-based biomarker has yet attained clinical viability. A central limiting factor has been a lack of robust yet sensitive assays. Methodological advances are required to overcome this barrier to progress. This is particularly true for developmental applications, where movement in the MRI scanner (to which children are prone) poses a challenge to accurate measurement. The aim of this project is to improve the sensitivity of functional connectomics-based biomarkers of neurodevelopmental disorders. This will be achieved through a series of studies that will innovate a set of methodological advances for biomarker detection using fMRI data collected from neurodevelopmental populations (Autism Spectrum Disorder (ASD) and adolescent depression).

126
Neuroscience and Mental Health . The Developing Brain . Professor Clare Kelly
Most basic scientific research on causes of and treatments for depression is conducted in male animals, creating a "data gap".”
“
Infant brain and mind
Professor Rhodri Cusack, Thomas Mitchell Professor of Cognitive Neuroscience
Professor Rhodri Cusack uses neuroimaging to study the emergence of cognition in infants, to understand how our minds develop, and how this is disrupted in infants with brain injury. His research group is particularly interested in the development of infants in their first year of life, what they are thinking and what they are learning. By studying healthy infants, they aim to improve understanding of brain development during the first year and by studying infants from the neonatal intensive care unit, to improve diagnoses and therapies for infants who’ve had a difficult start in life.
FOUNDCOG
This project aims to address the question: ‘why are human infants helpless for so long during infancy?’. Animal species that are more intelligent generally have a longer period of helplessness, and our hypothesis is that it is critical to lay the right foundations for cognition (FOUNDCOG) during the helpless period. To do this, the group use neuroimaging of infants in their critical first year after birth to capture the development of the brain and its functions. They aim to interpret the results by comparing them to computational models of learning, using deep neural networks. In addition to characterising the development of the human mind, they will aim to understand how it is disrupted by brain injury and to produce new diagnostic tools for neonatologists.
The developing brain and mind
Professor Cusack’s group measure the development of connections in the infant brain in the first year, using diffusion-weighted and functional connectivity MRI, and relate this to the development of brain function.
They have developed many methods for measuring brain function and are working to understand how it is disrupted by injury around the time of birth. The group collaborate with maternity hospitals in Dublin as well as other international centres.
Interplay
With Dr Lorijn Zaadnoordijk, Professor Cusack is investigating how social interactions shape development. The project focuses on how the infants’ internal preferences for some things over others – their curiosity – shapes interactions with social agents, in healthy and preterm infants.
Many Babies At Home
Professor Cusack is co-leading a large-scale international collaboration to develop ways of testing infant behaviour online, through the parent’s home computer. Online testing has tremendous potential for research and clinical application.

127
This project aims to address the question:
Neuroscience and Mental Health .
‘why are human infants helpless for so long during infancy?’.”
Infant brain and mind . Professor Rhodri Cusack . Professor Thomas Mitchell
“
electroencepha-
The neurophysiology of auditory cognition across the lifespan
Dr. Giovanni Di Liberto, Assistant Professor, School of Computer Science and Statistics (discipline of Artificial Intelligence), ADAPT Centre, Trinity College Centre of Neuroscience
My research centres on studying how humans communicate through sounds, with a particular focus on speech and music. One key angle of my work is to study auditory cognition across the lifespan, from early development in babies to hearing loss in the ageing population. This work is primarily carried out via electrophysiology measurements (e.g., EEG, MEG), deriving objective indices of cognition that can be used to study particular cohorts, from dyslexia and specific language impairment to autism spectrum disorder.
The emergence of language in infants
Even prior to producing their first words, infants are developing a sophisticated speech processing system, with robust word recognition present by 4-6 months of age. These emergent linguistic skills, observed with behavioural investigations, are likely to rely on increasingly sophisticated neural underpinnings. The infant brain is known to robustly encode speech sounds, however it is still uncertain whether and from when they encode linguistic properties, such as phonemes. This project aims to study the developmental trajectory of language processing in the first year of life, by using electrophysiology signals recorded with electroencephalography (EEG) from infants as they were presented with nursery rhymes.
This is a longitudinal investigation in a cohort of 50 infants, with EEG recordings when aged 4, 7 and 11 months, as well as adults. The ability of measuring the developmental trajectory of language learning with direct neural measures, such as EEG, allows us to derive a set of objective indices for typically developing infants, which could then be potentially used as a predictor of future language development.
Furthermore, the methodology developed in this project offers an entire new way to investigate auditory perception in infants, as previous studies focused on experimental paradigms that were far from real-world scenarios (e.g., listening to repetitions of two or three syllables for 10-20 minutes), while the proposed paradigm involves a realistic and pleasant task.
Natural speech listening in autism spectrum disorder
Autism-spectrum disorder (ASD) is characterised by difficulties with social interaction that can vary greatly in when the symptoms start, their severity, and their development over time. This project aims to study the neurophysiology of speech and language perception in ASD. To do so, EEG signals were recorded as children listened to audio monologues. ASD is expected to change the way speech is processed by the human brain, especially with regard to lexical expectations. Results will inform us on the neural processing of speech in ASD and provide us with new objective neural indices of ASD.

128
Neuroscience and Mental Health .
This project aims to study the developmental trajectory of language processing in the first year of life, by using electrophysiology signals recorded with
lography (EEG) from infants as they were presented with nursery rhymes.”
The neurophysiology of auditory cognition across the lifespan . Dr Giovanni Di Liberto
“
Exploring early-life experiences and brain dynamics
Professor Mark Cunningham, Ellen Mayston Bates Professor of Neurophysiology of Epilepsy
Mark Cunningham holds a Professorial Chair in Physiology and is a Funded Investigator (FI) in the Science Foundation Ireland (SFI) national centre ‘FutureNeuro’ at RCSI. Cunningham leads a translational research group focused on understanding the basis of neurological and psychiatric disease at the level of the neuronal microcircuit and in the context of physiological and pathological electrical activity generated by the brain in certain disease states. Using a variety of research tools, including cutting-edge electrophysiology, the Cunningham research group uses preclinical animal models to examine the impact of early-life stress on neuronal dynamics.
Impact of variations in early life maternal care on brain activity
An increasing number of people spend their childhood and adolescence separated from their biological parents. We use a range of early life manipulations to specifically examine the impact of poor maternal care to allow mechanistic studies in experimental animal models. Recent work has demonstrated that a mild form of early life stress (for example, cross-fostering) produces changes in the ability of cortical microcircuits to generate oscillatory rhythms, in particular the gamma rhythm, in brain regions important for social cognition.

Chicken-Stress
This project aims to assess the impact of stress on organized electrical activity and associated behaviour using the chicken as a model system. A major contributory factor to variations in the stress response is the early life environment. Previous studies in rodents have indicated that early life stress can alter the expression of a specific type of brain cell (interneuron) and that reductions in this particular cell type alters how organized electrical activity is generated by brain structures crucial for processes of thought, experience and the senses. This work will allow us to identify how the environment in early life influence stress responsivity in the avian brain model. Moreover, this will allow us to use markers of brain activity to reduce stress and improve overall welfare for the egg production industry.
129
Neuroscience and Mental Health . Exploring early-life experiences and brain dynamics . Professor
Our preclinical work offers mechanistic insights that provide potential therapeutic strategy for disorders involving impaired sociability arising from early-life stress.”
Mark Cunningham . Professor Ellen Mayston Bates
“
Exploring typical neurodevelopment and mental health disorders
 Professor Arun Bokde, Associate Professor Psychiatry
Professor Arun Bokde, Associate Professor Psychiatry
Professor Arun Bokde leads the Cognitive Systems Group, is a principal investigator in the Trinity College Institute of Neuroscience, and a member of the Global Brain Health Institute (GBHI). Professor Bokde is a member the European wide consortium IMAGEN (Imaging in Genetics), a multi-centre longitudinal study of high-risk behaviours and mental disorders in adolescence and early adulthood. He is also a member of the Ireland-based Neonatal and Children’s Brain Consortium Ireland (NBCI), a multi-disciplinary consortium focused on research in neonatal brain and neonatal brain injury. Professor Bokde has published widely on the risk factors that lead to the development of mental health disorders in young and older populations.
The IMAGEN Study
Professor Bokde is co-PI (Ireland) for the IMAGEN multi-centre study, which is the first multicentre study including cognitive, behavioural, clinical, genetic, and neuroimaging study of a cohort of 2,000 adolescents from the age of 14 years. Professor Bokde is investigating how stress modulates the development of brain networks, using both functional MRI and diffusion weighted imaging. The studies have been until now cross-sectional in nature and with new longitudinal data, he will investigate the interaction between stress, biological and cognitive factors contributing to mental health disorders.
Brain Injuries in Neonates Study
During development the brain builds a series of large scale critical neural networks, and an injury such as perinatal asphyxia may lead to hypoxic-ischaemic injury to the brain and vital organs. Neonatal encephalopathy (NE) describes the babies who require resuscitation at birth and have an abnormal neurological examination. It remains difficult to predict their developmental outcome. The project will seek to use brain imaging data to quantify the functional integrity of the neural networks in NE infants and a group of healthy neonates. The project will advance our understanding of the brain changes occurring due to NE, and the associated cognitive and behavioural changes.
Network Lesions and Outcomes in Neonatal Encephalopathy Study
The brain development process has various critical periods, among them the pre- and peri-natal periods when the brain is changing very fast and any insult may lead to long term damage. The objective is to investigate the impact of brain injury on the structural and functional networks of the brain and the recovery process in the patient’s brain’s integrity. The proposed projects seeks to advance our understanding of this critical issue during early brain development and provide the basis for developing biomarkers for diagnosis and prognosis.
Functional brain changes in neonatal encephalopathy infants and associated behavioural and cognitive consequences (NEON)
The goal of this project is to investigate the functional brain changes in neonatal encephalopathy (NE) infants and the associated behavioural and cognitive consequences. The project will use brain imaging data (structural MRI, functional MRI, diffusion imaging) to quantify the functional integrity of the neural networks and examine potential associations with inflammatory markers and clinical phenotypes.
130
Neuroscience and Mental Health . Exploring typical neurodevelopment and mental health disorders . Professor Arun Bokde
The project will advance our understanding of the brain changes occurring due to neonatal encephalopathy, and the associated cognitive and behavioural changes.”
“
Child and Adolescent Psychiatry
 Professor Jane McGrath,
Professor Jane McGrath,
Associate Professor Consultant, Psychiatry
Professor Jane McGrath is a researcher and clinician, currently working as Associate Professor of Child and Adolescent Psychiatry in Trinity College Dublin, and as a Consultant Child and Adolescent Psychiatrist in the HSE Linn Dara Child and Adolescent Mental Health Services leading ADMiRE, a specialist service for children with Attention Deficit Hyperactivity Disorder (ADHD). From a research perspective, Jane has a background in using functional and structural neuroimaging to investigate neural connectivity in autism spectrum disorder. She is particularly interested in how brain connectivity influences behaviour, and her current neuroimaging research focuses on how changes in brain structure and function over time influence behaviour in children with ADHD. Professor McGrath’s research interests are largely driven by concerns that have arisen out of clinical practice, and she aims to improve both clinical practice and safety for patients through her research.
PRISM Study
Led by co-PIs Professors Jane McGrath and Rob Whelan, the PRISM study will use state-of-the-art home-based recording of brain activity alongside neurally informed computational modelling to develop a measure allowing clinicians to predict treatment outcomes in young people with ADHD.
Multimodal neuroimaging in ADHD
In collaboration with the ‘Neuroimaging of the Children’s Attention Project’, a comprehensive Australian longitudinal multimodal neuroimaging study, Professor McGrath’s group are investigating how brain structure and function changes with age in children with ADHD. Another neuroimaging project is investigating the acute effects of stimulant medication on brain function in young people with ADHD.
Clinical Research studies in ADMiRE
There are many clinical studies ongoing in ADMiRE, ADHD specialist service led by Professor McGrath. These studies are designed to improve clinical practice and outcomes for young people with ADHD and include studies that are investigating 1)sleep and ADHD, 2)the prevalence of ADHD in parents of young people with ADHD, 3) the impact of optimally treated ADHD on behaviour and quality of life, 4) the prevalence of Autism Spectrum Disorder in young people referred for ADHD assessment, 5) the factors influencing service-user satisfaction with care, 6) the beneficial impact of COVID-19 on the treatment pathway for young people with ADHD attending ADMiRE, 7) factors impacting on the transition of young adults with ADHD from child to adult services, 8) the clinical utility of an online resource for ADHD psychoeducation and 9) digital transformation of the ADMiRE clinical care pathway.
Details at: https://www.tcd.ie/medicine/psychiatry/ research/adhd/research/
131
Neuroscience and Mental Health . Child and Adolescent Psychiatry
. Professor Jane McGrath
The PRISM study will use state-ofthe-art home-based recording of brain activity.”
“
Cognitive neuroscience
 Professor Robert Whelan, Associate Professor in Psychology
Professor Robert Whelan, Associate Professor in Psychology
The vast majority of my research is directed towards answering clinically relevant questions, using a variety of methods. For example, one significant source of continued research was a prospective, longitudinal study predicting adolescent binge drinking using data from the IMAGEN study that combined several different types of data (neural, personality, cognitive, life history and genetic) to produce accurate models of the likelihood of future substance misuse. A second strand of current research investigates the neurocognitive endophenotypes (e.g., impulse control, sensory processing, reward sensitivity) associated with Attention Deficit Hyperactivity Disorder (ADHD). To this end, we examine (using both behavioural assays and EEG) relevant cognitive processes in individuals with ADHD, their unaffected first-degree relatives and unrelated control participants. A parallel study focuses on the role of anxiety in ADHD, and the processes that may differ between those individuals with ADHD with and without co-morbid anxiety.
IMAGEN
Professor Whelan works with research teams from London, Nottingham, Paris, Berlin, Hamburg, Mannheim and Dresden as part of the IMAGEN group. IMAGEN is a large European inter-disciplinary collaboration which combines brain imaging, genetics, and psychiatry to increase understanding of adolescent brain development and behaviour – namely, sensitivity to rewards, impulsivity, and emotional processing. The study has been following 2,000 young people and their parents from the age of 14, with follow-up assessments at ages 16, 19 and 22 years. Data was collected from participants and their parents, including imaging of brain structure and brain function, cognitive and behavioural assessments, questionnaires related to drug and alcohol use, psychosocial measures looking at factors such as relationships, feelings, and personality, as well as blood sampling for genetic and biological analyses.
Attention Deficit Hyperactivity Disorder (ADHD)
One strand of current research investigates the neurocognitive endophenotypes (e.g., impulse control, sensory processing, reward sensitivity) associated with ADHD. To this end, Dr Whelan’s team examines (using behavioural assays, EEG and MRI) relevant cognitive processes in individuals with ADHD, their unaffected first-degree relatives and unrelated control participants. Children with ADHD are three times more likely to suffer from anxiety disorders than those without ADHD. These symptoms often continue into adolescence and adulthood, negatively impacting quality-of-life. A parallel study focuses on the role of anxiety in ADHD, and the processes that may differ between those individuals with ADHD with and without co-morbid anxiety.
132
Neuroscience and Mental Health . Cognitive neuroscience
“
The long-term goal is to use information from brain imaging to improve diagnosis and prognosis of disorders such as ADHD and substance abuse.”
. Professor Robert Whelan
Attention Deficit Hyperactivity Disorder
 Professor Robert Whelan and Professor Jane McGrath
Professor Robert Whelan and Professor Jane McGrath
Understanding the mechanism of action of methylphenidate in ADHD: A computational psychiatry approach
This project aims to ultimately improve clinical management of children with ADHD. Methylphenidate, a stimulant medication, is used as the first-option pharmacological treatment for ADHD, is very commonly prescribed, and often successfully reduces problem behaviour. Although methylphenidate can be extremely effective, it does not work for every child. There is currently no ‘objective’ way (e.g. blood test or brain scan) to measure if a child is genuinely responding to methylphenidate. Instead, clinicians rely on reports from parents and teachers, an problematic approach that may lead to delays in optimising ADHD treatment. The absence of a biological test to quantify methylphenidate response is primarily because we do not understand exactly how methylphenidate changes behaviours to produce the known beneficial effects.
This project investigates the specific brain processes that are affected by methylphenidate using electroencephalography (EEG) and functional magnetic resonance imaging.
Predicting who will respond to stimulant medication in ADHD: A precision medicine approach using neurally informed computational models
There is an urgent need for objective measures to predict and determine treatment response in children with ADHD. This is a large study involving national multi-site recruitment of young people with ADHD who are starting on stimulant medication. Mobile (home-based, ‘dry’) EEG and behavioural data will be collected on children prior to and during psychostimulant (Methylphenidate) titration. We will use neurally informed computational models derived from the behavioural and EEG data to associate medication effects with distinct neural mechanisms.
133
Neuroscience and Mental Health . Attention Deficit Hyperactivity
There is an urgent need for objective measures to predict and determine treatment response in children with ADHD.”
Disorder . Professor Robert Whelan . Professor Jane McGrath
“
Professor Jane McGrath (Child and Adolescent Psychiatry) and Professor Robert Whelan (Psychology) are collaborating on two cutting-edge research studies that aim ultimately to improve pharmacological management of children with Attention Deficit Hyperactivity Disorder.
Our research is highly engaged: it embeds participant and patient involvement in research to ensure that our expected outcomes are truly translational and will help to reduce stigma and burden for individuals with MH conditions.
Genomics of Neurodevelopmental Disorders and Biomarkers
Professor Louise Gallagher, Chief of the Child and Youth Mental Health Collaborative, SickKids, University of Toronto and Professor of Child and Adolescent Psychiatry in Trinity College Dublin
Around 1 in 10 autistic people also have a rare genetic condition that may play a role in their symptoms. There are several such conditions, and each is very rare. The SynaG study is focused on two conditions called Phelan McDermid Syndrome and NRXN1 deletion. Around 800 people are known to have Phelan McDermid Syndrome, and around 70% of those also have autism. NRXN1 deletion is a separate condition which affects the gene called NRXN1. 30-70% of people with NRXN1 deletion also have autism. Not everyone who has one of these rare conditions will develop autism. In both of conditions, rare variations in genes affect the expression of proteins in nerve cells (neurons) which are the building blocks of the brain. Specifically, they affect the way neurons communicate at the synapse, the important junction between neurons that supports neuronal communication. Changes to the structure and activity of neurons could have broad effects on how a person learns, thinks, and behaves.
Risk, Resilience and Developmental Diversity in Mental Health? (R2D2-MH)
Individuals with mental health (MH) conditions and their families, especially those with highly prevalent neurodevelopmental disorders (NDDs), are exposed to high levels of discrimination and stigma, which significantly affects their physical and mental wellbeing. Our world-leading collaborative group at the forefront of research in NDDs will launch a new project: Risk, Resilience and Developmental Diversity in Mental Health (R2D2-MH). We propose a double paradigm shift to improve the wellbeing of people with MH conditions and their families. We will move (i) from risk-focused studies towards understanding and promoting resilience, and (ii) from a diagnosis-based approach to a developmental diversity approach that will define wellbeing and functioning across the human lifespan. R2D2-MH aims to identify genetic and environmental protective/resilience factors and how they influence developmental diversity and MH. We will investigate at multiple levels two highly prevalent early risks for MH conditions: prematurity and genetic liability for NDDs.
Our project has four main ambitions:
1. Provide the largest European multi-scale dataset on early human brain development and MH outcomes; 2 Identify biological mechanisms of resilience to the adverse effects of NDD;
3. Co-develop, with the stakeholders, new digital tools to increase participatory research/medicine and reduce stigma; 4. Establish predictive models to guide personalised interventions.
R2D2-MH integrates interdisciplinary and complementary expertise across Europe, Israel, and Australia that covers ethics, epidemiology, sociology, genetics, cell biology, neuroscience, computational modelling, Information Technology, psychology, and psychiatry. Our research is highly engaged: it embeds participant and patient involvement in research to ensure that our expected outcomes are truly translational and will help to reduce stigma and burden for individuals with MH conditions.
The Synaptic Gene Study (SynaG )
The SynaG study is investigating if there are any characteristic features in individuals with these rare genetic conditions that have been associated with autism. We are studying brain development, cognition, emotion and social skills in people with Phelan McDermid Syndrome or NRXN1, compared to individuals who have autism with no known cause, and compared to typically developing individuals. It also aims to identify the ways in which the conditions are similar and different to autism. At Trinity, we focus on carriers of NRXN1 deletion while our collaborator, Dr. Eva Loth, at Kings College London is studying Phelan McDermid Syndrome.
We have four main objectives:
1. To understand the frequency of autism in Synaptic Gene conditions.
2. To understand similarities or differences in clinical profiles with ASD.
3. To identify stratification biomarkers.
4. To better understand genetic heterogeneity.
134
Neuroscience and Mental Health . Genomics of Neurodevelopmental Disorders and Biomarkers . Professor Louise Gallagher
“
The team observed differences in brain connectivity in NRXN1 deletion carriers using resting state MRI in regions of the brain implicated in attention and visual processing. Our collaborators found that the neurons from carriers of NRXN1 deletion are more excitable.
Social cognition and social reward in Prader Willi Syndrome and relationship to autism spectrum disorder symptoms and oppositional behaviours
Prader Willi Syndrome (PWS) is a rare genetic disorder that results in a number of physical, mental and behavioural problems. Professor Louise Gallagher leads a research group investigating some of the challenging behaviours and symptoms associated with this condition.
A key feature of PWS is a constant sense of hunger beginning at about 2 years of age. Autism symptoms and atypical social behaviour are prevalent in PWS. Social cognition (the ability to perceive and understand the thoughts and feelings of other people) differs in Autism Spectrum Disorder (ASD) compared with typically developing people and is thought to be related to the manifestations of ASD. Studies suggest that social cognition is also altered in PWS but this has not been evaluated widely and the relationship with ASD symptoms remains untested.
This project will determine if atypical social cognition underlies ASD symptoms in PWS, if it contributes to oppositional behaviours, and if there is an effect of

altered social reward processing that drives poor social understanding. Reward circuitry, which responds and places values on things in our environment, is fundamentally impaired in PWS and contributes to hyperphagia.
The study will investigate if social reward has less value for people with PWS and if this is related to increased value of food. The team will evaluate social cognition and social reward alterations in PWS using cognitive tests, clinical assessments (EEG, eye tracking), and biomarker studies.
Validation of an eye-tracking attentional bias paradigm as a biomarker for satiety in PWS
This study aims to develop a novel and objective biomarker for altered satiety and hyperphagia in PWS using an eye-tracking method to measure attentional bias (AB) to food. The Trinity College Autism and rare NDD lab, previously showed that young adults look longer at food than non-food when they are hungry rather than just after eating. This response may not be present in individuals with PWS as they have a fundamental deficit in satiety. In this study, the experimental paradigm will be adapted for people with PWS in collaboration with professionals and parent/ caregivers. The eye-tracking experiment will be conducted in individuals with PWS versus age- and gender-matched controls. This research is important as there are no objective biomarkers of hunger/ satiety for PWS which is a barrier to test new therapies.
135
Neuroscience and Mental Health . Genomics of Neurodevelopmental
and Biomarkers
“
This project will determine if atypical social cognition underlies ASD symptoms in PWS, if it contributes to oppositional behaviours, and if there is an effect of altered social reward processing that drives poor social understanding.”
Disorders
. Professor Louise Gallagher
Multisensory perception in children
 Professor Fiona Newell, Professor of Experimental Psychology
Professor Fiona Newell, Professor of Experimental Psychology
The Multisensory Cognition lab at TCIN is interested in understanding how children use information from different sensory systems to form a coherent perception of their world and to acquire knowledge. Their focus is on neurotypically developing children, but the research also involves children with visual impairments.
Multisensory object categories Project
The human brain has an exceptional ability to organise information received from the senses to allow us to perform everyday tasks such as recognise and distinguish between objects. The cognitive and neural processes that underpin this ability, however, are poorly understood, especially during development. Yet, such knowledge is important for understanding the brain, and supporting brain functions in both health and disease. The aim of this proposal is to establish how the developing brain acquires, processes and organises information about objects from the senses into meaningful categories that adapt to task demands. The work builds on recent advances in perceptual neuroscience and Virtual Reality technology.
The ‘weDRAW’ Project
The weDRAW project is based on recent neuroscientific findings of the role of communication between sensory modalities during development: each sensory system is optimised to learn specific concepts. Starting from these results, the weDRAW researchers are developing multisensory technology and serious games that will exploit the best sensory modality to facilitate learning of arithmetic and geometrical concepts in children. Apart from the application to typically developing children, a major goal and output of this project is to apply the proposed multisensory approach and technologies to two specific populations: visually impaired and dyslexic children.
136 Neuroscience and Mental Health . Multisensory perception in children . Professor Fiona Newell
The development of conscious awareness in infancy
Dr. Lorina Naci, Associate Professor of Psychology
A major focus of the Naci Lab is the investigation of the brain organisation supporting human cognition and consciousness, from how this organisation develops in infancy to how it breaks down in the disordered brain. Relatedly, we also investigate the early biomarkers of Alzheimer’s disease by combining neuroimaging, clinical, neuropsychological, and physiological assessments.
The development of the brain circuitry for conscious awareness in infancy
Great theoretical and empirical advances have been made in understanding conscious awareness in human adults, but it remains unknown whether conscious awareness is developed in neonate infants, or whether it emerges later in development.

Brain network dynamics in human infants
The adult brain exhibits an elegant topology of network dynamics, which guarantees high capacity for local and global information transformation. It remains unknown whether the neonate brain has a similar topology as the adult brain, and whether its organization is affected by prematurity and infant age. Our findings in these projects will improve understanding of the capacity for conscious experience in infancy, and the impact of premature birth and early infant age on its development.
Neuroscience and Mental Health . The development of conscious awareness in infancy . Lorina Naci 137
Our findings will shed light on the disrupted brain mechanisms that underlie issues of infant development associated with premature birth from the first few months of life.”
“
Antenatal depression and infant development
Professor Veronica O’Keane, Professor in Psychiatry & Consultant Psychiatrist
Professor O’Keane’s research group study clinical depression (Major depressive Disorder, MDD) during pregnancy and maternal infant development in the first three years of life.
Antenatal depression and the impact on infant development
This is a series of studies assessing the impact of depression during pregnancy on infant cognitive, language and motor development at six months, twelve months, and 2 and 3 years using a prospective longitudinal study design. These studies have shown that depression during pregnancy is common among women in Ireland. Infants born to women with depression had lower motor developmental scores, as well as lower language scores at 1 year. At 2 years, infants born to women with Major Depressive Disorder (MDD) during pregnancy had greater adaptability than those born to women without MDD. If treated, depression during pregnancy had little if no impact on baby development, but ongoing depression had a negative impact on the baby’s development.
Perinatal depression and the HPA axis
This study examined the effect of MDD on the hypothalamic-pituitary-adrenal (HPA) axis in pregnant women and the effects, if any, on infant HPA axis in the first three years of life. Results have shown that pregnant women had higher cortisol levels than women who were not pregnant. Women with a history of early child adversity (ELA) had higher cortisol secretion during pregnancy than either healthy pregnant women without ELA, or women with MDD without ELA.

138
Neuroscience and Mental Health . Antenatal depression and infant development . Professor Veronica O’Keane
“
The long term expected impact is to better understand the risks and consequences of perinatal MDD on infant development and well-being”
Child Health & Wellbeing
 Dr. Lorraine Swords, Assistant Professor in Child & Adolescent Psychology
Dr. Lorraine Swords, Assistant Professor in Child & Adolescent Psychology
Lorraine leads a programme of research at Trinity that centre on child health and wellbeing. Together with her students and collaborators, she researches, presents, and publishes on topics relating to (i) peer interactions in the context of physical or mental health conditions, focusing on help-seeking, help-giving and stigmatizing responses, and (ii) the impact and correlates of encountering adversity in childhood.
REFUGE-ED
Providing refugee children with access to quality education and a socially inclusive, supportive, learning environment is key to restoring their emotional security and sense of place. Along with Professors Frédérique Vallières and Elizabeth Nixon, Lorraine leads the Trinity team working on REFUGE-ED, a Europe-wide, EU-funded, project exploring effective practices in education, mental health and psychosocial support for refugee students. At present 46 schools, institutional care facilities, and reception centres in Spain, Italy, Greece, Ireland, Sweden, and Bulgaria have been selected to participate in the project.
Childhood Adverse Experiences
Encountering potentially traumatic events or circumstances in early life can negatively impact upon children’s present development and cast long shadows forward into the later lives of the adults they will become.
Lorraine works on a number of projects that identify and evaluate supports for children and their families who have experienced such adversity. For example, along with her colleague from TRiCC, Professor Trevor Spratt, she has recently completed an evaluation of Dublin Safer Families, a service that works with parents and children to increase family safety while preventing and stopping domestic abuse.
ADAPT
Young people have experienced many changes in their lives since the beginning of COVID-19. Lorraine and her Trinity colleague Professor Elizabeth Nixon and NUIG colleague Professor Caroline Heary are working together to understand more about the impact of the pandemic on young people’s mental health and wellbeing. Almost one thousand adolescents from across the country have participated in a survey to share ideas about what helped them adjust to the restrictions that bound their lives for the last two years and what has helped them to cope.
139
Neuroscience and Mental Health . Child Health & Wellbeing
Providing refugee children with access to quality education and a socially inclusive, supportive, learning environment is key to restoring their emotional security and sense of place.”
. Assistant Professor Lorraine Swords
“
Parent-Child Interaction & Children’s Development
Dr. Elizabeth Nixon, Associate Professor, Psychology & Dr. Jean Quigley, Assistant Professor, Psychology
Professors Nixon and Quigley use observational methods to study how parents interact with their infants and how these interactions shape development, including their language, cognitive, social and motor skills. We are particularly interested in understanding how the characteristics of infants, such as having a developmental disability or being born preterm, elicit different behaviours from parents as they care for, play with, and talk to their babies. In addition to observing and analysing parent-infant interaction, we conduct full developmental assessments of babies, and then follow up these families during toddlerhood and early childhood. This helps us to understand how early interactions between mothers, fathers, and their babies shape development across time.
PETIT: Preterm Infant Interaction and Development
Preterm birth (≤ 36 weeks gestation) represents a growing public health concern, accounting for more than 11% of live births worldwide. With medical advances, more infants born earlier than ever before are surviving extensive stays in Neonatal Intensive Care Units (NICUs). As they grow, infants born preterm experience a higher risk of developmental difficulties, but we are only beginning to understand the pathways that lead to these difficulties. The PETIT study aims to track the development of a sample of preterm infants beyond the early months of life into the third and fourth years. The second aim is to characterise preterm infant-parent interactions as quality of interaction is an important predictor of developmental outcomes.
PANDA: Psychological and Neuro-Developmental Assessment of Neonatal Encephalopathy
Neonatal Encephalopathy (NE) is a neurological condition that may arise in an infant from the 36th week of pregnancy through to childbirth. Affecting approximately 3 in 1000 births per year, it is suggested that the effect of NE on a child’s development is variable. The PANDA study, part of the HRB Neonatal Encephalopathy PhD Training Network, aims to extend and clarify our understanding of those who have experienced NE. Combining gold-standard developmental assessment, with rich data derived from the observation and analysis of parent-infant interactions, we hope to refine the developmental prognosis of those affected by the condition and to facilitate future intervention as early in life as possible.
DIAMOND: Dyadic InterAction in Down SyndroMe & Outcomes for Neuro-Development
With a team from the National Children’s Hospital, we are studying the profile of strengths and weaknesses in
children with Down Syndrome (DS). We are especially interested in investigating the role of parent-child interaction, with a view to understanding how both mothers, fathers, and early intervention therapists may support the development of children with DS.
LEAP: Links between Early parenting and Academic Performance
LEAP is a longitudinal study that follows the development of children from infancy through to early childhood – a period during which children prepare for and begin school. Given that parents are children’s primary teachers during the first years of life our first aim is to explore how various aspects of mother- and father-infant interaction might contribute to children’s language, cognitive and social skills all of which are important indicators of early academic performance. Our second aim is to compare mother-infant and father-infant interactions during infancy and to explore how mothers and fathers might influence child development in similar, different, or complementary ways.
EMERALD: Eye Movements & early markers of Atypical Language Development in Down syndrome
This study examines basic-level neuropsychological differences that contribute to language development in toddlers with Down Syndrome. EMERALD’s goal is to provide a methodology that examines how toddlers with Down syndrome access and use sensory input from mouth movements. EMERALD also explores the role of medical covariates, sensory processing profiles, emotional/behavioural characteristics, and social competencies for individual differences in audio-visual attention. The researchers on this study also adapted their experiment for moderated online delivery.
140
Neuroscience and Mental Health . Parent-Child Interaction & Children’s Development . Dr.
Dr.
“
We hope to refine the developmental prognosis of those affected and to facilitate future intervention as early in life as possible.”
Elizabeth Nixon .
Jean Quigley
Mental Health and Well Being
Professor Agnes Higgins, Professor in Mental Health, School of Nursing and Midwifery and Trinity Center for Practice and Health Care Innovation
Professor Higgins leads a programme of research in mental health. As a leader of multidisciplinary and multiinstitutional research bids with internationally recognised partners and in line with a key priority of government and national/international mental health policy, her research programme is focused on building a body of work that promotes mental health recovery, drives mental health service reform, and improves mental health practice. She has led many research teams to successful completion of diverse projects, including research with young people and the LGBTQI+ community.
Being LGBTQI+ in Ireland
Being LGBTQi+ in Ireland is a cohort study into the mental health and well-being of LGBTQI+ people in Ireland, including a nationally representative public attitudes survey towards LGBTQI+ people. Findings from both studies will be compared with findings from the first national study of the mental health and wellbeing of lesbian, gay, bisexual, transgender and intersex people in Ireland which was published in 2016 (Higgins et al. 2016), with a view to assessing progress since marriage equality.
Key findings in relation to LGBTI+ youth will be a critical focus of the analysis, as the 2016 study reported elevated levels of suicidal behaviour and self-harm, worrying levels of severe and extremely severe stress, anxiety and depression, and very challenging school environments with adverse impacts on mental health.

141
Neuroscience and Mental Health . Mental Health and Well Being . Professor Agnes Higgins “
The findings will be used to guide recommendations for policy, education service provision, and legislation going forward.”
Contemporary perspectives on adolescent mental health
Dr Alina Cosma
(MSCA IF) School of Social Sciences and Philosophy & Dr Yekaterina
Chzhen (Host Supervisor)
Mental health problems are becoming a leading cause of disease burden amongst adolescents globally, and poor adolescent mental health has been linked with poor long-term adult health morbidity and mortality. Monitoring adolescent mental health is key for understanding whether efforts to improve young people’s mental health at a national and international level are successful. This line of research aims to investigate variations and cross-national trends in adolescent mental health, and to analyse changes in within-individual mental health as children progress through adolescence. The planned research activities will be carried out by analysing data from well-established national (Growing up in Ireland) and cross-national (Health Behaviour in School-aged Children) surveys.
There is no health without mental health, and the foundation of the latter is largely laid in adolescence. Recent evidence indicates that today’s adolescents (i.e. Generation Z) experience worse mental health than the preceding generation (i.e. the Millennials).
The EU-funded GenerationZ project aims to examine individual changes in adolescent mental health, and assess cross-national variation and trends in population-level adolescent mental health across 40+ European countries. The project’s work is in line with the 2030 Sustainable Development Goals and the European regional and national health strategies.

142
GenerationZ – Marie Skłodowska-Curie Action
Neuroscience and Mental Health . Contemporary perspectives on adolescent
mental health . Dr Alina Cosma . Dr Yekaterina Chzhen
“
The long term impact is to identify predictors of change over time in adolescent mental health at crossnational level.”
Improving Education for GPs regarding Adolescent Mental Health
 Dr. Dónal Wallace, Assistant Professor in General Practice, Institute of Population Health, Public Health
Dr. Dónal Wallace, Assistant Professor in General Practice, Institute of Population Health, Public Health
& Primary Care
Dr. Dónal Wallace is an Assistant Professor in General Practice at Trinity College Dublin. He also practices as a GP in North Dublin. His research interests centre on youth mental health, medical education, CME small group learning and public & patient involvement in research. Dónal's current research programme is focusing on the development and evaluation of a CME educational tool designed to equip GPs in Ireland to manage adolescent mental health presentations.
Development and evaluation of a CME educational tool designed to equip General practitioners (GPs) in Ireland to manage adolescent mental health presentations
Youth suicide rates in Ireland are above the European average, and research has highlighted that there has been a notable increase in anxiety and depression among young people in Ireland over the past 10 years. In addition, there is great concern that the social control measures introduced during the Covid-19 pandemic are likely to have ongoing mental health impacts on our adolescent population. GPs are often the first point of contact for Adolescent Mental Health presentations, and form a critical point in the care pathway. However, many GPs do not feel equipped to confidently deal with adolescents presenting with mental health issues.
Studies have also shown low satisfaction ratings from GPs in Ireland regarding the postgraduate training they receive in child and adolescent mental health. This study aims to address the knowledge gaps of GPs in the area of Adolescent Mental Health, by developing a research informed teaching tool which will provide a valuable foundation of knowledge for GPs in this important area. Adolescents, parents and GPs will be invited to take part in focus groups to gather information on what they identify as good practice for managing Adolescent Mental Health presentations in primary care. These qualitative data, together with a literature review, will inform the development of a new teaching tool for GPs. The final stage of the study will involve a pilot cluster RCT to evaluate the feasibility and impact of the educational tool intervention delivered to GPs.
143
Neuroscience and Mental Health . Improving Education for GPs regarding Adolescent Mental Health
. Dr. Dónal Wallace
“
This project aims to directly influence the policy around GP training on Adolescent Mental Health through the Irish College of General Practitioners.”
Birth asphyxia and neuroinflammation
Dr. Eva Jimenez-Mateos, Assistant Professor, Physiology
Dr Jimenez-Mateos uses pre-clinical models of birth asphyxia to evaluate and understand the mechanism underlying neonatal brain damage. 2% of babies may develop complications during birth, including reductions in the level of oxygen to the brain and seizures. The effect of hypoxia-seizures on the brain and development of babies is poorly understood. We know that babies suffering from hypoxia-seizures will develop neurological outcomes and current therapies are not effective in 50% of infants. Dr Jimenez-Mateos laboratory studies the role of inflammation in how hypoxia affect brain development and explore ways to improve outcomes.
Inflammation after neonatal brain damage

Birth asphyxia or neonatal hypoxia is a medical condition resulting from deprivation of oxygen to a new-born infant that lasts long enough to cause harm, usually to the brain. It remains a serious condition which causes significant mortality and morbidity. Neonatal hypoxia is a global insult, which can damage all organs, but the brain is especially vulnerable to hypoxia, making it the special concern for clinicians. Indeed, in a proportion of the infants, brain damage will manifest as either mental, such as developmental delay or intellectual disability, or physical, such as cerebral palsy.
Perinatal asphyxia happens in 2 to 10 per 1000 new-borns that are born at term, and a higher proportion in babies born prematurely.
The World Health Organization (WHO) estimates that 1 million neonatal deaths occur yearly due to birth asphyxia, representing 38% of deaths of children under 5 years of age.
The effect of perinatal asphyxia on the brain and development of babies is poorly understood. We know that babies suffering from hypoxia may develop neurological outcomes and current treatment are not effective in a subset of infants, more importantly current treatments present a short time-window to be effective and need to start within the first 6 hours after birth, e.g. therapeutic hypothermia.
Dr. Jimemez-Mateos studies the role of inflammation in hypoxia and how this affects brain development and explore ways to improve neurological outcomes. To achieve this, the team will use a combination of pre-clinical models and pharmacological approaches. They evaluate novel therapeutic targets to improve infants’ condition and, also, the therapeutic window by testing the efficacy of anti-inflammatory drugs in later life.
144
Neuroscience and Mental Health . Birth
“
The long term expected impact is to better understand the mechanisms which trigger long-term outcomes after birth asphyxia.”
asphyxia and neuroinflammation . Dr Eva Jimenez-Mateos
Rett Syndrome and related neuropsychiatric disorders
 Dr. Daniela Tropea, Associate Professor of Psychiatry, School of Medicine
Dr. Daniela Tropea, Associate Professor of Psychiatry, School of Medicine
I study brain development in health and disease with a focus on growth factors involved in synaptic function and plasticity. I was the first to pioneer the use of insulin-like growth factor 1 (IGF1) and its related molecules for the treatment of Rett Syndrome and related disorders, and I worked with scientists and clinicians in international centres to clarify the mechanisms and the efficacy of these drugs. Now one of these compounds: Trofinetide, has passed phase III clinical trials for Rett Syndrome and phase II clinical trials in RTT, and it is under FDA consideration as the first pharmacological treatment for Rett. IGF1 is now in trials for idiopatic autism and other disorders of the autism spectrum.
Uncovering the molecular mechanisms of Trofinetide
This project, funded by the International Rett Syndrome Foundation aims to study the molecules and cellular pathways activated by the administration of Trofinetide (a drug used for the treatment of Rett syndrome). Rett syndrome is a neurodevelopmental disorder characterized by typical early growth and development followed by a slowing of development, loss of functional use of the hands, distinctive hand movements, slowed brain and head growth, problems with walking, seizures, and intellectual disability. The team will study the expression of RNA and metabolites in blood samples from patients enrolled in a phase II clinical trials. The outcome of this research will be helpful to design future clinical research and to analyse the efficacy of these compounds.
DATARETT: a data sharing platform for Rett Syndrome
This project aims to collect demographic data from patients with Rett syndrome in Ireland and to establish a data sharing platform for a global data sharing for Rett syndrome. Besides advancing Rett research by contrasting the limitations dictated by the rarity of the disorder, this research will increase the visibility of the Irish population of Rett patients. This is the first study on patients in Ireland and will allow them to participate to international studies.
145
Neuroscience and Mental Health . Rett Syndrome and related neuropsychiatric disorders . Dr
“
This is the first study on patients in Ireland and will allow them to participate to international studies.
Daniela Tropea
Predicting childhood development after neonatal brain injury
Dr. Jason Wyse, Assistant Professor, Statistics, School of Computer Science & Statistics
Dr Jason Wyse is a research statistician with an interest in classification and uncertainty quantification in medical and public health settings. His work often focuses on challenges which require the development of bespoke, application driven, modelling tools and methods. He is interested in open research and reproducibility and has developed several open-source software packages in areas such as network analysis, classification, environmental exposures, and clinical trial planning.
Data driven scoring for childhood development in neonatal brain injury
In collaboration with Professor Eleanor Molloy (Paediatrics) and Professor Arthur White (Statistics), Dr Wyse is creating statistical models to characterise heterogeneity in childhood developmental outcomes of infants with Neonatal Encephalopathy (NE). These novel approaches aim to classify and predict an infant’s developmental progression in childhood using data from their early weeks of life. This classification can be viewed as a data driven scoring method for NE outcomes. This project uses data gathered through Professor Molloy’s Follow-up of Inflammatory Responses and multiorgan outcomes FoLlowing neonatal brain injury (FIREFLY) project.
While there are established scoring methods for the severity of NE in infants, these were not designed to discriminate differences in childhood developmental outcomes.

These scoring approaches are arrived at through only physical examination of the infant and do not harness the many other rich sources of information now routinely available. For example, markers of the immune system and the presence of multi-organ dysfunction could tell us much more about the infant and are likely to be more pervasive and influential in early childhood development.
Our data driven scoring approach for classifying childhood developmental outcomes will use methods from Bayesian statistical science to deliver a scoring method with an associated calibrated uncertainty. These Bayesian ideas will also be used to address two key meta questions in creating a scoring; what data from the early weeks of life tells us most about what will happen in childhood development? how many levels should the scoring method use to distinguish the developmental outcomes that have been observed in clinical settings?
146
Neuroscience and Mental Health .
“
What data from the early weeks of life tells us most about what will happen in childhood development?.”
Predicting
childhood development after neonatal brain injury . Dr Jason Wyse
Feeding and Swallowing Disorders in Infants
Dr Margaret Walshe, School of Linguistic, Speech and Communication Sciences
Dr Margaret Walshe’s research focuses on swallowing difficulties across the lifespan and the amalgamation of evidence to improve research and clinical practice. One focus since 2015 is neonatal feeding and swallowing problems. A growing number of premature infants are born worldwide, and these infants spend considerable time in neonatal intensive care units (NICU). Typically, they can leave the NICU when they are able to feed by mouth. This has involved 2 key projects for our group. The first – a large scale epidemiology study in Cyprus is complete. The second – a Cochrane Review and COS on oral interventions to improve care is ongoing.
Oral stimulation for promoting oral feeding in preterm infants

With Zelda Greene and Prof Colm O Donnell (National Maternity Hospital, Holles St), the team completed a Cochrane systematic review on oral stimulation for promoting oral feeding in preterm infants. The findings now strongly support oral stimulation in preterm infants, showing that these can reduce time for the infant to transition to oral feeding, also reducing the duration of hospitalisation and the duration of parenteral nutrition.
One of the difficulties in amalgamating this evidence was that there were no core outcomes evaluated across clinical trials. In 2021, the commenced the development of the first phase of a core outcome set (COS) for oral interventions in neonates. A scoping review of outcomes – which evaluated how and when they were measured across all clinical trials in this area – was completed and a paper based on this work is currently under review.
147
Neuroscience and Mental Health . Feeding and Swallowing Disorders in Infants . Dr Margaret
“
This work positions us well for a clinical trial in this area. The Cochrane review is already used by the World Health Organisation.”
Walshe
Rare neurodevelopmental disorders research
Dr. Massimiliano Bianchi, Founder/President & CEO, Ulysses Neuroscience Ltd; Adjunct Assistant Professor, Trinity College - Institute of Neuroscience (TCIN), Trinity College Dublin, Lloyd Institute; Adjunct Associate Professor, Department of Chemistry, University of Maynooth
Ulysses Neuroscience Ltd. is an Irish SME that provides clinical and preclinical research services to pharmaceutical companies to accelerate their drug discovery programmes in neuropsychiatric and rare neurological disorders. Ulysses has three core values which directly drive our research and interaction with pharmaceutical companies: Patient-Centricity, Translational Research and Social Responsibility. The company specialises in fluid biomarker analysis in conjunction with existing clinical assessments as well as in preclinical transgenic and pharmacological models.
An overview of our current projects and patient-centric initiatives on paediatric rare neurodevelopmental diseases such as CDKL5 Deficiency Disorder and Fragile X Syndrome is provided below. Future projects on Angelman Syndrome and Rett Syndrome are currently under discussion and planning.
Plasma microtubule proteins as potential biomarkers for CDKL5 Deficiency Disorder (CDD)
CDD is a rare neurodevelopmental disorder mainly affecting females caused by mutations of the Cdkl5 gene. It is characterized by early-onset seizures in the first months of life, intellectual disability, motor, sleep and social impairments. Currently, no therapies exist for CDD and patients are treated for temporary relief of the most disturbing symptomatology. The CDKL5 protein is apparently mainly expressed in the brain where modulates development and morphology of neuronal cells. The molecular basis for such defects is not clear but evidence suggests that it may depend on altered microtubule dynamics. Microtubules are cytoskeletal elements playing vital roles in development of brain cells, supporting the formation, maintenance and remodelling of synapses, structures through which brain cells communicate. Dysfunction in microtubule dynamics leads to altered brain development and loss of synapses. Microtubule dynamics can be analyzed by measuring the post-translational modifications (PTMs) of the alpha-tubulin protein, the main building block of microtubules. We have recently discovered that alpha-tubulin PTMs can be detected in peripheral fluids, such as blood plasma and cerebrospinal fluid (CSF) in both animals and humans. Pilot studies showed that behavioural alterations in Cdkl5 knock-out (KO; lacking the gene) mice were accompanied by changes in alpha-tubulin PTMs in the brain and plasma of Cdkl5-KO mice.
Syrens: A Neurolinguistic study to assess cognitive abilities and develop composite biomarkers in Fragile X Premutation Carriers.
Fragile X syndrome (FXS) is the leading inherited cause of intellectual disability and it is caused by heterogeneous mutations of the Fmr1 gene that produces a protein fundamental for brain development and plasticity (FMRP). FXS is linked to the full mutation of the gene (more than >200 CGG nucleotide repeat expansion), while the premutation (55-200 CGG repeat expansion) can lead to various conditions including a Parkinson-like neurodegenerative disorder named Fragile X Tremor Ataxia Syndrome (FXTAS). Currently there is no cure for FXS or no possibility to prevent and cure FXTAS; biomarkers of disease progression are needed to anticipate diagnosis and accelerate treatment discovery.
More studies targeting both FXS children and premutation carriers are needed to account for the quality of life of all people affected by the gene mutations, which can only be achieved by including both parents and children in the studies.
148 Neuroscience and Mental Health . Rare neurodevelopmental disorders research . Dr. Massimiliano Bianchi
“
This study will help build strong foundations for potential new targets for the treatment of CDD.”


Research
Doctoral
Doctoral Research
Current Child Health Doctoral projects by Centre of Excellence
Neonatal Encephalopathy PhD Training Network
• PANDA: Psychological And NeuroDevelopmental Assessment of Neonatal Encephalopathy (TCD)
• COHESION: Developing a Core Outcome Set for use in clinical trials, and other studies, for interventions for the treatment of Neonatal Encephalopathy (NUIG )
• NEON: Investigate the functional brain changes in neonatal encephalopathy (NE) infants and the associated behavioral and cognitive consequences (TCD)
• PUFFIN: Point of care ultrasound for functional multi-organ evaluation in neonatal encephalopathy
• CRADLE: Circadian Rhythm Alterations and outcomes in neonatal Encephalopathy
Paediatrics Discipline School of Medicine
• POLARIS project: Paediatric Traumatic Brain Injury and Outcomes using miRNAs
• FIREFLY project: follow up of inflammatory responses and multiorgan outcomes Following neonatal brain injury
• PLATYPUS: Preterm Inflammatory Hyperreactivity and response to pentoxifylline to understand necrotising enterocolitis and sepsis.
• DREAM: Down syndrome, neurodevelopment And Multiorgan outcomes
• Persistent systemic inflammation in Neonatal Encephalopathy
• NIMBUS project co-ordinator and GENIE: Gender differences in preterm neonatal outcomes and mechanisms of altered immune function
• PRISM: Preterm Infection and Systemic Inflammation and Neonatal Outcomes
Psychiatry Discipline School of Medicine
• Inflammatory markers of antipsychotic weight gain and cardiometabolic dysfunction in youth mental health disorders
• Influences of social cognition and reward processing on autism symptoms in Prader-Willi Syndrome
• The Contribution of Other hits to ND-CNV Carrier Neurodevelopmental and Neuropsychiatric Phenotypes
• Predicting who will respond to stimulant medication in ADHD: A precision medicine approach using neurally informed computational models
• Towards an understanding of the mechanism of action of methylphenidate in ADHD
• Longitudinal neuroimaging in children with ADHD
• Predicting who will respond to stimulant medication in ADHD: A precision medicine approach using neurally informed computational models
• Shame and Child Sexual Abuse
• Predicting who will respond to stimulant medication in ADHD: A precision medicine approach using neurally informed computational models
Clinical Medicine Discipline
• Characterisation of the Epithelial barrier in early life and in atopic dermatitis
Molecular Rheumatology Discipline
• Arthritis in Children with Down’s Syndrome is a Distinct and a more Pathogenic Disease Compared to Juvenile Idiopathic Arthritis
151
Doctoral Research . Contents
Public Health & Primary Care Discipline
• Antibiotic use in early childhood and risk of obesity.
• Child health and survival in urban slums in Malawi: healthcare seeking practices and relative significance of health system factors in influencing care seeking decisions among care givers of under-five children
Immunology Discipline
• The role of nutrition as a determinant of clinical, immunological and pharmacological outcome in HIV-infected children in Uganda
• Examining the role of lymphocytes in neonatal brain injury
Therapy Disciplines
• Back pain in adolescent sport
• An Investigation into the Effectiveness of an occupation focused self management programme for college students experiencing mental health difficulties
• Using Rasch analysis to refine the psychometric properties of the Electronic Trinity Student Profile (eTSP; Nolan, 2011).
• The Development of a complex occupational therapy intervention for neonatal units in Ireland
• An exploration of Occupational Therapy Practice with Children experiencing Complex Trauma
• Mobility assistance dogs and the impact on activity levels, gait patterns, balance and quality of life in children with cerebral palsy and neurological impairments.
• Prenatal predictors across biopsychosocial levels of birth outcomes, sensorimotor development and mental health in childhood.
• The relationship between motor ability and the development of self-care skills in preschool children.
• Refining the Psychometric Properties of the Trinity Student Occupational Performance Profile (TSOPP) – A self-report measure of occupational performance difficulties within the student role.
• Development of a physiotherapy screening tool for paediatric joint hypermobility: A move towards targeted treatment
• A National Adolescent Idiopathic Scoliosis Physical Wellbeing Study
• Development of a physiotherapy decision-making tool for paediatric symptomatic hypermobility: A move towards targeted treatment
• Cardiorespiratory fitness, physical activity and health-related quality of life in survivors of childhood central nervous system tumours in Ireland
• An intervention using a Personalised VR Dance Tutor with Progress Monitoring for Survivors of Childhood Cancer
School of Psychology
• PETIT: Preterm Infant Interaction and Development
• DIAMOND: Dyadic InterAction in Sown SyndroMe & Outcomes for Neuro-Development
• LEAP: Links between Early parenting and Academic Performance
School of Nursing & Midwifery
• Impact of chronic pain on adolescents' school functioning: A systematic review.
• An evaluation of the effectiveness of a child protection programme for health care providers in the detection and reporting of child abuse in a hospital setting
• Factors That Impact the Continuation of Exclusive Breastfeeding Practice Among Working Mothers in Saudi Arabia.
• To explore access to respite care for children with an autism spectrum disorder at the acute and primary care interface from the perspective of parents
• Multi-perspectives of the lived experience of risk and protective factors of children of parental substance misuse: children, parents, grandparents, and service providers
• The meaning given to care delivery to children with complex care needs in paediatric intensive care units by physicians and nurses during the coronavirus disease pandemic
• Alcohol use, health related quality of life and related harms: Exploring the risk and protective
152
Doctoral Research . Contents
factors for young people living in urban disadvantage
• Developing an integrated care plan for the treatment of substance use disorders in adolescents.
• Evaluating the Experiences, Coping Mechanisms and Supports of Fathers who have a Child with a Rare Chromosomal Abnormality
• The voice of the PICU nurse at the point of initiation of long term ventilation.
• Family-Centred Care for Children and Adolescents in the Acute Hospital Setting
School of Linguistics, Speech and Communication Sciences
• Prevalence nature and characteristics of feeding and swallowing disorders in preterm infants admitted to a neonatal intensive care unit in Cyprus over a 3-year period
• Exploring the phenomenon of ‘diagnosis’ in Ireland: An interpretative phenomenological analysis of the lived experience of mothers whose children have undiagnosed and rare neurodevelopmental disorders.
• An Interpretative Phenomenological Analysis of the daily living experiences of parents parenting a child with Autism Spectrum Disorder (ASD) who has eating issues
School of Education
• “Dads are there, they are not gone missing.”: The Role and Involvement of Fathers/Dads in the Lives and Education of Children with Special Educational Needs and/or Disabilities (SEN/D) within an Early Intervention (EI) Context
• In Interpretive Phenomenological Approach to Inclusion in Preschool Settings.
• Effectiveness of an overarching peer-mediated Lego® play intervention to decrease anxiety and increase its understanding in aged 4-6 children in school settings
A selection of completed doctoral research projects (2018-2021)
• Underlying mechanisms in Neonatal Immune Metabolic Dysregulation and Brain Injury
CHAMPION: Childhood Assessment of Multi-organ Dysfunction Post Neonatal Encephalopathy
• PROSPER: Paediatric outcomes and serum biomarker panel in acute traumatic brain injury/ concussion to severe traumatic brain injury
• SERENITY: SEveRe Neurological Impairment and children with medical complexity
• Young people's understandings of youth suicide: A qualitative study
• Investigating Clinically Relevant Phenotypes of Neurodevelopmental
• Copy Number Variants in Children and Adults
• Characterisation of innate immune responses in children with Down syndrome
• GENIE project: GEnder and Neonatal Inflammation in prEterm outcomes
153
Doctoral Research . Contents

Current Child Health Doctoral Projects by Centre of Excellence

Neonatal Encephalopathy PhD Training
Network
Name of PhD candidate:
Chelo del Rosario, Neptune PhD Training Network
Supervisor/Principal Investigator:
Professor Elizabeth Nixon (TCD), Professor Jean Quigley (TCD), Professor Eleanor Molloy (TCD)
Completion Year:
2023
Title of PhD Project:
PANDA: Psychological And NeuroDevelopmental Assessment of Neonatal Encephalopathy (TCD)
Name of PhD candidate:
Fiona Quirke, Neptune PhD Training Network Supervisor/Principal Investigator: Professor Declan Devane (NUIG), Professor Eleanor Molloy (TCD), Dr Patricia Healy (NUIG)
Completion Year:
2022
Title of PhD Project:
COHESION: Developing a Core Outcome Set for use in clinical trials, and other studies, for interventions for the treatment of Neonatal Encephalopathy (NUIG )
Name of PhD candidate: Megan Dibble, Neptune PhD Training Network Supervisor/Principal Investigator: Professor Arun Bokde (TCD), Professor Eleanor Molloy (TCD), Professor Elizabeth Nixon (TCD), Professor Declan Devane (NUIG)
Completion Year:
2023
Title of PhD Project:
NEON: Investigate the functional brain changes in neonatal encephalopathy (NE) infants and the associated behavioral and cognitive consequences (TCD)
Name of PhD candidate:
Aoife Branagan, Neptune PhD Training Network
Supervisor/Principal Investigator: Prof Eleanor Molloy
Completion Year:
2024
Title of PhD Project:
PUFFIN: Point of care ultrasound for functional multiorgan evaluation in neonatal encephalopathy
Name of PhD candidate: Tim Hurley, Neptune PhD Training Network
Supervisor/Principal Investigator: Professor Eleanor Molloy (TCD), Professor Geraldine Boylan (UCC), Dr Annie Curtis (RCSI), Ms. Mandy Daly (INHA), Professor Declan Devane (NUIG)
Completion Year:
2023
Title of PhD Project:
CRADLE: Circadian Rhythm Alterations and outcomes in neonatal Encephalopathy
Paediatrics Discipline School of Medicine
Name of PhD candidate:
Dani McCollum, Paediatrics, School of Medicine
Supervisor/Principal Investigator: Prof Eleanor Molloy
Publication Year:
2023
Title of PhD Project:
POLARIS project: Paediatric Traumatic
Name of PhD candidate:
Eman Isweisi, Paediatrics, School of Medicine
Supervisor/Principal Investigator:
Prof Eleanor Molloy
Publication Year:
2022
Title of PhD Project:
FIREFLY project: follow up of inflammatory responses and multiorgan outcomes FoLlowing neonatal brain injury
Name of PhD candidate:
Gergana Semova, Paediatrics, School of Medicine
Supervisor/Principal Investigator:
Prof Eleanor Molloy
Publication Year:
2024
Title of PhD Project:
PLATYPUS: Preterm Inflammatory Hyperreactivity and response to pentoxifylline to understand necrotising enterocolitis and sepsis
Name of PhD candidate:
Niamh Lagan, Paediatrics, School of Medicine
Supervisor/Principal Investigator:
Prof Eleanor Molloy
Publication Year:
2021
Title of PhD Project:
DREAM project: Down syndRome, nEurodevelopment And Multiorgan outcomes
155
Doctoral Research . Current Child Health Doctoral Projects by Centre of Excellence
Name of PhD candidate:
Saima Aslam, Paediatrics, School of Medicine
Supervisor/Principal Investigator:
Prof Eleanor Molloy
Title of PhD Project:
Persistent systemic inflammation in Neonatal Encephalopathy
Name of PhD candidate: Lynne Kelly, Paediatrics, School of Medicine
Supervisor/Principal Investigator:
Prof Eleanor Molloy
Publication Year:
2022
Title of PhD Project: NIMBUS project co-ordinator and GENIE: Gender differences in preterm neonatal outcomes and mechanisms of altered immune function
Name of PhD candidate:
Murwan Omer, Paediatrics, School of Medicine
Supervisor/Principal Investigator:
Prof Eleanor Molloy
Publication Year:
2018
Title of PhD Project:
PRISM: Preterm Infection and Systemic Inflammation and Neonatal Outcomes
Link to Thesis on TARA: http://www.tara.tcd.ie/ handle/2262/82974
Psychiatry Discipline School of Medicine
Name of PhD candidate: Karen Conlan, Psychiatry, School of Medicine
Supervisor/Principal Investigator: Prof Louise Gallagher
Publication Year:
2021
Title of PhD Project: Inflammatory markers of antipsychotic weight gain and cardiometabolic dysfunction in youth mental health disorders
Name of PhD candidate:
Sarah-Marie Feighan, Psychiatry, School of Medicine
Supervisor/Principal Investigator:
Prof Louise Gallagher
Publication Year:
2021
Title of PhD Project:
Influences of social cognition and reward processing on autism symptoms in Prader-Willi Syndrome
Name of PhD candidate: Thomas Dinneen, Psychiatry, School of Medicine
Supervisor/Principal Investigator:
Prof Louise Gallagher
Publication Year:
2022
Title of PhD Project:
The Contribution of Other hits to ND-CNV Carrier
Neurodevelopmental and Neuropsychiatric Phenotypes
Name of PhD candidate:
Alannah Smyth, Psychiatry, School of Medicine
Supervisor/Principal Investigator:
Prof Jane McGrath
Publication Year:
2025
Title of PhD Project:
Predicting who will respond to stimulant medication in ADHD: A precision medicine approach using neurally informed computational models
Name of PhD candidate:
Julia Paterson, Psychiatry, School of Medicine
Supervisor/Principal Investigator:
Prof Jane McGrath
Publication Year:
2025
Title of PhD Project: Towards an understanding of the mechanism of action of methylphenidate in ADHD
Name of PhD candidate:
Michael Connaughton, Psychiatry, School of Medicine
Supervisor/Principal Investigator:
Prof Jane McGrath
Publication Year: 2025
Title of PhD Project:
Longitudinal neuroimaging in children with ADHD
Name of PhD candidate: Tom Farnan, Psychiatry, School of Medicine
Supervisor/Principal Investigator:
Prof Jane McGrath
Publication Year: 2025
Title of PhD Project:
Predicting who will respond to stimulant medication in ADHD: A precision medicine approach using neurally informed computational models
Name of PhD candidate:
Shaakya Vembar, Psychiatry, School of Medicine
Supervisor/Principal Investigator:
Simon McCarthy-Jones (joint with Elizabeth Nixon)
Publication Year: 2023
Title of PhD Project: Shame and Child Sexual Abuse
Clinical Medicine Discipline
Name of PhD candidate:
Maeve McAleer, Clinical Medicine, School of Medicine
Supervisor/Principal Investigator:
Prof Jane McGrath
Publication Year: 2019
Title of PhD Project:
Characterisation of the Epithelial barrier in early life and in atopic dermatitis
Link to Thesis on TARA: http://www.tara.tcd.ie/ handle/2262/86107
156
Doctoral Research . Current Child Health Doctoral Projects by Centre of Excellence
Molecular Rheumatology Discipline
Name of PhD candidate:
Serena Foo, Clinical Medicine, School of Medicine
Supervisor/Principal Investigator:
Prof Ursula Fearon
Publication Year:
2023
Title of PhD Project: Arthritis in Children with Down’s Syndrome is a Distinct and a more Pathogenic Disease Compared to Juvenile Idiopathic Arthritis
Public Health & Primary Care Discipline
Name of PhD candidate:
Dervla Kelly, Public Health & Primary Care, School of Medicine
Supervisor/Principal Investigator: Catherine Hayes (first supervisor) Tom O’Dowd (second supervisor)
Publication Year:
2016
Title of PhD Project: Antibiotic use in early childhood and risk of obesity
Name of PhD candidate: Edgar Lungu, Public Health & Primary Care, School of Medicine
Supervisor/Principal Investigator:
Dr Catherine Darker
Publication Year:
2013
Title of PhD Project:
Child health and survival in urban slums in Malawi: healthcare seeking practices and relative significance of health system factors in influencing care seeking decisions among care givers of under-five children
Link to Thesis on TARA: http://www.tara.tcd.ie/ handle/2262/80298
Immunology Discipline
Name of PhD candidate: Judy Orikiiriza, Immunology, School of Medicine
Supervisor/Principal Investigator: Professor Derek Doherty
Publication Year:
2019
Title of PhD Project:
The role of nutrition as a determinant of clinical, immunological and pharmacological outcome in HIVinfected children in Uganda
Link to Thesis on TARA: http://www.tara.tcd.ie/handle/2262/86876
Name of PhD candidate: Nawal Taher, Paediatrics, School of Medicine
Supervisor/Principal Investigator:
Derek Doherty
Publication Year:
2021
Title of PhD Project: Examining the role of lymphocytes in neonatal brain injury
Therapy Disciplines
Name of PhD candidate: Julia Wall, Physiotherapy, School of Medicine
Supervisor/Principal Investigator: Dr Fiona Wilson
Publication Year:
2019
Title of PhD Project: Back pain in adolescent sport
Name of PhD candidate:
Kieran Lewis, Occupational therapy, School of Medicine
Supervisor/Principal Investigator:
Clodagh Nolan and Elizabeth McKay (Edinburgh)
Publication Year:
2022
Title of PhD Project: An Investigation into the Effectiveness of an occupation focused self management programme for college students experiencing mental health difficulties
Link to Thesis on TARA: http://www.tara.tcd.ie/ handle/2262/98433
Name of PhD candidate: Kim Lombard, Occupational therapy, School of Medicine
Supervisor/Principal Investigator: Dr Clodagh Nolan
Publication Year:
2023
Title of PhD Project: Using Rasch analysis to refine the psychometric properties of the Electronic Trinity Student Profile (eTSP; Nolan, 2011).
Name of PhD candidate: Sara Hope Kift, Occupational therapy, School of Medicine
Supervisor/Principal Investigator: Dr Michelle Spirtos
Publication Year:
2023
Title of PhD Project: The Development of a complex occupational therapy intervention for neonatal units in Ireland
157
Doctoral Research . Current Child Health Doctoral Projects by Centre of Excellence
Name of PhD candidate:
Síomha Walsh García, Occupational therapy, School of Medicine
Supervisor/Principal Investigator: Dr Michelle Spirtos
Publication Year: 2024
Title of PhD Project: An exploration of Occupational Therapy Practice with Children experiencing Complex Trauma
Name of PhD candidate: Heather Curtin, Occupational therapy, School of Medicine
Supervisor/Principal Investigator: Dr Michelle Spirtos
Title of PhD Project: Mobility assistance dogs and the impact on activity levels, gait patterns, balance and quality of life in children with cerebral palsy and neurological impairments
Name of PhD candidate: Emma Butler, Occupational therapy, School of Medicine
Supervisor/Principal Investigator: Dr Michelle Spirtos
Title of PhD Project:
Prenatal predictors across biopsychosocial levels of birth outcomes, sensorimotor development and mental health in childhood
Name of PhD candidate:
Noor Amiera Binti Alias, Occupational therapy, School of Medicine
Supervisor/Principal Investigator: Dr Michelle Spirtos
Title of PhD Project:
The relationship between motor ability and the development of self-care skills in preschool children
Name of PhD candidate: Kim Lombard, Occupational therapy, School of Medicine
Supervisor/Principal Investigator: Dr Clodagh Nolan
Title of PhD Project:
Refining the Psychometric Properties of the Trinity Student Occupational Performance Profile (TSOPP) – A self-report measure of occupational performance difficulties within the student role
Name of PhD candidate:
Susan Ward, Physiotherapy, School of Medicine
Supervisor/Principal Investigator: Dr Sara Dockrell
Publication Year:
2023
Title of PhD Project:
Development of a physiotherapy screening tool for paediatric joint hypermobility: A move towards targeted treatment
Name of PhD candidate:
Tony Rafferty, Physiotherapy, School of Medicine
Supervisor/Principal Investigator:
Dr Sara Dockrell
Publication Year:
2024
Title of PhD Project: A National Adolescent Idiopathic Scoliosis Physical Wellbeing Study
Name of PhD candidate:
Susan Ward, Physiotherapy, School of Medicine
Supervisor/Principal Investigator:
Prof Sara Dockrell
Title of PhD Project:
Development of a physiotherapy decision-making tool for paediatric symptomatic hypermobility: A move towards targeted treatment
Name of PhD candidate:
Rachel Keating, Physiotherapy, School of Medicine
Supervisor/Principal Investigator:
Prof Juliette Hussey
Publication Year:
2025
Title of PhD Project: Cardiorespiratory fitness, physical activity and health-related quality of life in survivors of childhood central nervous system tumours in Ireland
Name of PhD candidate:
Waleed Bin Owais, Physiotherapy, School of Medicine
Supervisor/Principal Investigator:
Prof Juliette Hussey
Title of PhD Project:
An intervention using a Personalised VR Dance Tutor with Progress Monitoring for Survivors of Childhood Cancer
School of Psychology
Name of PhD candidate:
Merve Ataman, School of Psychology
Supervisor/Principal Investigator:
Dr Elizabeth Nixon
Title of PhD Project:
PETIT: Preterm Infant Interaction and Development
Name of PhD candidate:
Desiree Grafton-Clarke, School of Psychology
Supervisor/Principal Investigator:
Dr Elizabeth Nixon
Title of PhD Project:
DIAMOND: Dyadic InterAction in Sown SyndroMe & Outcomes for Neuro-Development
Name of PhD candidate:
Sarah Coughlan, School of Psychology
Supervisor/Principal Investigator:
Dr Elizabeth Nixon
Title of PhD Project:
LEAP: Links between Early parenting and Academic Performance
158
Doctoral Research . Current Child Health Doctoral Projects by Centre of Excellence
School of Nursing & Midwifery
Name of PhD candidate: Fatimah Alsaggaf, School/ Discipline: Nursing and Midwifery
Supervisor/Principal Investigator: Prof Imelda Coyne
Completion Year:
2023
Title of PhD Project: Impact of chronic pain on adolescents’ school functioning: A systematic review
Name of PhD candidate: Albandari Almutairi, School/ Discipline: Nursing and Midwifery
Supervisor/Principal Investigator: Prof Mary Hughes/ Dr Margarita Corry
Completion Year:
2023
Title of PhD Project:
An evaluation of the effectiveness of a child protection programme for health care providers in the detection and reporting of child abuse in a hospital setting
Name of PhD candidate:
Manar Al-Sulimani, School/ Discipline: Nursing and Midwifery
Supervisor/Principal Investigator:
Prof Mary Hughes/ Dr Louise Gallagher
Completion Year:
2024
Title of PhD Project:
Factors That Impact the Continuation of Exclusive Breastfeeding Practice Among Working Mothers in Saudi Arabia
Name of PhD candidate: Emma Cooke, School/ Discipline: Nursing and Midwifery
Supervisor/Principal Investigator:
Prof Maria Brenner/ Prof Valerie Smith/ Dr Colman
Noctor
Completion Year:
2023
Title of PhD Project:
To explore access to respite care for children with an autism spectrum disorder at the acute and primary care interface from the perspective of parents
Name of PhD candidate: Karen Galligan
School/ Discipline:
Nursing and Midwifery
Supervisor/Principal Investigator:
Prof Catherine Comiskey/ Dr Jan De Vries
Publication Year:
2021
Title of PhD Project:
Multi-perspectives of the lived experience of risk and protective factors of children of parental substance misuse: children, parents, grandparents, and service providers
Name of PhD candidate: Katie Hill
School/ Discipline:
Nursing and Midwifery
Supervisor/Principal Investigator:
Prof Maria Brenner/ Prof Catherine McCabe
Completion Year:
2022
Title of PhD Project:
The meaning given to care delivery to children with complex care needs in paediatric intensive care units by physicians and nurses during the coronavirus disease pandemic
Name of PhD candidate: Marie Hyland
School/ Discipline: Nursing and Midwifery
Supervisor/Principal Investigator:
Prof Catherine Comiskey/ Dr Eleanor Hollywood/ Dr Banka Sonam Prakashini
Completion Year:
2022
Title of PhD Project:
Alcohol use, health related quality of life and related harms: Exploring the risk and protective factors for young people living in urban disadvantage
Name of PhD candidate:
Philip James
School/ Discipline:
Nursing and Midwifery
Supervisor/Principal Investigator: Prof Catherine Comiskey
Completion Year:
2027
Title of PhD Project:
Developing an integrated care plan for the treatment of substance use disorders in adolescents
Name of PhD candidate:
Isobel Mahon
School/ Discipline: Nursing and Midwifery
Supervisor/Principal Investigator: Dr Carmel Doyle/ Prof Maria Brenner
Completion Year:
2026
Title of PhD Project:
Evaluating the Experiences, Coping Mechanisms and Supports of Fathers who have a Child with a Rare Chromosomal Abnormality
159
Doctoral Research . Current Child Health Doctoral Projects by Centre of Excellence
Name of PhD candidate: Kate Masterson
School/ Discipline: Nursing and Midwifery
Supervisor/Principal Investigator: Prof Maria Brenner/ Dr Denise Alexander
Completion Year:
2025
Title of PhD Project: The voice of the PICU nurse at the point of initiation of long term ventilation
Name of PhD candidate: Siobhan O’Connor
School/ Discipline: Nursing and Midwifery
Supervisor/Principal Investigator: Prof Imelda Coyne/ Prof Maria Brenner
Completion Year:
2022
Title of PhD Project:
Family-Centred Care for Children and Adolescents in the Acute Hospital Setting
School of Linguistics, Speech and Communication Sciences
Name of PhD candidate: School/Discipline:
Clinical Speech and Language Studies
Supervisor/Principal Investigator: Prof Margaret Walshe
Completion Year:
2017
Title of PhD Project:
Prevalence nature and characteristics of feeding and swallowing disorders in preterm infants admitted to a neonatal intensive care unit in Cyprus over a 3-year period
Name of PhD candidate: Beth Milofsky
School/Discipline: Clinical Speech & Language Studies
Supervisor/Principal Investigator: Dr Irene P. Walsh (co-supervisor Dr Caroline Jagoe)
Completion Year:
2023
Title of PhD Project:
Exploring the phenomenon of ‘diagnosis’ in Ireland: An interpretative phenomenological analysis of the lived experience of mothers whose children have undiagnosed and rare neurodevelopmental disorders
Name of PhD candidate: Anne Marie Clancy
School/Discipline:
Clinical Speech & Language Studies
Supervisor/Principal Investigator: Dr Irene P. Walsh (co-supervisor Dr Julie Regan)
Completion Year:
2027
Title of PhD Project:
An Interpretative Phenomenological Analysis of the daily living experiences of parents parenting a child with Autism Spectrum Disorder (ASD) who has eating issues
School of Education
Name of PhD candidate: Ke Ren (Rita)
School/Discipline:
Education
Supervisor/Principal Investigator: Prof Conor Mc Guckin
Completion Year:
2022
Title of PhD Project:
“Dads are there, they are not gone missing.”: The Role and Involvement of Fathers/Dads in the Lives and Education of Children with Special Educational Needs and/or Disabilities (SEN/D) within an Early Intervention (EI) Context
Name of PhD candidate: Edel Lynn
School/Discipline:
Education
Supervisor/Principal Investigator: Prof Conor McGuckin
Completion Year:
2022
Title of PhD Project: In Interpretive Phenomenological Approach to Inclusion in Preschool Settings
Name of PhD candidate: Stella Wai-Wan Choy School/Discipline:
School of Education
Supervisor/Principal Investigator:
Prof. Conor Mc Guckin and Prof. Miriam Twomey
Completion Year:
2024
Title of PhD Project:
Effectiveness of an overarching peer-mediated Lego® play intervention to decrease anxiety and increase its understanding in aged 4-6 children in school settings
160
Doctoral Research . Current Child Health Doctoral Projects by Centre of Excellence
A Selection of Completed Doctoral Research Projects (2018-2021)
Name of PhD candidate: Mary O Dea, Paediatrics, School of Medicine
Supervisor/Principal Investigator: Prof Eleanor Molloy
Publication Year:
2020
Title of PhD Project:
Underlying mechanisms in Neonatal Immune Metabolic Dysregulation and Brain Injury
Link to Thesis on TARA: http://www.tara.tcd.ie/ handle/2262/92670
Name of PhD candidate: Dr Zunera Zareen, Paediatrics, School of Medicine
Supervisor/Principal Investigator: Prof Eleanor Molloy
Publication Year:
2019
Title of PhD Project: Childhood Assessment of Multi-organ Dysfunction Post Neonatal Encephalopathy (CHAMPION)
Link to Thesis on TARA: http://hdl.handle. net/2262/87268
Name of PhD candidate: Dr Emer Ryan, Paediatrics, School of Medicine
Supervisor/Principal Investigator: Professor Eleanor Molloy
Publication Year:
2020
Title of PhD Project: PROSPER: Paediatric outcomes and serum biomarker panel in acute traumatic brain injury/concussion to severe traumatic brain injury
Link to Thesis on TARA: http://www.tara.tcd.ie/ handle/2262/93475
Name of PhD candidate: John Allen, Paediatrics, School of Medicine
Supervisor/Principal Investigator: Denise Mc Donald and Prof Eleanor Molloy
Publication Year:
2022
Title of PhD Project:
SERENITY Project: SEveRe Neurological Impairment and children with medical complexity
Link to Thesis on TARA: http://www.tara.tcd.ie/ handle/2262/98042
Name of PhD candidate: Melanie Labor, School of Social Work & Social Policy Supervisor/Principal Investigator: Professor Robbie Gilligan, Dr Geraldine Foley (secondary supervisor)
Publication Year: 2020
Title of PhD Project: Young people's understandings of youth suicide: A qualitative study
Link to Thesis on TARA: http://www.tara.tcd.ie/ handle/2262/92445
Name of PhD candidate: Claire Foley, Psychiatry, School of Medicine
Supervisor/Principal Investigator: Prof Louise Gallagher & Prof Aiden Corvin
Publication Year:
2021
Title of PhD Project: Investigating Clinically Relevant Phenotypes of Neurodevelopmental Copy Number Variants in Children and Adults
Link to Thesis on TARA: http://www.tara.tcd.ie/ handle/2262/94979
Name of PhD candidate: Dean Huggard, Paediatrics, School of Medicine
Supervisor/Principal Investigator:
Prof Eleanor Molloy
Publication Year:
2020
Title of PhD Project: Characterisation of innate immune responses in children with Down syndrome
Link to Thesis on TARA: http://www.tara.tcd.ie/ handle/2262/92667
Name of PhD candidate: Matthew Mc Govern, Paediatrics, School of Medicine
Supervisor/Principal Investigator:
Prof Eleanor Molloy
Publication Year:
2021
Title of PhD Project: GENIE project: GEnder and Neonatal Inflammation in prEterm outcomes
Link to Thesis on TARA: http://www.tara.tcd.ie/ handle/2262/96175
161
Doctoral Research . A Selection of Completed Doctoral Research Projects (2018-2021)
Paediatric Research for undergraduate students
Professor Eleanor Molloy and Dr Judith
Meehan,
Department of Paediatrics
Customised undergraduate research module for students completing Paediatrics in their final year of Medicine in Trinity College. It was established in its current format in 2014. The aims of the module are to promote commitment to lifelong learning, quality improvement, research and education in undergraduate students in Paediatrics and Child Health. The Evidence based research project is conducted by students in groups during their Paediatric rotation over an 8-week period. The project titles are devised by the senior academic staff of the discipline and range in subject matter.
PROGRESS - Paediatric Research for undergraduate Students
The principles of each group project are similar:
• Apply the principles of critical appraisal of the literature to guide evidenced based patient care. Demonstrate integration of new learning into practice.
• Understand of the process and importance of quality improvement
• Understand the importance of research in advancing medical care, and the importance of incorporating research into clinical care for patients.
The expected outputs for each group are e Poster, PowerPoint Presentation, Abstract and Paper with summary abstract included.

There is a structured timeframe for projects over 8 weeks where student groups receive project titles, Group discussion with senior academic staff and basic literature review, meetings with group mentors/ academic staff to discuss and review progression of the projects and formulate, presentation to group and academic staff with external examiner to grade and rank. Further guidance is given re future directions of the research.
10 of our student projects have been published in peer reviewed journals and 10-15 are presented annually at national and international scientific meetings. This year one of our students won the 2023 Irish Undergraduate Researcher of the Year at the Student Medical Summit. Many have won poster and oral presentation prizes. This is the longer-term aim for students and serves as an additional motivation to conduct the research.
162
The long term expected impact is to promote commitment to lifelong learning, quality improvement, research and education in undergraduate students in Paediatrics and Child Health.”
“
Doctoral Research . Paediatric Research for undergraduate students . Professor Eleanor Molloy . Dr Judith Meehan
Child Health Research Funding Sponsor Acknowledgement
Abbott Laboratories Ireland limited Arthritis Ireland
Atlantic Philanthropies
Barnardos
Bioverativ, a Sanofi company Breakthrough Cancer Research
Children’s Cancer and Leukaemia Group
Children’s Health Foundation Grants Advisory Panel (GAP)
Children’s Rights Alliance
Children’s Health Ireland (CHI) Temple Street
Children’s Medical and Research Foundation, Crumlin Crohn’s Colitis Foundation
Daughters of Charity Child and Family Service
The Deans Research Initiative Fund, Faculty of Health Sciences, Trinity College Dublin
Dental School internal funding
Department of Children, Equality, Disability, Integration and Youth
Department of Health
Department of Justice
Diabetes Ireland
Doctoral Funding Sponsor Acknowledgements
Dogs for the Disabled Down Syndrome Ireland
Duke Endowment Grant USA
Enterprise Ireland
Enterprise Ireland/Disruptive Technologies Innovation Fund
European Commission
European & Developing Countries Clinical Trials Partnership
European Health and Digital Executive Agency
European Society of Clinical Microbiology and Infectious Diseases;
Genzyme, a Sanofi Company
Gilead Sciences *** (FungiHope) Immunology Doc
GI Bill, USA
Government of Ireland
Grace Kelly Childhood Cancer Trust
Health Research Board
Health Research Board APA 2022
Health Research Board DIFA Award
HRB-TMRN-2
Health Service Executive
HRB SPHeRE PhD programme
Innovative Medicines Initiative;
Irish Cancer Society
Irish Hospice Foundation
Irish Life PLC
Irish Research Council New Foundations
Katie Nugent Fund
LauraLynn Ireland’s Children’s Hospice
Meath Women’s Refuge and Support Services (MWRSS)
National Children’s Hospital
National Children’s Research Centre, Crumlin
NCRC Clinical Research Fellowship
National Children’s Hospital Foundation
National Doctors Training and Planning (HSE)
National Institute of Aging
National Institute for Health and care Research UK (Safe Motherhood)
NMPD Dublin North
Novo Nordisk
Nursing and Midwifery Planning and Development Unit, PedNet Haemophilia Research Foundation
Pharmaceutical Industry; ** Patrick Walsh Immunology doc
Royal College of Occupational Therapists, UK. RCPI.
Royal City of Dublin Hospital Trust
SFI Frontiers for the Future Programme
Science Foundation Ireland
School of Medicine Research Impact Award
Swedish Orphan Biovitrum
Trinity College Foundation Scholarship
TCD MED Research Award
TCD Newman Fellowship programme
TCD Impact award
Internal funding Discipline of Occupational Therapy, Trinity College Dublin
Tusla Child and Family Agency
Occupational Therapy Dept., Universiti Kebangsaan
Malaysia, (Syph_STAT, COCOA) University of Liverpool
The Wellcome Trust
163
Child Health Research Funding Sponsor Acknowledgement
Acknowledgements
Production Team
Professor Eleanor Molloy, Professor of Paediatrics & Child Health, Trinity College Dublin
Ms Bridget Gavin, Research Impact Officer, School of Medicine & Office of the Dean of Research
Dr Johana Isaza-Correa, Research Fellow, Discipline of Paediatrics, Trinity College Dublin
Ms Beth Corcoran, NEPTuNE Programme Manager, Discipline of Paediatrics, Trinity College Dublin
Ms Ciara O’Shea, Media Relations Officer, Public Affairs and Communications, Trinity College Dublin
Dr. Luciana Lolich, Research Impact Officer, School of Nursing & Midwifery, Trinity College Dublin
Ian and Katie at Big Top Multimedia
With special thanks to all those who have generously contributed to the development of this Research Excellence Report of Children’s Health Research in Trinity College Dublin 2023 over the last two years.
Published by:
School of Medicine
Trinity College Dublin
Trinity Biomedical Sciences Institute
152 - 160 Pearse St, Dublin 2
D02 R590, Ireland
Phone: +353 1 896 1000
Email: research.medicine@tcd.ie
Web: www.tcd.ie/medicine/research/
Twitter: @TrinityMed1
April 2023
164
Acknowledgements






























































 Professor Deirdre J Murphy, Chair in Obstetrics, School of Medicine
Professor Deirdre J Murphy, Chair in Obstetrics, School of Medicine
 Professor Valerie Smith, Professor in Midwifery
Professor Valerie Smith, Professor in Midwifery


 Professor Catherine Comiskey, Professor in Healthcare Modelling and Statistics, School of Nursing & Midwifery
Professor Catherine Comiskey, Professor in Healthcare Modelling and Statistics, School of Nursing & Midwifery



 Dr. Katy Tobin, Assistant Professor in Biostatistics, Public Health & Primary Care Assistant Professor in Biostatistics
Dr. Katy Tobin, Assistant Professor in Biostatistics, Public Health & Primary Care Assistant Professor in Biostatistics


 Dr Carmel Doyle, Head of intellectual Disability Nursing, School of Nursing & Midwifery
Dr Carmel Doyle, Head of intellectual Disability Nursing, School of Nursing & Midwifery

 Professor Anne C O’Connell, Head of Paediatric Dentistry, School of Dental Science
Professor Anne C O’Connell, Head of Paediatric Dentistry, School of Dental Science
 Dr Gavin Murphy, School of Education
Dr Gavin Murphy, School of Education


 Dr Michelle Spirtos, Discipline of Occupational Therapy, School of Medicine
Dr Michelle Spirtos, Discipline of Occupational Therapy, School of Medicine





 Dr Sarah Doyle, Associate Professor in Immunology, Clinical Medicine (PI), Dr Kiva Brennan (Senior Research Fellow)
Dr Sarah Doyle, Associate Professor in Immunology, Clinical Medicine (PI), Dr Kiva Brennan (Senior Research Fellow)

Professor John Russell, Paediatric Otolaryngology CHI (Crumlin) & Discipline of Paediatrics
Professor John Russell, Paediatric Otolaryngology CHI (Crumlin) & Discipline of Paediatrics

 Dr Julie Renwick, Assistant Professor, Clinical Microbiology
Dr Julie Renwick, Assistant Professor, Clinical Microbiology

 Dr Alida Fe Talento MD FRCPath FFPath FRCPI Consultant Microbiologist at CHI, Clinical Senior Lecturer, Dept of Clinical Microbiology, Sir Patrick Dun Laboratory
Dr Alida Fe Talento MD FRCPath FFPath FRCPI Consultant Microbiologist at CHI, Clinical Senior Lecturer, Dept of Clinical Microbiology, Sir Patrick Dun Laboratory







 Professor Arun Bokde, Associate Professor Psychiatry
Professor Arun Bokde, Associate Professor Psychiatry
 Professor Jane McGrath,
Professor Jane McGrath,
 Professor Robert Whelan, Associate Professor in Psychology
Professor Robert Whelan, Associate Professor in Psychology
 Professor Robert Whelan and Professor Jane McGrath
Professor Robert Whelan and Professor Jane McGrath

 Professor Fiona Newell, Professor of Experimental Psychology
Professor Fiona Newell, Professor of Experimental Psychology


 Dr. Lorraine Swords, Assistant Professor in Child & Adolescent Psychology
Dr. Lorraine Swords, Assistant Professor in Child & Adolescent Psychology


 Dr. Dónal Wallace, Assistant Professor in General Practice, Institute of Population Health, Public Health
Dr. Dónal Wallace, Assistant Professor in General Practice, Institute of Population Health, Public Health

 Dr. Daniela Tropea, Associate Professor of Psychiatry, School of Medicine
Dr. Daniela Tropea, Associate Professor of Psychiatry, School of Medicine





